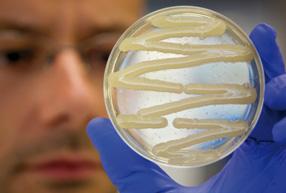

RESEARCH AND INNOVATION CENTRE FONDAZIONE EDMUND MACH

Apple Genome Sequenced Focus : on our research Report 09/10 Whatʼs on Plants for the future / Food for life / A sustainable world / Interactions in living systems / Facts and figures REPORT
2009 2010
Report 09 / 10
Focus on lndex
Index
our world: at a glance
+ Preface
+ Fondazione Edmund Mach
+ The Research and Innovation Centre
+ GMPF & International Doctoral Programme
our research: key subjects
part_1 Plants for the future / Introduction
+ 1.1 Genomics opens up new possibilities for improved apple cultivation
Authors / M. Troggio | S. Salvi | R. Velasco
+ 1.2 Induced systemic resistance: a natural mechanism for plant self-protection
+
Authors / M. Perazzolli | M. C. Palmieri | B. Roatti | I. Pertot
1.3 The hyperparasite Ampelomyces quisqualis recognises the presence of its host fungus
Authors / L. Tosi | D. Angeli | I. Pertot | M. Maurhofer
+ Highlights
part_2 Food for life / Introduction
+ 2.1 New knowledge about the structure of Rubus ellagitannins
+
Author / U. Vrhovsek
2.2 Shedding light on the molecular basis of wine grape quality
Authors / C. Moser | F. Emanuelli | S. Pilati | L. Costantini | J. Battilana | M. S. Grando
+ 2.3 Raspberry volatile compounds: the key to a pleasant flavour and healthier plants
Authors / E. Aprea | S. Carlin | F. Biasioli | F. Gasperi
+ 2.4 A New Method to stop Shark Squalene and Squalane being used in cosmetics
+
Author / F. Camim
2.5 Application of a new method for analysing rotundone discloses the origin of the peppery taste in some wines.
Author / F. Mattivi
+ Highlights
part_3 A sustainable world / Introduction
+ 3.1 Climate change could affect crops and their pathogens
Authors / A. Caffarra | M. Rinaldi | E. Eccel | I. Pertot
+ 3.2 Carbon fluxes and ecological indicators of forest and grassland ecosystems under global change scenarios
+
Authors / D. Gianelle | N. La Porta
3.3 Alpine ecosystems in a changing environment: biodiversity sensitivity and adaptive potential
Authors / C. Vernesi | E. Eccel | N. Salmaso | R. Rosà | N. La Porta | A. Rizzoli | C. Varotto
+ 3.4 Challenges and opportunities in addressing changes in aquatic ecosystems
Authors / N. Salmaso | L. Cerasino | M. Tolotti | B. Maiolini | C. Bruno
+ 3.5 Forests have a long-term cooling effect during heat waves
Authors / D. Gianelle | M. Sottocornola + Highlights
Focus : on Index Report 09 / 10 Index
p. 07 p. 09 p. 10 p. 11 p. 12 p. 13 p. 15 p. 16 p. 18 p. 20 p. 22 p. 25 p. 26 p. 28 p. 30 p. 32 p. 34 p. 36 p. 39 p. 40 p. 42 p. 44 p. 46 p. 48 p. 50
part_4 Interactions in living systems / Introduction
+ 4.1 Investigating the memory of bees
Authors / G. Anfora | E. Rigosi | F. Trona
+ 4.2 Vibrations could replace insecticides for the control of grapevine leafhoppers
Authors / V. Mazzoni | A. Eriksson | G. Anfora
+ 4.3 The role of plant volatiles in insect-plant interactions
+
+
Authors / M. Tasin | C. Sicher | I. Pertot
4.4 Perception, coding and the interaction of pheromone and plant signals in the codling moth Cydia pomonella
Authors / F. Trona | J. Bengtsson | M. Tasin | G. Anfora
4.5 Global change and the emergence of new zoonotic diseases
Authors / A. Rizzoli | H. Hauffe | M. Neteler | R. Rosà | V. Tagliapietra
+ 4.6 A closer look into animalsʼ lives: GPS technology applied to animal ecology
Author / F. Cagnacci
+ Highlights
our research: facts and figures
part_1 Our International Network
part_2 Research Projects
part_3 CRI Events
part_4 Theses completed by FEM
part_5 Awards 09/10
part_6 Editorial Board Memberships
part_7 CRI Publications
part_8 Organization chart
p. 55
p. 56
p. 58 p. 60 p. 62 p. 64 p. 66 p. 68 p. 71 p. 72 p. 80 p. 82 p. 86 p. 90 p. 91
p. 92 p. 116
Focus on Index Report 09 / 10
our world : at a glance Focus on our world: at a glance Report 09 / 10 07
Focus : on Preface Report 09 / 10
I am proud to introduce the first Report of the Research and Innovation Centre (CRI) - Fondazione Edmund Mach (FEM). The CRI was established on 1st January 2009 by integrating the Experimental Centre of the Agricultural Institute of San Michele allʼAdige (IASMA) and the Centre for Alpine Ecology.
The aim of the CRI is to contribute knowledge, ideas and innovation as key drivers in promoting sustainable development of Trentinoʼs land-based economy. As true “glocal” players we recognize that to serve local needs best we need to be fully aware of the global dimension of scientific research and become a significant and competitive player in the international arena. This is why one of the most important actions taken during our first year of operation has been to set up the International PhD Programme in Genomics and Molecular Physiology of Fruit (GMPF), a project which involves the collaboration of more than 17 international institutions distributed over 5 continents.

I invite you to go through the pages of this Report where you will find details of the many activities and research projects in the areas of Agriculture, Food and the Environment that form an integral part of the CRIʼs ambitious research programme. Over 230 people were involved in these projects, working in 6,000 m2 of offices and laboratories equipped with state of the art facilities and 30 hectares of experimental fields, in addition collaborating with universities and research institutions throughout the world.
I am confident you will find reading the report both interesting and informative and if you would like to know more about our research programmes please do not hesitate to get in touch with us.
Roberto
Director of the Research and


 Centre
Centre
Focus on our world: at a glance Preface 09 Preface Report 09 / 10
Viola
Innovation
Francesco SALAMINI President of Fondazione Edmund Mach
Roberto VIOLA Director of the Research and Innovation Centre
Alessandro Carlo DINI
General Director of Fondazione Edmund Mach
Fondazione Edmund Mach
In order to improve agriculture in what was then southern Tyrol, on the 12th January 1874 the Tyrolean Diet in Innsbruck approved the foundation of an agricultural school in the Augustinian monastery of San Michele allʼAdige. The school opened in the autumn of that year with a programme of study written by its first director, Edmund Mach. Mach was an efficient organiser and from the very outset fervently supported the plan to turn the institute into an innovative organisation where teaching and research would contribute together to the improvement of agriculture in the region.
After the First World War, the Istituto Agrario di San Michele allʼAdige (IASMA) was ended to the Italian government which in turn passed it to the Autonomous Province of Trento.

In 1990 Provincial Law no. 28 formalised the transformation of IASMA into a functional agency of the Autonomous Province of Trento, and at the same time integrated technical services into the institute, adding to its original roles of training and research.
On 1st January 2008 the Institute and its activities were amalgamated with an other Provincial research institute (Centre for Alpine Ecology) and given a new name: Fondazione Edmund Mach (FEM) legally defined as a public agency governed by laws (Provincial Law no. 14, of the 2nd August 2005).
The 3 centres that constituted IASMA were inherited by FEM and given a more flexible structure geared to the specific aims of Education and Training, Research and Innovation, and Technology Transfer, which became not just the new names for the centres but also described the most salient aspects of their respective missions.
Focus : on Fondazione Edmund Mach | Research and Innovation Centre Report 09 / 10 10
On the 1st January 2009 FEM Experimental Centre was renamed the “Research and Innovation Centre” (CRI). The former Departments and the Centre for Alpine Ecology were subsequently assigned to specialised research Areas covering the fields of Genomics and Crop Biology, Food, Quality and Nutrition Area and Environment and Natural Resources.
The aim of the Genomics and Crop Biology Area is to contribute to the genetic improvement of cultivated plant species and to develop new varieties with commercial value through research ranging from functional genomics to applied molecular genomics and the study of plant/pathogen interactions.

The Food, Quality and Nutrition Area focuses on qualitative, technological and nutritional evaluation of agri-food products through the study of the potential of cultivated plants, human health, to affect the investigation of the sensory mechanisms of food perception, and development of innovative methods for food traceability.
The Environment and Natural Resources Area tackles highly topical issues such as climate change and the maintenance of biodiversity through basic research and pratical applications with theoretical models integrated with monitoring and field work.
Each Area is divided into Programmes based on research projects and innovative technology platforms in the fields of computational biology, metabolomics, functional genomics, isotopic analyses, climate modelling, and GIS and remote sensing.
Pioneering organisations, a young and dynamic environment, international researchers, collaborations
with universities and institutions throughout the world, and high-level specialised training initiatives: and these place CRI in a global context, encouraging the exchange of ideas, the development of innnovation and internationally-recognised results.
With this strong background, the CRI occupies an authoritative position in knowledge acquistion and in fostering innovation and positive spillover effects for the Region. These are indispensible requisites for stimulating the development of an economy which is increasingly knowldege-based and for supporting long-term, high-quality socio-economic growth.
The Research and Innovation Centre
Report 09 / 10 11
Focus on Fondazione Edmund Mach | Research and Innovation Centre
GMPF & International Doctoral Programme
The International Doctoral Programme is one of the CRIʼs most important initiatives. In fact, the Fondazio-Fondazione Edmund Mach has recently created two doctoral programmes that will characterise its future activities. These will, in addition, benefit from the CRIʼs more than ten years internationally-recognised experience in doctoral fields and a research policy attentive to the expectations of consumers and producers.
The PhD fellowships are advertised internationally and are awarded after a stringent selection procedure. Successful candidates carry out research projects involving at least two of the participating institutions and have access to state-of-the art facilities in these institutions. The outstanding quality of the research organizations involved in the PhD programme will ensure fellows have access to toplevel research training and tuition. Students will also have the opportunity to attend specialized summer courses aimed at keeping their methodological and technological competences up to date.
The International Doctoral Programme in the Genomics and Molecular Physiology of Fruit (GMPF) occupies a prominent position in that it was the first of its kind to be set up: established in 2008, operations began the following summer. It offers highlevel study and research programmes in a context of national and international scientific cooperation between doctoral students and, more generally, between member institutions. The GMPF is the first programme in Italy to offer a high-level programme aimed at training researchers to develop a more sustainable and competitive fructiculture in Europe.
In addition to being located within the CRIʼs, this pioneering programme enjoys the collaboration of 17 institutions from all over the world: from the University of Trento to the Washington State University (USA), from the Plant and Food Research Institute in North Palmerston (New Zealand) to the University of Bologna, from the Plant Research International in Wageningen (The Netherlands) to the University of Stellenbosch (South Africa) and the Hebrew University of Jerusalem (Israel).
GMPF students will complete their study and research programme with an outstanding curriculum in the fields of genomics, information technology, functional genomics, proteomics and metabolomics, genetics, and the genetic improvement and molecular physiology of fruit tree species.
In 2010 the Research and Innovation Centre launched a parallel initiative called International PhD Programme (IPP).
Each year around ten scholarships are awarded for this programme in topics as agrobiosciences, food biosciences, terrestrial and freshwater ecology, climate change mitigation and adaptation, agro-biology and eco-biology.
Focus : on GMPF & International Doctoral Programme 12
www.gmpf.eu
Report 09 / 10
our research : key subjects
part_1 Plants for the future
part_2 Food for life
part_3 A sustainable world
part_4 Interactions in living systems
Focus on our research: key subjects 13 Report 09 / 10
Lorem ipsum legimus nostrum elaboraret ne nec, error omnes pericula ad usu.
Plants for the future
New opportunities for developing more efficient and effective crop systems 1part_
Focus : on part_1 Plants for the future Introduction 14 Report 09 / 10
In the new millennium, the agriculture sector is facing different challenges. On one hand, there is a call for sustainable agriculture, high quality and high prod- uctivity. Yet profits are being eroded by an international economic turndown and global competition is at records level.
One solution is offered by the exponential growth in knowledge in parallel with constant advances in the technologies employed to create and manage this knowledge. The twenty-first century began with the announcement that the human genome had been sequenced, and within a few years similar information was obtained from many organisms, including prokaryotes as well as eukaryotes. So far, more than a dozen plant species, including 4 types of fruit tree, have been sequenced successfully.
Here in Trentino, we have directed much of our focus on application of this knowledge, primarily to stimulate research leading to the genetic improvement of the plants of greatest interest to this Region: grapevine, apple, strawberry and raspberry. Between 2007 and 2010 grapevine, apple and strawberry genomes were
deposited in international databases with a significant input from the platform of FEM. We are now developing a new paradigm in applied research, particularly with respect to these plant. Our basic genetic knowledge is now a sufficient species for drawing up feasible plans for genetic improvement and for producing new genotypes with high added economic value.
Agriculture is experiencing a period of enormous change. Therefore, while agronomy will maintain its importance for crop management, knowledge of plant genomes will help producers and consumers reach to their most pressing goals in the coming years: e.g. plants that can tolerate and resist pathogens, plants that require less intensive interventions, plants that provide a guaranteed income of their quality, originality and high nutritional content of theit produce.
The experience of growers and producers in the field combined with sophisticated agricultural techniques are now supplemented by new choices based on genetic knowledge, such as land and product characterization and management strategies, that respect the environment, inimaginable only a decade ago.
Focus on part_1 Plants for the future Introduction 15 Report 09 / 10
1. 1
Genomics opens up new possibilities for improved apple cultivation

Apple is the most widespread fruit plant species in temperate climates and occupies a predominant position in our Region. The need to know more about the biology of the plant and the possibility of capitalising on the experience gained in grapevine genomics, has led to the decoding of the apple genome, specifically Golden Delicious, one of the worldʻs top three varieties and the most widely cultivated variety in Italy and in Trentino.
With the complete sequence of the Golden Delicious genome, achieved by a consortium of research institutes and universities on three continents, Europe, North America and Oceania, we have attained our primary objective.
17-fold coverage of the genome has enabled us to make an estimate of its size (742.3 megabases). The total sequence consists of about 1,600 scaffolds (chromosome fragments) and covers approximately 603 megabases accounting for over 81% of the genome. Anchoring of 72% of the total was obtained with 1,643 molecular markers (SSRs and SNPs) distributed along the 17 chromosomes, approximately 1,130 cM in length.
Interestingly, analyses of the genome has revealed the extraordinary number of genes, more than 57,000, among the most significant of which are, for example,
total sequence scaffolds (chromosome fragments) of Golden Delicious.
1600 Focus : on part_1 Plants for the future Authors Michela Troggio | Silvio Salvi | Riccardo Velasco 16
Report 09 / 10
This sequencing effort covers approximately 603 megabases or over 81% of the genome.
the transcription factors (over 4,000) and the genes related to pathogen resistance (about 1,000). Over 90% of the latter were assigned to chromosomes and ordered.
The chromosomes that currently make up the genome are the result of a relatively recent duplication (35-50 million years ago) which brought the number of chromosomes in species botanically classifiable as belonging to the tribe Pyreae (apple, but also pear, quince and sorb) from the 7-9 chromosomes normally found in other Rosaceae (strawberry 7; peach, 8; Spireae and Gillenia, 9) to the present day 17.
Phylogenetic analysis of these sequences has allowed us to close a heated debate on the phylogenesis of the Pyreae genome, the current 17 chromosomes of which may be the outcome of an allopolyploidy event (where a genome
of 9, Spireae-related merged with a genome of 8, Prunus-related) or an autopolyploidy event (Gilleniarelated, 9). Our data support the latter theory.
Our data also allowed us to identify the closest wild ancestor of cultivated apple. Portions of the genome of 74 different apple genotypes were resequenced and their nucleotides compared. These analyses showed unequivocally that M sylvestris (European) made an insignificant contribution to the cultivated apple while M. sieversii (Central Asia) is instead virtually indistinguishable from the cultivated apple.
battery of molecular markers to help researchers clarify the genetic basis underlying inheritance of agronomically relevant characteristics and fruit quality traits, leading to faster and more effective genetic improvement of apple varieties.
Producing varieties resistant to fungal, bacterial and phytoplasma pathogens and increasing the nutritional value and health benefits of the fruit, along with important pomological features such greater crispness and keeping qualities, are current objectives in the field of genetic improvement.
Identification
of numerous molecular markers, mostly SNPs (single nucleotide polymorphisms), in the genome of the Golden Delicious cultivar is of fundamental importance. These SNPs (about 3,000,000) will provide an extremely powerful
In order to identify sources of genetic variation which may be useful for genetic improvement, an extensive germplasm collection consisting of more than 1,200 apple cultivars is also being completed.

Focus on part_1 Plants for the future
|
|
17
Authors Michela Troggio
Silvio Salvi
Riccardo Velasco
Report 09 / 10
1 . 2
Induced systemic resistance: a natural mechanism for plant self-protection

Trichoderma-induced
Plants are actively involved in agroecosystem communications and are continuously exposed to biotic and/or abiotic stresses. Therefore plants have developed several processes to protect themselves against pathogens in the course of their evolution. An interesting defence mechanism is induced systemic resistance (ISR). ISR is stimulated by plants coming into contact with certain selected strains of non-pathogenic microorganisms and activates a priming state for an enhanced defence response to pathogens.
Our aim is to characterise the efficacy and the molecular mechanisms of resistance induced in susceptible grapevines against downy mildew in order to further develop new efficient resistance inducers.
Applications of non-pathogenic microorganisms belonging to the Trichoderma genus or of certain natural protein extracts significantly reduced downy mildew symptoms on grapevine leaves.
Focus : on part_1 Plants for the future 18
Authors Michele
|
| Benedetta Roatti | Ilaria Pertot Report 09 / 10
Perazzolli
Maria Cristina Palmieri
resistance is a low cost method to control grapevine downy mildew
Inparticular, preventive treatments with T. harzianum T39 have a level of efficacy comparable to conventional fungicides (copper) under controlled greenhouse conditions.
In addition, systemic disease was also observed to be reduced in untreated leaves of plants treated with T. harzianum T39, suggesting that it activates plant-mediated defence mechanisms.
Inthe absence of pathogen infection, T. harzianum T39 treatments had no effect on plant growth and on leaf chlorophyll content, suggesting that they do not produce phytotoxic effects and that resistance induced by T. harzianum T39 has no evident metabolic costs for grapevine.
Incontrast to the direct defence activated by some chemical inducers, such as benzothiadiazole
(BTH), T. harzianum T39 applications slightly affected defence gene expression in the absence of pathogens. However, defence gene modulation was significantly greater in plants treated with T. harzianum T39 than in control plants after P. viticola infection.
Thus,T. harzianum T39 did not directly activate the plantsʼ resistance mechanisms but rather primed them for enhanced defence capacity after pathogen infection. In the absence of pathogen infection, the energy costs of the priming state were only slightly higher than those of the direct defence processes, as the defence responses are expressed only when they are really needed.
Froman economic point of view, ISR could be a promising method of low-cost disease protection based on the plantʼs natural selfprotection mechanisms.
However, transcriptomic and proteomic characterisation of T. harzianum T39-induced resistance is needed in order to understand the molecular mechanisms and cellular pathways involved in priming activation and to improve grapevine self-protection processes.

part_1
for the future
Focus on
Plants
Authors
Michele Perazzolli |
19
Maria Cristina Palmieri | Benedetta Roatti | Ilaria Pertot
Report 09 / 10
1. 3
The hyperparasite
Ampelomyces quisqualis recognises the presence of its host fungus
Ampelomyces quisqualis is a mycoparasite of Erysiphales (powdery mildews) used as a biocontrol agent against several species of powdery mildew. A. quisqualis senses the presence of the host and germination is specifically activated by the presence of powdery mildew, in particular by water-soluble substance(s) produced by powdery mildew conidia. A. quisqualis then penetrates the host cell wall during the active-parasitization phase with appressorium-like structures, using enzymatic and mechanical mechanisms. Parasitized powdery mildew colonies can continue their radial growth, but they stop sporulating soon after A. quisqualis penetrates their mycelia. In a late stage of mycoparasitism, after gradual degeneration the affected powdery mildew, cells die.
Although the anatomy of this mycoparasitic relationship has been widely investigated, the lack of genetic information on A. quisqualis and the difficulty of studying molecular

Focus : on part_1 Plants for the future Authors Lorenzo Tosi | Dario Angeli | Ilaria Pertot | Monika Maurhofer 20
Report 09 / 10
mechanisms during mycoparasitization have so far limited our understanding of this biological process. In this study, an extensive transcript catalogue of A. quisqualis was built by 454 sequencing of 3ʼ cDNA fragments from a normalised library constructed from pooled RNA samples extracted at different stages of mycoparasitization of powdery mildew.
Thiscatalogue was then used to build an expression microarray that allowed global characterisation of transcriptional changes in A. quisqualis occurring during the first stage of mycoparasitism: conidial germination in the presence of powdery mildew. The expression analysis showed that 1,773 transcripts are regulated during A. quisqualis germination in the presence of the host.
Astriking feature of this transcriptional reprogramming was
the induction of several genes predicted to encode proteins involved in the synthesis of glucanases, chitinases and extracellular proteases.
This suggest that immediately after the host-recognition stage, A. quisqualis undergoes massive transcriptional reprogramming in order to degrade powdery mildew macromolecular constituents that provide carbon skeletons and energy for the synthesis of proteins and other components needed for its development and growth. At the same time, we also performed phenotypic analyses to asses levels of aggressiveness of A. quisqualis strains against different powdery mildew species.

Alarge number of A. quisqualis strains were isolated from different locations, fungal hosts and host plants. The genetic diversity of A. quisqualis isolates was determined by ITS sequencing.
Thirty genetically different A. quisqualis strains were selected and tested for pathogenicity and aggressiveness on different powdery mildew species on plants. Under controlled conditions, all the selected strains reduced the sporulation of powdery mildews, but with different levels of reduction according to strain. Strains can be either highly or weakly aggressive, and their behaviour is similar on different powdery mildew species, which are differentially susceptible to A. quisqualis. The results suggest that there are no adaptations of A. quisqualis to powdery mildew species or to geographical origin.
Focus on part_1 Plants for the future
Lorenzo
|
|
Pertot |
21
Authors
Tosi
Dario Angeli
Ilaria
Monika Maurhofer
Report 09 / 10
The efficacy of Ampelomyces quiqualis can be improved by a better understanding of its mechanism of action
METAFLUX GROUP: THE BIOCHEMISTRY, BIOTECHNOLOGY AND MOLECULAR BIOLOGY OF SOFT FRUITS, APPLE AND GRAPE
In the field of post-genomics our limited understanding of the metabolic pathways underlying the biosynthesis of secondary compounds in plants still impedes molecular breeding strategies, which represent a promising approach to improving various fruit quality traits in the short term. The focus of the MetaFlux group is to bring together metabolomic and genomic data in order to construct plant metabolite pathway networks (gene-to-metabolite), thus directly supporting these breeding programmes. Metabolite flux is therefore of great interest and is essential in metabolic network modelling, where it undergoes enzymatic analysis. These studies will be carried out by measuring the reaction flux(es) corresponding to the gene(s) (and, therefore, their corresponding proteins(s)) and the metabolites identified in specific tissues and/or genotypes.
[Stefan Martens]
NICOTINIC ACID AND/OR NICOTINAMIDE ARE ESSENTIAL GROWTH FACTORS FOR ERWINIA AMYLOVORA
Fire blight, caused by Erwinia amylovora, is often initiated by epiphytic populations that multiply on blossoms. E. amylovora requires nicotinic acid (NiAc) and/or nicotinamide (NiNH2) as essential growth factors. We have recently developed a biocontrol agent (Pseudomonas rhizosphaerae JAN) which degrades NiAc. It is therefore crucial to know the amount of NiAc and NiNH2 on blossoms in order to fine-tune the dosage of the biocontrol agent. The amount of NiAc on pear hypanthia is positively correlated with the altitude of the growing site and is inversely correlated with the sum of the maximum temperatures for the 30 days before blossoming. The sum of NiAc and NiNH2 is about 6 to 23 times higher on pear hypanthia and about 1.2 to 3.5 times higher on apple hypanthia than the amounts of NiAc or NiNH2 needed to support E. amylovora growth.
[Thomas Paternoster, Urska Vrhovsek, Fulvio Mattivi, Ilaria Pertot]
GENE TRANSFER: TECHNICAL VISIONS AND EMOTIONAL PERCEPTIONS

The results of our research exploring the different ways different people ‒ citizens, stakeholders and scientists - perceive the risks associated with gene transfer into plants and genetically modified organisms are reported in the book chapter “Gene Transfer: Technical Visions and Emotional Perceptions”. The chapter is published in the book “Psychology of Risk Perception” (2010), J.G. Lavino & R.B. Neumann (eds), NOVA publisher, which brings together a collection of the latest original research in the field of risk perception in various areas and disciplines.
[Lucia Martinelli]
CHARACTERISATION OF DICER-LIKE PROTEINS INVOLVED IN VIRUS RESISTANCE IN GRAPEVINE
Understanding the RNA silencing mechanisms involved in processing viral transcripts in grapevine is crucial for designing novel strategies for fighting viruses. Accordingly, the goal of our work is to investigate resistance to Grapevine Fanleaf (GFLV) and Grape Leafroll (GLRV) viruses by silencing four Dicer-like proteins (VvDCL1-4) in grape by means of RNA interference (RNAi). Vectors for specifically silencing each VvDCL were introduced via Agrobacterium in ʻBrachettoʼ. Following quantification of DCL gene expression in regenerated trangenic plants, small RNAs derived from GFLV and GLRV will be studied and the hierarchy among VvDCLs in resistance and the ways they process viral transcripts will be determined.
[Marina Cavaiuolo, Lorenza Dalla Costa, Valentino Poletti, Lucia Martinelli, Azeddine
Si-Ammour]
Focus : on part_1 Plants for the future 22
Report 09 / 10 → → → → Highlights
Plants for the future


FIRE BLIGHT IN ROSACEAE
Fire blight, caused by the bacterial pathogen Erwinia amylovora, is the most destructive bacterial disease of rosaceous plants (apples and pears), and in recent years this disease has caused serious economic losses around the world. Although a considerable amount is known about the pathogen, the genetic basis of resistance and susceptibility in apple is still relatively unknown. The aim of our work is to understand the mechanisms of interaction between Erwinia and apple, pear and strawberry plants. To achieve this, we are currently using high throughput RNA sequencing to carry out a transcriptomic analysis of resistant and susceptible plants inoculated with wild type and mutant strains of E.amylovora
[Laura
Righetti, Mickael Malnoy]
APPLE PROLIFERATION RESISTANT ROOTSTOCKS
36 genotypes resistant to Apple Proliferation were selected from a breeding programme with the wild species M. sieboldii, donor of the resistance trait. Strategies such as in vitro screening tests, molecular marker development and screenhouse experiments allow for more rapid selection of resistant plants in the field. The 36 genotypes passed all tests and further transmission trials with latent viruses are currently under way to verify the response of these plants to viruses as well. Field experiments have also been set up to evaluate the agronomic value of these genotypes as alternatives to commercial rootstocks.
[Claudia
Bisognin]
THE MEANING OF ʻRECOMBINANT DNAʼ
ANNUAL MEETING OF THE EUROPEAN PROJECT GRAPEGEN 06
Research institutes and grapevine collections from 17 countries in Europe, the Caucasus and North Africa have been working together since 2007 to characterise and manage grapevine genetic resources. The ultimate objective of the project is to develop an optimised conservation scheme for the Vitis germplasm, involving ex-situ, cryo- and on-farm conservation, to ensure resources are permanently maintained, easily accessible and field-tested in a relevant agricultural context. This network of resources will also provide plant material for use in biotechnological, genomic and breeding research.
[Maria
Stella Grando, Flavia Maia Moreira]
Lucia Martinelliʼs explanation of the meaning of ʻRecombinant DNAʼ with its scientific significance and implications for society, is one of the many entries in the Encyclopedia of Science and Technology Communication (2010). Edited by S. Hornig Priest and published by Sage it is the first encyclopedia devoted to scientific communicators. Each entry contains theoretical material and background on recent controversies as well as key institutional actors and sources, providing useful information for scientific communicators.
[Lucia Martinelli]
Focus on part_1 Plants for the future 23
Report 09 / 10 → → → → Highlights
Lorem ipsum legimus nostrum elaboraret ne nec, error omnes pericula ad usu.
Food for life
Insight into chronic human diseases, for improving health and nutrition 2part_
Focus : on part_2 Food for life Introduction 24 Report 09 / 10
Food for Life was established in 2005 as a European Technology Platform within the VII Framework and is recognised throughout Europe as a key component of a knowledge-based bio-economy. Building on existing strengths in food quality and traceability at FEM, and acknowledging the importance of healthy whole plant foods to the regional economy, “Food for Life” was launched as a distinct research line, under the umbrella of the Food Quality and Nutrition Area. Recent research has clearly shown that diets rich in whole plant foods, especially fruit and vegetables, can protect against a range of chronic human diseases. Bioactive molecules in these foods are thought to be responsible for the beneficial effects on health, and the integrated study of their active metabolites has always been of primary interest in nutrition science. For this reason, the advantages of measuring several metabolites in a single experiment are evident to nutrition scientists. Metabolomics in fact provides nutrition science with a far superior tool, since it allows simultaneous analysis of thousands of known and unknown metabolites to be carried out, which can then be explored in new, data-driven experiments. This technique can provide a very precise characterisation of the effects of a nutrient, a food or a particular diet and is therefore now expected to play a major role in the nutritional sciences. It is uniquely suited to explore the complex relationship between nutrition and metabolism and investi-
gate the role that dietary components play in health and disease. Nutritional metabolomics focuses on the active metabolites associated with the beneficial effects of different diets on human health.
The first direct outcome of nutritional metabolomics will be the discovery of novel biomarkers that will be able not only to highlight changes in health or disease but also to measure the intake of specific nutrients in the short- and long-term. Initial studies have highlighted the fact that many of the metabolites which change in response to dietary intervention or disease states, derive either from complex metabolic processes involving both human metabolic pathways and endogenous commensal microbiota within the intestine, or directly from microbial biotransformation of food. One of Food for Lifeʼs key research goals will be to characterise the metabolic fate of biologically active molecules in healthy foods, especially those which are important to the local economy, e.g. apples, wine, soft fruits.
Food for Life is founded on close collaboration between existing FEM areas of excellence in food metabolite profiling and genomics, and aims to develop new capabilities in human nutrition and nutrigenomics by establishing a technology platform capable of measuring the metabolic fate of biologically-active plant metabolites and their beneficial effects on human health.
Focus on part_2 Food for life Introduction 25 Report 09 / 10 2
Report 09 / 10
2. 1

Raspberry and blackberry represent the highest levels of ellagitannins in the European diet, especially in northern countries.
A state-of-the-art protocol for the characterization of 27 different ellagitannins and ellagic acid conjugates in Rubus.
26
New knowledge about the structure of Rubus ellagitannins Focus : on part_2 Food for life
Author Urska Vrhovsek
Rubus berries - raspberries and blackberries - are a rich source of dietary antioxidants due to their high content of phenolic compounds. Research has focused in particular on their high levels of ellagitannins and ellagic acid conjugates, given the fact that ellagitannins are relatively uncommon in our diet, being found only in a few fruits such as strawberries, pomegranates, muscadine grapes, some nuts, raspberries and blackberries.
Ellagitannins are known to interact with biological systems through the induction of certain physiological effects and display anti-oxidant, antiallergy and anti-hypertensive properties. They are also reported to have antitumoural effects, mainly as chemioprotective agents, and are also the main constituents of herbal remedies
They are present on average at a concentration of 1.3 g/kg in blackberries and raspberries.
prepared from the leaves of these plants. The ellagitannins in Rubus berries and leaves are a complex mixture containing both monomeric and oligomeric tannins.
An accurate structural elucidation and quantification of each ellagitannin in its native form is a prerequisite for subsequent studies concerning their potential impact on human health. However, accuracy is hindered both by the lack of pure standard compounds and by the lack of methods that maintain the compounds in their native form without chemical modification of the structure.
Two major steps forward were accomplished in 2009: i) the isolation, purification and structural characterisation of the standards sanguiin H-6 and lambertianin C for use as external standards, and ii) determination of the chemical structure of 20 novel minor ellagi-ellagi-
tannins and 4 ellagic acid conju- acid gates on the basis of their Q-TOFHDMS and DAD spectra.
The new method allowed us to compare the detailed composition of raspberry and blackberry cultivars, including 27 different structures belonging to the ellagitannin or ellagic acid conjugate classes. The study proved that both raspberries and blackberries contain an average of 1.3 g/kg of ellagic acid compounds, the majority (> 1 g/kg) being ellagitannins and the rest other ellagic acid derivatives.
Lambertianin C and sanguiin H-6 were found to be the major ella-ellagitannins of Rubus berries, together representing 81% (range 73-86%) of total ellagitannins in raspberries and 67% (range 41-83%) in blackberries. This study also demonstrated that lambertianin C is the major ellagitannin in blackberries and sanguiin H-6 the major ellagitannin in raspberries.
Ahigh variation among cultivars of same species was observed. Due to the fact that they are closely related within the Rubus genus, raspberries and blackberries have similar qualitative compositions of ellagitannins.
Despite the generally similar compositions of different Rubus fruits, qualitative and quantitative differences were observed in the patterns of raspberry and blackberry ellagitannins and ellagic acid conjugates.
Quantitative
differences between different raspberry and blackberry cultivars, consistent across growing seasons, were also demonstrated, an important observation for breeders.

Focus on part_2 Food for life
Author Urska
27
Vrhovsek
Report 09 / 10
2. 2
Shedding light on the molecular basis of wine grape quality
Grape berry ripening is a complex process involving the activation of many different metabolic pathways, such as sugar and acid metabolism, secondary metabolism and cell wall metabolism.
Together these processes influence fruit quality and therefore the final market value of the grapes and grape-derived products (mainly wine). Apart from the equally important scientific reasons, this is why at CRI we are working on a better understanding of the processes governing grape berry ripening.

In recent years, we and other international groups have demonstrated that the biochemical changes which occur at the onset of berry ripening (véraison) are accompanied by dramatic changes in gene expression.
It is well-known that hormones such as abscisic acid, ethylene, auxins and brassinosteroids certainly play a key role in the regulation of the ripening process, but the involvement of other signaling molecules, such as reactive oxygen species (ROS), known to play an important role in plant-pathogen interaction, has not yet been determined.
Focus : on part_2 Food for life Authors Claudio Moser | Francesco Emanuelli | Stefania Pilati Laura Costantini | Juri Battilana | Maria Stella Grando 28
Report 09 / 10
We have recently observed ROS accumulation in the berry skin from véraison onwards and we are currently investigating how these molecular species are generated within the cell and the role they play in the berry ripening process.
Grape quality is a quantitative trait as it is governed by multiple genes and is enormously affected by the environment.
Muscat cultivars and some nonmuscat aromatic cultivars exhibit a rather particular aroma, closely related to the accumulation of monoterpenols in the berries, which is greatly appreciated for fresh grape consumption and plays an essential role in high-quality winemaking.
Identification of the genomic regions involved in determining Muscat aroma therefore represents a major contribution to un-
derstanding the genetic control of important traits for grape breeding.
Grape berries contain hundreds of compounds that potentially contribute to the flavour and aroma of wines. Monoterpenes are among the grape components which have been linked to wine volatiles as they undergo no alteration during the fermentation process.

They therefore represent a target trait for enhancing the quality attributes of grapevine products.
Desirable alleles underlying Muscat aroma with a potential application in crop improvement have been identified by our group.
Co-localization of a candidate gene and a major effect metabolic QTL for the content of linalool, nerol and geraniol suggested that 1-deoxy-D-xylulose-5-phosphate synthase plays a role in regulating
metabolic flux through the DOXP/ MEP pathway. Association between the nucleotide sequence variation at VvDXS locus and aromatic phenotypes using a collection of grapevines identified a causal SNP for the Muscat cultivars and distinct mutations unique to muscat-like aromatic clones.
These studies will help in generating efficient molecular markers to be readily applied in breeding programmes and in directing management practices to cope with the changing climatic conditions. New cultivars of wine and table grapes with improved characteristics that meet dynamic industry, market and consumer preferences are envisaged.
This leads to opportunities for new breeding strategies.
Focus on part_2 Food for life
|
Emanuelli |
29
Authors Claudio Moser
Francesco
Stefania Pilati
Report 09 / 10
Grape berry ripening process and the formation of secondary metabolites related to wine quality are heavily controlled at the genetic level.
Raspberry volatile compounds: the key to a pleasant flavour and healthier plants
The volatile profile of Raspberry fruits is very complex; more than 200 different compounds have been described. The presence and concentrations of these volatile compounds are directly related to important sensory-quality traits such as odour and flavour. Since this fruit is mostly destined for the fresh market, these sensory attributes play an important role in consumer acceptance.
Aside from the fundamental features related to sensory acceptance, volatile compounds are also involved in some aspects of plant defence, as highlighted by our investigation. INTERBERRY is a multidisciplinary project with the aim of improving the quality and marketability of soft fruits. As part of this project, the volatile profile of fourteen different raspberry varieties (harvested in the FEM experimental fields) was monitored over two seasons (2006 and 2007) using two headspace techniques: PTR-MS and SPME/GC-MS.
The headspace of commercial berries and fresh juices was also analysed. In the raspberries analysed we identified and

46 volatile compounds were assessed over 2 crop seasons in 14 raspberry cultivars.
Cultivars with higher fruit emissions of terpenes are more resistant to Botrytis cinerea.
Focus : on part_2 Food for life Authors Eugenio Aprea | Silvia Carlin | Franco Biasioli | Flavia Gasper i 30
2. 3
Report 09 / 10
monitored 46 volatile compounds and compared the 14 varieties. The major class of compounds is represented by the monoterpene family with 12 compounds, followed by C13-norisoprenoids with 10.
These two classes cover between 54 and 65 % of the total headspace chromatographic area. Comparison of the two seasons, showed the 2007 samples to have higher emissions of volatile compounds. This observation can be partly explained by the lower environmental temperatures recorded in the experimental fields in 2007.
Eventhough there are considerable differences between the varieties considered, raspberry cultivars can be divided into two main groups: one characterised by higher emissions of monoterpene hydrocarbons and the other by higher emissions of C13-norisoprenoids and terpene alcohols. We are cur-
rently also working on classification models to differentiate individual varieties.
The sensory analysis performed by a trained panel on a subset of five varieties (Heritage, Himbotop, Popiel, Polka and Tulameen), highlighted some differences in odour and flavour attributes that can be partially explained by the volatile organic compound profile. For example, the Tulameen variety, characterised by a higher emission of C6 volatile organic compounds associated with herbaceous sensory notes, was found to have higher scores for herbaceous odour and flavour.
Interesting and promising results indicate that varieties emitting higher amounts of α -pinene, β-phellandrene, p-cymene, 2-heptanol, 4-terpineol, trans-caryophyllene,caryophyllene oxide, β-damascenone and
dehydro-β-ionone are less susceptible to Botrytis cinerea, one of the most significant pathogenic fungi affecting soft fruits during storage.
Amore detailed investigation to assess the direct action of individual volatile compounds or combinations of them is currently under way. Varieties naturally resistant to pathogens are of paramount importance for harvesting and for breeding in order to reduce the release of chemicals into the environment.
Our investigation confirms the importance of volatile profiling within fruit crop breeding programmes in order to obtain more appealing fruits and indicates that the role of naturally emitted volatile compounds against pathogen diseases should be further investigated.

Food for life
|
|
|
i 31
Focus on part_2
Authors Eugenio Aprea
Silvia Carlin
Franco Biasioli
Flavia Gasper
Report 09 / 10
A New method to stop Shark Squalene and Squalane being used in cosmetics

Squalene (C30H50) is mainly used as an adjuvant in vaccines and, once hydrogenated to squalane (C30H56), as an emollient and hydrating agent in cosmetic products.
It is mainly produced from the liver oil of deep-sea sharks, despite the fact that deepwater sharks have an extremely low reproductive rate and many are endangered species. Currently thousands of endangered deep-sea sharks are killed each year purely to supply squalene.
Environmental and ethical concerns about shark fishing have led to the extraction of squalene from vegetable sources, such as olive oil distillates obtained through the physical/chemical refining (de-acidification and/or deodorization) of lamp olive oil. However, squalene yield from olive oil is lower, processing times are longer and production costs are therefore higher.
In 2006 the European Union imposed deep-sea shark fishing limits in the
Focus : on part_2 Food for life Author Federica Camin 32
2.4
Report 09 / 10
The stable isotope ratio of carbon can determine if squalene or squalane used in cosmetics derives from olive oil or from the liver oil of endangered deep-sea sharks.
North-East Atlantic, and since 2008, some important cosmetic firms have declared that they have stopped using shark squalene. Up to now, however, there has been no way that manufacturers could determine whether the squalene or squalane they use comes from sharks or olives. Consequently there is a temptation for oil suppliers to continue exploiting sharks.
In this work we investigate whether the stable isotope ratios 13C /12C and 2H/1H can distinguish olive oil from shark squalene/squalane and detect the presence of shark in olive oil based products.
We tested 13 authentic samples of squalene/squalane from olive oil (from Spain, Italy, France and Turkey) and 15 samples from shark liver oil (from Spain, Portugal, Japan and Korea), representating the production areas of these compounds.
Analyses of 13C /12C and 2H/1H were performed using an Isotope Ratio Mass Spectrometer interfaced to an Elemental Analyser or to a Gas chromatographer/combustion system according to the purity of the samples.

The 13C /12C (expressed as δ13C values) were found to be significantly lower in authentic olive oil squalene/squalane (-28.4‰ ± 0.5‰) than in the shark squalene/ squalane samples (-20.5‰ ± 0.7‰). 2H/1H analysis was not useful for distinguishing the two different origins.
The δ13C analysis could be used as an official method of detecting whether any batch of commercial squalene or squalane or any squalane within a cosmetic formulation has come from shark liver or olive oil.
The proposed method will promote the production of squalene from olive oil and will discourage the illegal fishing of deep-sea sharks and contribute to preserving sharks from extinction.
By
defining δ13C threshold values of -27.4‰ for olive oil squalene/squalane, the addition of shark products can be identified from a minimum of 10%. On the basis of this limit, squalane samples extracted from several cosmetic products were found to have been produced from shark liver oil.
Focus on part_2 Food for life Author Federica Camin 33
Report 09 / 10
Application of a new method for analysing rotundone discloses the origin of the peppery taste of some wines.
The identification of rotundone, a previously unknown sesquiterpene ketone, in 2008 by a team of researchers at AWRI (South Australia) represented an important breakthrough in our understanding of the flavour of white and black pepper, grapes, wine and a number of important spices including marjoram and rosemary. It was indeed surprising that the discovery of what it is that gives pepper its distinctive character was made while investigating the aroma of wine!
Ateam of researchers at FEM in collaboration with scientists at the Universities of Bologna and Milan have succeeded in validating a novel, efficient protocol for synthesising rotundone; starting from a commercially available compound and requiring only two reaction steps in additions an improved, faster method of GC separation with selective quantisation of rotundone was developed using tandem mass-spectrometry in multiple reaction monitoring (MRM) mode with d5-rotundone as internal standard.
The improved protocol provides the desired sensitivity and selectivity for routine analysis of rotundone in both white and red wines.
Effective

Focus : on part_2 Food for life Author
34
Fulvio Mattivi
2. 5
Report 09 / 10
analysis of rotundone at below-threshold levels in red and white wines using solid-phase microextraction gas chromatography/tandem mass spectrometry
The very first application of this method was on some varieties renowned for having a significant and distinctive “peppery” aroma.
Schioppettino is an autochthonous variety from north-east Italy, native to the wine region of the Colli Orientali in Friuli. It has a very strong personality characterised by spicy fragrances, and a refined and elegant taste with a particular flavour of white pepper.
Vespolina is a red grape cultivar autochthonous to the provinces of Novara, Varese and Pavia in Northwest Italy. It is well-known for producing a high-quality, very “peppery” wine, which is either blended with other red varieties such as Nebbiolo, Bonarda and Croatina in the production of DOC and DOCG wines or vinified on its own for the production of dark-red wines with a particularly intense spicy aroma.
The cultivar Gruener Veltliner is considered to be Austriaʼs flagship variety, cultivated in 33% of the countryʼs vineyards as well as in Central Europe and Northern Italy, covering a total of around 24,500 hectares. Gruener Veltliner grapes are used to produce the renowned dry, peppery wines which have a characteristic aroma of stone-fruit.
The levels of rotundone contained in the Schioppettino and Vespolina red wines exceeded the reported sensorial threshold in red wine by a factor of 17-35, and in Gruener Veltliner white wines by a factor of between 4 and 17. These unexpectedly high concentrations explain for the first time the origin of the distinctive peppery aroma of these wines. Further research is ongoing to elucidate the vitienological and genetic factors which control the presence of this impact aroma in grapes and wines. Preliminary results of a large
survey on wines from Italy, Austria and Spain indicate that rotundone is a semi-ubiquitous component of wine aroma, and that a group of autochtonous and old varieties, including Groppello di Revò in Trentino (Italy) and Graciano in Rioja (Spain), are characterised by the presence of this aroma at impact concentrations.

Focus on part_2 Food for life
Author Fulvio
35
Mattivi
Report 09 / 10
HOW TO VERIFY THE AUTHENTICITY OF PARMIGIANO REGGIANO PDO CHEESE
We have applied and validated a statistical model (Canonical Discriminant Analysis) capable of discriminating Parmigiano Reggiano PDO cheese from its three main commercial competitors. The model was built on the basis of several analytical parameters (H, C, N, S stable isotope ratios and Li, P, K, Ca, Fe, Cu, Zn, Se, Rb, Sr, Mo, Cs, Sm, Gd, Dy, Yb, Re, U) which were measured using an Isotopic Ratio Mass Spectrometer and an Inductively Coupled Plasma‒Mass Spectrometer. The model can be used to verify the authenticity of commercial cheeses. It has the potential, therefore, of serving as a suitable tool for detecting mislabelling and for consumer protection. The study was carried out in collaboration with Dr. Roberto Larcher of the Centre for Technology Transfer.
[Federica Camin]
EXPLORING THE TEMPORAL DIMENSION IN FLAVOUR SCIENCE: THE PTR-TOF-MS
Proton Transfer Reaction-Mass Spectrometry (PTR-MS), a direct injection mass spectrometric technique, is capable of fast and highly sensitive monitoring of volatile organic compounds. Initially, this instrument was able to determine the nominal mass of ions and thus little chemical information was made available. To overcome these limitations, coupling PTR-MS with a Time of Flight mass analyser has been recently proposed. FEM has the only PTR-TOF-MS instrument in Italy and it is one of the few in the world. We have achieved our very first applications to agroindustrial problems. Extended mass range, a detection limit in the sub ppt range, good mass accuracy and a temporal resolution of less than 1 second have been demonstrated.

[Franco
Biasioli]
NOVEL FRESH JUICES BASED ON BERRY FRUITS: SENSORY TESTS AND METHODOLOGICAL ADVANCES

Acceptability tests carried out by a consumer panel have been proposed in order to support the development of innovative fresh juices designed to exploit the sensory characteristics and nutritional benefits of berry fruits and to meet the needs of modern consumers who are increasingly buying “ready to eat” products to save time without abandoning a healthy diet.
A new statistical method for consumer segmentation has been developed, the proposed method which takes into account preference data, information about consumers, and the physical, chemical and/or sensory properties of products, in order to obtain homogeneous clusters in terms of all the aforementioned parameters.
[Isabella Endrizzi , Flavia Gasperi]
Focus : on part_2 Food for life 36
Report 09 / 10 → → → Highlights
Food for life
NEW TECHNOLOGIES FOR MS IMAGING: MAPPING THE DISTRIBUTION OF METABOLITES IN TISSUES
MS Imaging techniques allow the acquisition of “molecular snapshots” to directly map the distribution of metabolites in biological tissues using position-sensitive ionization methods such as Laser Desorption Ionization (LDI) and Desorption Electrospray Ionization (DESI). This ambitious undertaking will be pursued with the new equipment installed at the metabolomic profiling platform. Metabolic Images will increase our understanding of plant metabolism, the technique having potential applications in food quality, nutrition and plant-pathogen interaction.
[Pietro Franceschi]
INNOVATION IN LOCAL DAIRY PRODUCTION
The researchers of the Food Quality and Nutrition Area are helping the Consortium of Trentino Dairy Producers to optimise the production chain of Grana Trentino cheese, the main local dairy product. The project, funded by local Government, is developing a quality control system based on innovative methods of analysis, and studying the effects on cheese quality of more rational and economically advantageous conditions for milk storage before cheese making. On the basis of our results, the Consortium is implementing a plan to introduce innovative measures to raise standards of quality while maintaining local characteristics.
[Flavia Gasperi, Agostino Cavazza]
RESVERATROL: NOT JUST A DEFENCE MOLECULE
Resveratrol has proved to be a promising molecule for both human and plant health. It confers protection against cardiovascular diseases and cancer and is an antifungal agent in plants which synthesize it, such as grapevine. We have recently demonstrated that constitutive accumulation of resveratrol also occurs in healthy grapes during ripening in a cultivar-dependent manner.
We have also been able to obtain substantial production of resveratrol in cell cultures elicited with cyclodextrins. These sugar molecules induce defence mechanisms in plants largely resembling those following pathogen attack.


[Claudio
Moser]
→
Focus on part_2 Food for life 37
Report 09 / 10 → → Highlights
Lorem ipsum legimus nostrum elaboraret ne
nec, error omnes pericula ad usu. A sustainable world
Living with Global Change in the Alps 3part_
Focus : on part_3 A sustainable world Introduction 38 Report 09 / 10
Mountains and uplands form a fragile patchwork of ecosystems, cultures and economies, which are currently subject to a variety of changes across the globe.
These regions are rich in environmental diversity and are particularly vulnerable to any change in existing conditions. Global warming is already evident in the huge reductions in glacier volume, and the tourism sector is facing the threat of a reduction in snowfall and, consequently, the appeal of these areas in the winter season. Precipitation has decreased on average in the Alps, particularly in winter, and in Trentino, it has fallen by as much as one third in the last 50 years. However, figures attributed to climate change oversimplify a situation that is changing in an irregular and asymmetrical way.
In general, the Alpine-Mediterranean area and the whole European region underwent a notable temperature increase at the end of the 1980s, which was largely responsible for the higher average temperatures we see now with respect to the previous period. There is a general global tendency towards a greater number of extreme events resulting in more frequent periods of drought, which are in turn exacerbated by increased warming. As far as the human population is concerned, emigration has led to depopulation and a negative trend in the natural balance.
In fact, many Alpine communities have lost half of their population over a single century. The trend is not homogeneous: the overall population of the region has risen by up to 13 million, with cluster effects of concentration and abandonment. However, lack of human resources in certain areas has resulted in a progressive loss of certain features of traditional culture and methods of management activities and natural resources in the mountains. The focus on urbanisation has disrupted an equilibrium which had been in place for centuries and has negatively effected the benefits gained in the past. More recently, the entrance of new countries within the EU has driven traditional production in the Alps (timber, foods) and new sources of income (tourism) into a marginal position within the world market.
The mountainsʼ natural and human elements should be considered as a collective resource to be managed in a way that encompasses community values. This position has been widely embraced in scientific circles and has recently been recognised with the Nobel Prize awarded to Elinor Ostrom. It is a view that has also been adopted by the CRI, where the dynamics of forest and aquatic ecosystems, the responses of the components of biodiversity to new land uses, and topical issues relating to health and greenhouse gas fluxes are being investigated.
Focus on part_3 A sustainable world Introduction 39 Report 09 / 10 3
Climate change could affect crops and their pathogens
The development of plant diseases depends on the interaction between host, pathogen, microbial antagonists and environment. Alterations to any of these factors can bring about changes in the progression of an epidemic. The expected climate warming in future decades will accelerate the development of some types of insects, possibly resulting in more generations/year.
On the other hand, crops are also affected by climate and respond to fluctuations in it during their phenological development (growth, flowering, fruit development) with changes in their quality and productivity.
Temperature is the main variable driving the rate of phenological development, length of growing season and vulnerability to pathogen attacks. Thus, in order to evaluate the potential impacts of climate change on agriculture, crop phenological models need to be integrated with pathogen models and their interaction taken into account.

Focus : on part_3 A sustainable world Authors Amelia Caffarra | Monica Rinaldi | Emanuele Eccel | Ilaria Perto t 40
3. 1
Report 09 / 10
A GIS integrated system enables the analysis of plant - pathogen interactions, described by ecological models for key crops, and simulates how they might be impacted by climate change
Themain aim of the ENVIROCHANGE project is to provide tools and information to understand the vulnerability to climate change and to evaluate suitable options for adaptation. The envisaged modification of Trentinoʼs agro-ecosystems following climate change will be precisely investigated through the development of an integrated ecological model/GIS analysis tool (ENVIRO) in order to study plant/pathogen interactions for important crops in Trentino.
During 2009 we monitored the phenology of grapevine through extensive field surveys with the aim of refining existing phenological models of this crop. While current phenological models of crops only take into account phenophases useful for planning agricultural practices (such as flowering and ripening), in order to evaluate potential changes to the risk of attack by pests and dis-

eases, “vulnerable” phenophases also need to be considered.
Data
were collected from five important grapevine varieties for Trentino viticulture, comprising three white (Chardonnay, Pinot gris and Sauvignon blanc) and two black varieties (Pinot noir and Merlot), and these were used to refine the FENOVITIS model (originally developed for the simulation of budburst, flowering and veraison) .
The model was extended by calibrating and integrating two new phenological phases into it, that define the vulnerability window to Botrytis cinerea and Erysiphe necator. Existing disease risk models for B. cinerea, E. necator and Plasmopara viticola and the Lobesia botrana development model were validated with data from Trentino.
In the immediate future we plan to integrate phenological models
with pathogen models and evaluate the potential impacts of climate change on the risk of infection/attack.
We will do this by applying combined models to high resolution (200 m) climate change scenarios. This will ultimately support the development of long- and short-term adaptation policies.
on part_3 A sustainable world
Focus
|
41
Authors Amelia Caffarra | Monica Rinaldi
Emanuele Eccel | Ilaria Perto t
Report 09 / 10
3. 2
Carbon fluxes and ecological indicators of forest and grassland ecosystems under global change scenarios
Climate change is expected to increase the frequency of forest wildfires and alter species composition and biodiversity, in turn influencing carbon pools in natural ecosystems. Estimation of carbon sequestration using microclimate measuring techniques, large-scale inventories or remote sensing has become important owing to the link between climate change and the accumulation of GHGs in the atmosphere.
Remote sensing in combination with microclimate measuring techniques has allowed us to measure some important biophysical parameters (BP) in a mountain grassland site.
We found that it was possible to predict BP using vegetation indices such as NDVI and Green-NDVI.
The best results have been obtained with simulated MODIS and Hyperion band sensors and they indicate that narrow bands have an advantage in predicting BP.
Remote sensing can be also used to predict fire risk. We used a regression analysis to calculate three important biophysical

Focus : on part_3 A sustainable world Authors Damiano Gianelle | Nicola La Porta 42
Report 09 / 10
Forest dynamics has become an important global issue.
In Trentino research is focussed on investigating climate-related issues.
parameters involved in fire risk prediction (water content, leaf area index and green ratio) and from these we obtained a fire risk map for the Bosco della Fontana grassland areas. The extreme spatial variability in fire risk confirmed the importance of obtaining scaleappropriate biophysical maps to model fire risk.
The effect that climate change has in modifying species composition and frequency has also been assessed through aerobiological monitoring and analysis of pollen samples. Important advances have been made regarding this biological indicator with innovative detection methods such as Fourier transformed infrared micro-spectroscopy and molecular Real-Time PCR, which allow rapid and efficient detection and quantification of pollen grains and also have useful applications in studies on pollen allergy.
Tree rings are a highly informative biological indicator and play an important role as environmental archives. A successful study has been carried out using Synchrotron X-ray to detect Sulphur fixation in the tree rings of Picea abies and Abies alba in Trentino. The analyses demonstrate that S concentrations were higher in the second half of the 20th century, consistent with the trend observed with stalagmites in a nearby location.
Anotherinteresting study on ecological indicators regarded the behaviour of Cupressus sempervirens at the northernmost edge of its distribution, where it is under constant stress due to continuous increase in the species despite the climatic constraints imposed by low winter temperatures. A non-native species, the cypress has adapted to new environments and, therefore, can provide important insights into the ability of for-
ests to cope with potential future climate change scenarios.
To throw light on this, the first large-scale genetic study on this species has been carried out and involved analysis of the dynamics and possible routes along which cypress has been introduced over recent millennia.

Focus on part_3 A sustainable world
|
43
Authors Damiano Gianelle
Nicola La Porta
Report 09 / 10
3. 3
Alpine ecosystems in a changing environment: biodiversity sensitivity and adaptive potential
Mountain ecosystems are characterized by their high richness in terms of wild plant and animal species, and variety of ecological niches and microenvironmental conditions. These unique features and their complex topography, which has largely prevented them from being altered by human activity, make mountain ecosystems a unique open-air laboratory for studying how natural plant and animal species and communities are able to survive in highly variable climatic conditions and an invaluable system for studying past, contemporary and future adaptive processes.
With the advent of molecular techniques it has become possible to identify the genes responsible for the strategies employed by plants and animals in coping with environmental stresses and to model the ability of various species to face ongoing global changes in land-use and climate.
In its first year of operation, ACE-SAP (Alpine Ecosystems in a Changing Environment: Biodiversity Sensitivity and Adaptive Potential), a project funded by the Autonomous

Focus : on part_3 A sustainable world Authors Cristiano Vernesi | Emanuele Eccel | Nico Salmaso | Roberto Ros à Nicola La Porta | Annapaola Rizzoli | Claudio Varotto 44
Report 09 / 10
Province of Trento and coordinated by CRI in collaboration with the Natural History Museum of Trento and Museo Civico di Rovereto and the University of Davis (California, USA) was focussed particular attention on laying the foundations for understanding adaptive mechanisms in the natural environments of this region by isolating and characterising the genes with putative relevance for adaptation and responsible for genetic variation in the species selected.
The most significant results obtained at CRI in this first year come from various species. Studies carried out on selected strains of Planktothrix rubescens, isolated from natural populations living in the deep southern subalpine lakes, have provided important information on the potential of this species to form nuisance algal blooms and its effects on freshwater quality.
Useful information for forestry management has already been obtained from studying the standing adaptive genetic diversity in five alpine conifers. Patterns of genetic diversity and differentiation, useful for implementing management strategies, have been identified in several representative animal species in mountain ecosystems, such as rock ptarmigan, viviparous lizard and the endemic Salmo carpio of Lake Garda.
In addition, identification of the genes under selection for elevation adaptation in Brassicaceae using next generation sequencing holds the promise of modelling, in association with environmental variables, the adaptive potential of orophyte species.
Particular attention was focused on the retrieval, checking and homogenisation of climatic series in Trentino.
The homogenisation trial led to the selection of long, regular series with a restricted scattering of the climatic signal over the last 50 years. Other results concern the temporal responses of endangered galliform species in Trentino to various stressors, such as parasitism and climate change.
It has been suggested that helminth parasites may be a significant stressor for galliform populations in Trentino. A model was implemented that included seasonality effects on the dynamics of host-parasite interactions to address the effect of climate on parasite life cycles and the consequent impact on host dynamics.

Focus on part_3 A sustainable world Authors Cristiano Vernesi | Emanuele Eccel | Nico Salmaso | Roberto Ros à Nicola La Porta | Annapaola Rizzoli | Claudio Varotto 45
Report 09 / 10
The ACE-SAP project aims at understanding the molecular and ecological mechanisms underlying the generation and maintenance of the Trentinoʼs rich biodiversity in order to mitigate the effects of global change.
3.4
Challenges and opportunities in addressing changes in aquatic ecosystems
The vitality, health and high biodiversity of Alpine and subalpine regions rely on widespread availability of freshwater resources. The natural conditions of aquatic ecosystems in these regions has been and continues to be severely affected by significant changes due to eutrophication, climate change and water exploitation.
Comparative analyses carried out at the Lake Garda Limnological Station and in the other deep lakes south of the Alps has allowed the effects of long-term eu- and oligotrophication and, in particular, the general increase in cyanobacteria and water blooms following the increase in nutrient loads. Cyanobacteria are nuisance species which produce toxic compounds (cyanotoxins). To deal with these changes, new research lines will study the spectrum of toxins produced by cyanobacteria, their seasonal dynamics and distributions, ecological control mechanisms, and their effects and fate in trophic webs.
The IPCCʼs climate scenarios depict an increase in air temperatures and changes in

Focus : on part_3 A sustainable world Authors Nico Salmaso | Leonardo Cerasino | Monica Tolotti | Bruno Maiolini | Cristina Bruno 46
Report 09 / 10
the seasonality of precipitation in the Alpine regions. Increases in water temperatures of between 0.1 to 0.2 °C/decade have been detected in the deep lakes at the northern and southern borders of the Alps. To understand the interplay between climatic and trophic factors, research activities will examine the historical changes documented by planktonic fossil remains in sediments, the effects of climate change on the development of harmful algal blooms, and the physiological ecology of planktonic species in representative mountain lakes (Lake Tovel).
Mostrivers in the Alpine regions have been managed for flood defence and a variety of uses and consequently their hydrological and thermal regimes severely altered, resulting in water flowing faster in narrow channels. These processes have had particularly severe effects in lowland areas.
Freshwater biodiversity has greatly suffered and the first cause of this decline has been recognised as habitat loss or degradation.
The reduced length and faster flow of running waters and diminished wetlands has also impacted groundwater habitats due to lower recharge, resulting in a general reduction in denitrification, organic matter cycles, and microbial metabolism.
Given this complex scenario, a multidisciplinary approach is paramount. A particular topic addressed is hydropower production and, more specifically, hydropeaking, which occurs at the end of the production process, downstream of power plants. The Slow Water project aims at re-using excess water in downstream stretches of pulsating and fast flowing rivers to restore residual wetlands or existing artificial waterways such as ditch systems in agricultural areas.
Alterations in pristine freshwater ecosystems represent a challenge for researchers, resource managers and decision makers. At the same time, they represent a crucial opportunity to bring together ecological principles and aquatic resource use in a framework where the sustainable exploitation of water resources based on sound management decisions is a priority.

on part_3 A sustainable world
Focus
Authors
Nico Salmaso |
Leonardo Cerasino |
Monica Tolotti | Bruno Maiolini |
47
Cristina Bruno
Report 09 / 10
The vitality and biodiversity of alpine and subalpine regions depends on sustainable exploitation of water resources based on knowledge and correct management.
Forests have a long-term cooling effect during heat waves
During heat waves, forests initially cause surrounding air temperatures to raise. However, in the longer term they have a cooling effect. These results will be used to improve climate modelling.

In Central and Western Europe climate change is expected to make summers drier, which means that heat waves are likely to become more severe and occur more frequently in the future.
Researchers at FEM in collaboration with the FLUXNET project, investigated how soils in forests and grasslands contributed to temperature during the European heat waves of 2003 and 2006 compared with more typical summer conditions.
We used satellite data on land surface temperature in combination with data from towers built over forests and grasslands located across Central and Western Europe.
These towers measure, among other things, the exchange of heat between forests and grasslands, and the atmosphere. Changes in heat transfer during a heat wave are strongly influenced by soil of moisture and this is affected by the type of land cover.
An extensive network of measurements across Europe reveals the impact of different vegetation cover on temperature extremes during heat-waves.
Focus : on part_3 A sustainable world Authors Damiano Gianelle | Matteo Sottocornola 48
3.5
Report 09 / 10
At the start of a heatwave we found that mean surface heating above forests is twice that above grasslands. In the 2006 heat wave, for example, forests were hotspots of heat, the atmosphere above them being heated at a rate up to four times greater than over grasslands.
Inadditction, we found that grasslands and croplands were more efficient at cooling surface temperatures at the beginning of a heat wave because the heat accelerated evaporation of soil moisture.
However, once soil moisture was reduced, and if there was no rain, temperatures above grasslands rose rapidly over a period of one week. This process is thought to have occurred in the later stages of the August 2003 heat wave in France.
In contrast, our results showed forest cover conserved water.
Leaf stomata (pores) close in response to hot and dry air, reducing the rate at which water is evaporated from the plants. In addition, tree roots are typically 25 per cent deeper than grass or crop roots.
These two factors allow trees to evaporate soil moisture over extended periods of time. During the height of the 2003 heat wave, for example, the temperature over forests in some regions was 3.5°C cooler with respect to the long-term average than over grasslands.
Therefore, over the longer term forests had a more moderating effect on heat waves than grasslands or croplands.
In the 2003 heat wave, the highest temperatures in France (over 40°C) were reached in August after an already hot and dry summer, when soil moisture levels had
been depleted. In comparison, the heat wave of July 2006 lasted for a shorter time and soil moisture levels were not depleted to the same extent as in August 2003.

Focus on part_3 A sustainable world
|
49
Authors Damiano Gianelle
Matteo Sottocornola
Report 09 / 10
USE OF δ18O IN THE INTERPRETATION OF HYDROLOGICAL DYNAMICS IN LAKES
This study examined multi-year δ 18 O depth profiles from six lakes in the Italian Alps (Caldonazzo, Levico, Lavarone, Santo di Cembra, Serraia and Tovel) with different hydrological regimes (> or <1 year renewal time) and sizes (> or <50 ha). Differences in isotope composition along the water column, and between years and layers were used to provide innovative insights into the extent of lake water renewal, mixis, stratification, and groundwater infiltration. On the basis of our data, we have drawn up a general schema of the seasonal δ 18 O pattern in temperate lakes, distinguishing small from large lakes.
[Federica
Camin, Giovanna Flaim]
A METAGENOMIC APPROACH TO UNRAVELLING MICROBIAL DIVERSITY ASSOCIATED WITH THE IXODES RICINUS TICK.
Assessing the microbes residing in arthropod vectors of medical importance in a single assay is a crucial but challenging task, because of the difficulties in cultivating and cloning selected microorganisms. Recently, the advent of next-generation sequencing technologies combined with bioinformatic tools has provided opportunities for an innovative approach, known as metagenomic analysis, with which to investigate directly and simultaneously the microbial diversity in samples from different ecological niches.
In collaboration with Professor Stephan Schuster of the Pennsylvania State University, a metagenomic analysis has been used to assess the taxonomic diversity of the microbial content of an important human disease vector, the I. ricinus tick. Our findings show a wide diversity of bacterial communities associated with I. ricinus, including well-known tickborne pathogens, endosymbionts, and other microorganisms not previously described.
[Giovanna Carpi]
SOIL CARBON DYNAMICS
The book Soil Carbon Dynamics (an integrated methodology) summarises the work carried out by leading scientists during an ESF Summer School (European Science Foundation) held at the former Centre for Alpine Ecology in 2004. Besides giving an overview of current research developments and outlooks with respect to the soil carbon cycle, the book presents cutting-edge methodologies ranging from appropriate measurement design to the potential application of stable isotopes and molecular tools.
Chapter 4 deals with the calculation of carbon stocks and variations, a topic that has important implications for the global carbon cycle and for climate change policies.
[Mirco Rodeghiero]
OZONE INJURY ON THE NATIVE SPECIES VIBURNUM LANTANA L.
Information derived both by studying ozone effects on plants under controlled experimental conditions and by bio-monitoring using ozone-sensitive plants introduced adhoc is not always useful for interpreting the responses of actual vegetation in the field.

To bridge this gap, we studied a widelydistributed, native species (Viburnum lantana) whose response specificity to ozone has previously been experimentally demonstrated. Results show a higher frequency, earlier date of onset and faster development of symptoms at the sites with the highest ozone levels. The aim of the study is to discover whether V. lantana can be useful in evaluating the impact of ozone on the native vegetation under real field conditions.
[Elena Gottardini, Fabiana Cristofolini, Antonella Cristofori]
Focus : on part_3 A sustainable world 50
Report 09 / 10 → → → → Highlights
HARVASSIST: A NEW WEBSITE FOR THE CHARACTERISATION OF VINEYARDS AND THE MANAGEMENT OF GRAPE QUALITY
The HarvAssist website, created by Roberto Zorer, Luca Delucchi (CRI), Roberto Larcher and Giorgio Nicolini (FEM Centre for Technology Transfer) in collaboration with Cavit s.c., aims to assist winemakers in choosing the best time to harvest their grapes and to study the “terroir”. Developed using only open-source software, the portal is based on a geospatial database developed in collaboration with CNR-Ibimet of Florence and is a simple web interface for managing and displaying the data. In addition, a webGIS application allows the vineyards to be viewed on maps and the main chemicalanalytical data to be retrieved, while the ripening model application based on bioclimatic indices provides projections of the ideal harvest time.
[Roberto Zorer, Luca Delucchi]
http://harvassist.fmach.it
SHARING DATA FOR BETTER SCIENCE: THE CASE OF THE EURODEER SOFTWARE PLATFORM
EURODEER is a collaborative project, developed and coordinated by FEM, for sharing and integrating spatial data of individually marked animals (roe deer marked with GPS or VHF collars). After being presented at the European Roe Deer Conference in Edinburgh in July 2009, all major groups working on the spatial ecology of this ungulate successfully joined the project. In 2009, data from 12 study areas in 10 countries, for a total of 300 individuals and 700,000 locations were collated. The spatial database is available on the FEM server, thanks to the cooperation of the IT group.
[Francesca Cagnacci]
A sustainable world
ECOSYSTEMS AND SOCIETY
Did you know that every year Trentino ecosystems provide each and every inhabitant with “services” worth about €6,000? Freshwater supplies, flood prevention, recreational facilities and pollination services are just some of the “ecosystem services” for which an interdisciplinary research project has made cost-estimates. The aim is not to put these services on the market but rather to raise awareness and appreciation of the benefits that human, plant and animal communities obtain from natural ecosystems. Quality of life and economic development in our region both depend upon these “services”. The ultimate objective in considering them in monetary terms, i.e. in a common unit of measurement, is to integrate them into decisionmaking processes in the planning and management of the region and its natural resources. This initiative, launched by FEM in collaboration with the Universities of Salento and Urbino, also aims to assess the trends in ecosystem services in Italy since 1990.
 [Rocco Scolozzi]
[Rocco Scolozzi]
COMMUNITY AND ENVIRONMENT: ADAPTATION IN PROGRESS
In an era characterised by widespread change, understanding the interactions between natural and human systems is an urgent issue. Knowledge of the dynamics that have shaped the landscape, societyʼs values and economic activities can reveal the extent to which natural and human systems are inter-connected. This challenge is especially crucial for mountain territories and particularly for the Dolomites, which have recently been declared a “World Heritage Site” by UNESCO. A workshop financed by the provincial authority as part of the OPENLOC project was organised in July 2009, where international experts discussed these issues with local researchers and stakeholders.
[Alessandro Gretter]
http://www.eurodeer.org
http://www.openloc.eu
Focus on part_3 A sustainable world 51
Report 09 / 10 → → → → Highlights
GHG-EUROPE: GREENHOUSE GAS MANAGEMENT IN EUROPEAN LAND USE SYSTEMS
The GHG-Europe project aims to improve our understanding of and ability to predict European terrestrial carbon and greenhouse gas (GHG) budget using a systematic, comprehensive and integrated approach. GHGEurope quantifies the annual to decadal variability of the carbon and GHG budgets of the terrestrial ecosystems of EU27 plus Switzerland and of six data-rich European regions using data-model integration, and diagnostic and predictive modelling. The future vulnerability of carbon pools and risks of positive feedbacks in the climate-carbon system are assessed by scenario analyses using biophysical models and by integrating feedbacks with socio-economic changes and EU climate and land use policies.
[Damiano Gianelle]
POPULATION GENETICS FOR ANIMAL CONSERVATION

In May 2009, the book PopulationGeneticsfor Animal Conservation (edited by G. Bertorelle, University of Ferrara, M.W. Bruford, University of Cardiff, and three researchers from FEM: H.C. Hauffe, A. Rizzoli, C. Vernesi) was published in the prestigious Conservation Biology Series of Cambridge University Press, UK.
The aim of this book was to make the results of an international conference on Conservation Genetics (organized by FEM researchers) accessible to students, researchers and managers of natural resources. This volume combines an analytical approach with practical problems associated with using conservation genetics. In 15 chapters written by 30 international experts, this book provides an exhaustive summary of the state-of-theart in conservation genetics and underlines the potential and usefulness of a close collaboration between population genetics and conservation biology.
[Cristiano Vernesi, Heidi C. Hauffe]
→
SUPPORTING LAKE GOVERNANCE TO MITIGATE THE IMPACT OF CLIMATE CHANGE
The project EULAKES was presented in 2009 in the context of the Central Europe Programme and came into operation at the beginning of 2010. The projectʼs aim is to foster a new, integrated approach directed at improving sustainable management of the Central European lakes. Its activities are carried out by several research and government institutions in Italy, Austria, Hungary and Poland. The CRI is involved in various research lines, including the ecology of nuisance species, the diversity, seasonality, ecological impact and fate of secondary toxic metabolites produced by cyanobacteria, and reconstruction of past ecological conditions.
[Nico
Salmaso]
Focus : on part_3 A sustainable world 52
Report 09 / 10 → → Highlights
SCIENCE, FOOD AND CITIZENS
The “DecidePub” project, set up by the Natural History Museum of Trento with Slow Food and FEM, takes the “Decide” format and uses it in a new way to discuss issues in nutrition in informal, crowded and noisy environments like pubs, cafeterias and school canteens. The principle aim is to mix the casual, easy going approach typical of “pub games” with the deliberative process at the basis of the original “Decide” game to create a forum in which participants can reflect on controversial issues regarding the production, distribution and consumption of food and associated ecological, sociological and economical impacts. The project, which is financed by the European Commission as part of the FUND scheme, also aims to encourage discussion at a sociable time of day when people are especially receptive to informal exchanges of ideas, discussions and new stimuli
[Floriana Marin, Alessandro Gretter]
http://www.playdecide.eu/play/inspiringstories/1084
A EUROPEAN NETWORK TO CONSERVE GENETIC DIVERSITY
An inadequate level of genetic diversity will impede the evolution and adaptation of species and populations, yet despite its considerable importance, the genetic aspect of biodiversity is usually not taken into account in conservation and management plans. With this in mind, a European consortium has been launched around the EU FP7-funded project ConGRESS. The aim is to create a bridge between scientists and end-users involved in natural resources management in order to fully exploit the potential of genetic studies. The project will last for three years (2010-2013) and the Conservation Genetics group of CRI is the leader of one of the most important workpackages, dedicated to organising workshops/seminars aimed at bringing together scientists and endusers.
[Cristiano
Vernesi]
Focus on part_3 A sustainable world 53
Report 09 / 10 → → Highlights
Lorem ipsum legimus nostrum elaboraret ne nec, error omnes pericula ad usu.
Interactions in living systems
Understanding interconnectivity to improve pest and disease control in a changing world
4
Focus : on part_4 Interactions in living systems Introduction 54 Report 09 / 10
part_
Even where they are highly modified by human activities, such as agriculture, ecosystems are comprised in a dense network of signals used by the species that inhabit them. Various forms of communication between individuals of the same or different species of plants or animals are linked by diverse trophic relationships.
For example, many plants have evolved defences against certain pathogens and pests including the emission of toxic or repellent substances, yet at the same time they release volatile metabolic compounds into the environment that attract other enemies as well as useful predatory or parasitic organisms and pollinators. In the phyllosphere and rhizosphere, complex mechanisms guarantee the equilibrium among microorganisms.
On the other hand, insects use specific olfactory or mechanical stimuli (pheromones, vibrations) to guide them to a potential mate, while in more complex societies, such as those of bees, neurophysiological mechanisms and forms of communication are strikingly similar to those of higher animals. The more specific and complex these relationships, the more they are susceptible to human disturbance. However, even effective management can have unintended negative effects causing the decline in insect pollinators or introducing new plant disease epidemics.
The province of Trentino and FEM have been pioneers in studying the means of communication used by species of interest to agriculture and are currently at the forefront internationally in implementing control strategies that work by interfering with these codes, such as mating disruption in vine moths.
Continuous studies, some aspects of which we present here, are essential in order to improve the methods already in place and adapt them to current global change, and above all in order to implement innovative measures against numerous emerging diseases. A further objective is to understand how external factors affect the delicate neurobiological balance of the species being studied. A consequence of this is that the information gathered will enable us to act more quickly against the invasive organisms that are regularly being introduced to our environment as a result of changing environmental conditions and the globalisation of trade and commerce, necessitating an ever greater vigilance.
The ultimate goal is to add to our knowledge on the interactions between species and environments to in-depth knowledge of plant biology based on the genomes that are being acquired by FEM, in order to arrive at economically and ecologically sustainable management of agroecosystems.
Focus on part_4 Interactions in living systems Introduction 55 Report 09 / 10 4
4. 1
Investigating the memory of bees

Bee species are the most environmentally important insects on Earth, providing an essential contribution to pollination in about 80% of crops. A serious decrease in the bee population could cause a massive reduction in crop production with consequent damage to the agricultural economy. Bee populations are dramatically declining all over the world and scientists have not yet found a definitive cause, which may be due to several factors.
Most of the possible causes seem to be directly associated with the beesʼ olfactory nervous system, impairing their memory and ability to learn.
However, the mechanisms of these interactions are still a matter of conjecture. Understanding the neurophysiological processes involved in the recognition, transduction and processing of olfactory stimuli in different species of bees is, therefore, of fundamental importance and is the goal of our project.
More specifically, we are analysing asymmetries in olfactory perception and learning. Right-left asymmetry in neural structures is associated with cognitive skills and is a common and well-studied phenomenon in vertebrates. Brain asymmetries in
Focus : on part_4 Interactions in living systems Authors Gianfranco Anfora | Elisa Rigosi | Federica Trona 56
Report 09 / 10
insects seem to be correlated with long-term memory. It has recently been revealed that social populations consisting of unequal numbers of left- and right- lateralised individuals may be an evolutional stable strategy where asymmetrical individuals must coordinate their behaviour with other asymmetrical organisms in a given population.
To verify this hypothesis in insects we are carrying out a comparative study of three different species of Apoidea with different social structures: the honeybee Apis mellifera, a perennial eusocial species, the bumblebee Bombus terrestris, an annual social species, and the mason bee Osmia cornuta, a solitary species.
The research is being carried out in collaboration with the Center for Mind/Brain Sciences (CIMeC) and the Department of Physics of the University of Trento. The proj-
ectʼs aims are also being pursued by a recently established research unit, the Invertebrate Neurobiology and Neuroecology Laboratory, shared between FEM and CIMeC.
We examined right/left electroantennographic (EAG) recordings to different odourants and memory recall tests to odour conditioning using the proboscis extension reflex (PER) with a single antenna in use. Results showed significantly greater PER recall and EAG responsiveness in the right than in the left antenna at the population level in honeybee but not in the non-social mason bee.
Bumblebee showed populationlevel right asymmetry in PER learning tasks, but both number and EAG responsiveness of the olfactory receptors were only slightly higher on the surface of the right than on the left antenna.
Thisstudy is the first contribution to elucidating the evolution of population-level asymmetries as distinct outcomes of different social selection pressures in insects and it will help in the protection of pollinators.
Scanning
electron microscopy analysis on antennae support peripheral asymmetry in honeybees and reveal a significant morphological difference in the number of olfactory sensilla, these being more abundant on the right than on the left antenna surface.

Focus on part_4 Interactions in living systems Authors Gianfranco Anfora | Elisa Rigosi | Federica Trona 57
Report 09 / 10
Decoding the mechanisms of insect cognition is essential for their management: brain asymmetries in bees correlate with long-term memory
4. 2
Vibrations could replace insecticides for the control of grapevine leafhoppers
Many insects communicate by means of substrate-borne vibrational signals. When associated with mating behaviour, these signals carry essentially two kinds of information: who and where. Different signal parameters, such as frequency, intensity and rhythm of signal emission, confer high species-specificity through which a male can identify and locate a conspecific female on the same plant. An accurate study of insect communication systems constitutes the key factor in understanding the basic mechanisms that regulate their mating behaviour.
Disruption of the mating communication of a species can dramatically affect their chances of successful reproduction. Although nowadays field applications of mating disruption concern mainly sexual pheromones, applied principally to moth pests as odours, the same principles can be applied to other communication systems. In the case of vibrational signals, the
Communication through substrate vibrations.
disruption can be applied to insect pests by playing back

Focus : on part_4 Interactions in living systems Authors Valerio Mazzoni | Anna Eriksson | Gianfranco Anfora 58
Report 09 / 10
Mating
specific masking signals to plants
transmission of appropriate masking vibrations onto the substrate (host plant) would be an effective way of interfering with the proper insect mating signals.

The leafhopper Scaphoideus titanus Ball is the vector of the Flavescence dorée phytoplasma, a harmful grapevine disease. Mandatory insecticide treatments are required for the control of this insect, compromising all the benefits obtained from the use of ecocompatible strategies, such as pheromone mating disruption against grapevine moths, which have seen a large reduction in chemical usage over time. The mating behaviour of S. titanus is mediated by vibrational signals.
Another important characteristic is a remarkable male-male rivalry, where one male emits specific masking signals to disrupt its rivalʼs mating communication with a female.
A given male only temporarily interrupts the communication of a pair in order to replace its rival in the vibrational duet with the female as the new suitor.
Taking inspiration from this natural example, we recorded, manipulated and then played back the male rivalry signal into grapevine plants. Electromagnetic shakers were attached to vine-supporting wires to transmit the disruptive signal throughout the grapevine plants.
Pairs of S. titanus were confined on the plants and subjected to the vibratory treatment for 16 hrs. Afterwards, the females were removed and dissected to check the number of eggs in the ovarioles. The method turned out to be highly effective, with almost all of the treated couples still virgin, whereas the majority of the untreated females had been mated.
Further experiments on mating disruption by vibrational signals are in progress. The potential of this technique appears to be considerable, especially as far as instruments and application methods are concerned. The use of a pest control method based exclusively on physical/mechanical principles would open new scenarios for ecocompatible management of crops as an alternative to the large-scale use of chemical insecticides.
Focus on part_4 Interactions in living systems
59
Authors Valerio Mazzoni | Anna Eriksson | Gianfranco Anfora
Report 09 / 10
4. 3
The role of plant volatiles in insect-plant interactions
We are studying the ecological role of plant volatiles in insect-plant interactions. These trophic relationships are mediated by plant chemistry, and it is well known that secondary plant metabolites, such as plant volatiles, serve as signals for herbivorous insects during host-location and oviposition.
We hypothesised that herbivorous insects, such as the grapevine moth Lobesia botrana, rely on volatile signals from the substrate to assess the quality of food for their offspring. We also predicted that food quality and volatile signal are both affected by the microorganisms interacting with the plant.
To test this, we correlated moth oviposition preference for grapes infected with micro-organisms with the fitness of the larvae on a diet supplemented with different micro-organisms. In fact, female oviposition preference correlated with the nutritional value of the food sources. Attractive oviposition sites, such as yeasts, resulted in an increased level of fitness.
Insects recognise food quality from odours

Focus : on part_4 Interactions in living systems Authors Marco Tasin | Carmela Sicher | Ilaria Pertot 60
Report 09 / 10
Instead, a pathogenic fungus (Botrytis cinerea) with a detrimental effect on insect fitness discouraged oviposition. Therefore, we showed that the quality of a host plant as larval food for a herbivorous insect is greatly affected by the presence of pathogenic or saprophytic microorganisms on the plant.
Thevolatile bouquet released by the plant-microbe(s) association signals the quality of the food source to egg-laying females. The preference-performance hypothesis, according to which ovipositing females evolved to lay eggs on hosts on which their offspring perform best, was confirmed in L. botrana
There are still gaps in our knowledge about how different sensory modalities (taste and vision, and their interaction with each other and with olfaction) and addi-

tional plant-microbe associations interact in shaping plant-microbeinsect associations.
In the context of the preferenceperformance hypothesis, there is still no clear distinction between preference for oviposition site on which the offspring will perform best and attraction to sites that enhance the fitness of the egg-laying adults.
Investigation of the information carried by volatile signals from oviposition sites may help to decipher the codes (i.e. the volatile blends) sending different behavioural messages to egg-laying females.
Knowledge of how behaviourally active volatiles signal to egg-laying females will help us to develop new methods for low-impact management of pest insects.
Focus on part_4 Interactions in living systems Authors Marco Tasin | Carmela Sicher | Ilaria Pertot 61
Report 09 / 10
4. 4
Perception, coding and the interaction of pheromone and plant signals in the codling moth Cydia pomonella

Insects are surrounded by a complex mixture of odours and from this multitude of signals they must discern and respond to only those that are behaviourally relevant. Sex pheromones mediate communication prior to mating and allow males to find conspecific females, while plant volatiles guide females to food sources and larval host plants. Semiochemicals, both social and environmental cues, are efficient and suitable for area-wide insect control and will thus stimulate industrial development in the world-wide plant protection sector facing food security as a future challenge.
Odour reception is primarily mediated by olfactory receptors (ORs), expressed on the surface of the olfactory receptor neurons (ORNs), which innervate specific antennal sensilla. The signals from activated ORNs are first transmitted to the primary integration centre for olfactory information, the antennal lobe (AL), and then to higher brain centres where they are translated into appropriate behaviours. Sophisticated experimental tools are now available to track the transformation of odour signals from ORs to the olfactory centre
Focus : on part_4 Interactions in living systems Authors Federica Trona | Jonas Bengtsson | Marco Tasin | Gianfranco Anfora 62
Report 09 / 10
From antenna to brain: high level of interaction between sex pheromones and host plant odour cues in the codling moth antennal lobe.
in the brain. With these techniques, it is now possible to fill some of the most important remaining gaps in our knowledge of insect olfaction and to develop semiochemicals as efficient and safe tools for insect management.

The codling moth, Cydia pomonella, a world-wide pest of pome fruit, has long been a model in the development of behaviourmodifying chemicals for sustainable insect control. As a first step to studying the molecular mechanisms involved, we identified putative OR sequences in the antennae of male and female codling moths by screening the antennal transcriptome. A cDNA library was constructed on the basis of antennal RNA and pyrosequenced using 454 technology.
Putative OR genes were identified by gene sequence analysis using a BLAST database comparison
with OR genes identified in other insect species. We are now extending the putative OR genes to their full length using RACE-PCR and are carrying out a tissue-specificity analysis using qPCR. The spatial and temporal expression of ORs on the antenna and their functional role will be investigated using in situ hybridization, and heterologous expression will be used to functionally characterise selected ORs.
In order to answer the question of how olfactory information is integrated in the codling moth brain, we performed an anatomical study of the AL as a prerequisite for ensuing functional studies.
Three-dimensional reconstruction of the AL structure, based on fluorescence microscopy investigations, led to identification of a specific organisation and number of functional units, glomeruli, involved in the coding of odour quality. The map of the AL was then integrated
with electrophysiological recordings of the response of individual neurons in the ALs of males and females to sex pheromone components and behaviourally active plant volatiles by means of intracellular recordings. Stimulation with single chemicals and 2-component blends of them produced both synergistic and inhibitory interactions in neurons innervating different glomeruli.
Thisinitial morphological and functional characterisation of the codling moth AL reveals an integrated pattern of representations of social and environmental odours, suggesting a high level of interaction between these signals. We are currently focusing on a detailed analysis of blend interaction, which involves both AL coding and behavioural studies.
Focus on part_4 Interactions in living systems
|
|
|
63
Authors Federica Trona
Jonas Bengtsson
Marco Tasin
Gianfranco Anfora
Report 09 / 10
4. 5
Global change and the emergence of new zoonotic diseases

Across the globe, there is an unprecedented increase in the prevalence of infectious disease among humans. Incredibly, almost half of all human infectious diseases known today can be classified as “emerging” because they have either recently been discovered, increased in incidence or prevalence, expanded in geographic or climatologic range, or jumped from animal populations into humans (called “zoonosis”).
SARS (severe acute respiratory syndrome), pox virus, Nipah virus, Avian influenza, tick-borne diseases (such as Lyme disease and tick-borne encephalitis) and West Nile virus are examples of emerging infectious diseases (EIDs) that have spilled over from animal reservoirs into humans, causing significant outbreaks in many areas of the globe. The major drivers include changes in economies and land use, climate change and biodiversity loss. In addition, international travel and commingling of humans and wildlife has increased the opportunity for rapid disease transmission and emergence, and the
Focus : on part_4 Interactions in living systems Authors Annapaola Rizzoli | Heidi Hauffe | Markus Neteler | Roberto Rosà | Valentina Tagliapietra 64
Report 09 / 10
global economy means that such diseases have significant social, political, and economic consequences.
The most important EIDs reported in Europe and alpine environments include those transmitted by arthropod vectors (ticks and mosquitoes) and those carried by rodents and birds. Some of our recent findings (part of VI FP project EDEN) have shown, for example, that the number of ticks in the natural environment is increasing and then are also expanding in distribution at higher altitudes, mainly as a result of changes in climate, changes in forest composition and abundance of wild roe and red deer.

All these changes have not only favoured the creation of suitable climatic and habitat condition for the ticks, but also a greater risk of contact between ticks, their hosts and humans, explaining the increase in circulation of certain tick
borne diseases, such as tick borne encephalitis (TBE). Genetic analyses carried out in our laboratories have also shown that some of the TBE virus strains found in Trentino are distinct from the main EU strains. The disease is caused by a virus and is most often transmitted to humans by ticks that have acquired the infection while feeding on forestdwelling rodents, especially the yellow-necked mouse (Apodemus flavicollis). Wild rodents which live in forest and agricultural areas are also responsible for transmitting other diseases directly to humans.
We have recently shown, for example, that the lymphocytic choriomeningitis virus (LCMv), mainly carried by the house mouse (Mus musculus domesticus), is widespread throughout the central and eastern Alps, including Trentino, in several wild rodents (e.g. A. flavicollis, Myodes glareolus).
We are now looking deeper into the prevalence, ecology and epidemiology of these serious diseases in this region. Our results clearly indicate the importance of maintaining our research efforts to track the evolution of their potential to cause severe disease in humans in the Region. Our results are also fundamental to physicians who must be adequately prepared to recognise and treat diseases transmitted to humans from wild animals, often unrecognised.
But our work is particularly useful also to land owner and land managers for a better understanding of the functional role of biodiversity in our region and to support interventions useful for reducing the impact of economical activities on biodiversity.
Focus on part_4 Interactions in living systems
Authors
Annapaola
65
Rizzoli | Heidi Hauffe | Markus Neteler | Roberto Rosà | Valentina Tagliapietra
Report 09 / 10
Advanced molecular and modelling techniques can prevent the spread of emerging wildlife zoonotic diseases under the pressure of global change and through interaction among wild animals and their parasites and pathogens.
4.6
A closer look into animalsʼ lives: GPS technology applied to animal ecology

Throughout the history of science, rapid conceptual advances have often been stimulated by technological advances. A new, exciting synergy between animal ecology and GPS-based radiotelemetry is presented in the Theme issue of the Philosophical Transactions of the Royal Society B “Challenges and opportunities of using GPS-based location data in animal ecology”, compiled and edited by Francesca Cagnacci, Luigi Boitani, Roger A. Powell and Mark S. Boyce.
In animal ecology, reality is observed on approximately the same space-time scale as an observerʼs experience. However, direct, human observations cannot provide data that are sufficiently thorough and standardised to allow falsification of ecological hypotheses for all animals and all kinds of research questions. The most logical step is to move the point of observation from the observer to the observed, i.e. the studied animal. Biotelemetry (remote measurement of the state variables of individual, free-living animals) has been the technological revolution that has allowed expansion of the mechanistic approach to the ecology of large animals.
Focus : on part_4 Interactions in living systems
66
Author Francesca Cagnacci
Report 09 / 10
Among the variables that can be measured with respect to a freeliving animal, its position in space is one that provides intuitive and immediate ways to relate the animal to its environment.
For example, we might ask ourselves what phenotypes (adaptations) are required to be in a certain place at a certain time (Why is the animal there? What are the consequences of being there?).
Animal positions also provide the basic unit of movement paths and show where individuals interact with the ecosystems around them. Those interactions ultimately determine animal fitness. In other words, animal locations provide the “live” point of contact between ecology and evolution.
New telemetry technology allows researchers to monitor and map details of animal movement and to secure vast quantities of data even

for highly cryptic organisms. Telemetry using Global Positioning Systems (GPS), in particular, has several technical advantages, including the ability to continuously track terrestrial, avian and marine species while they move, migrate, disperse, return, select and use resources, compete, reproduce, die.
It is likely that in the not too distant future, intense sampling of movement will allow us to represent an animalʼs cognitive map of its environment and the intimate relationship between behaviour and fitness. This powerful synergy between science and technology is rapidly shaping the very structure of the discipline of ecology.
The Theme issue presents the “state of the art” of analytical methods applied to animal location data and introduces original ideas for their efficient use. Specifically, the various authors explain how
these better datasets can help scientists in their search for a mechanistic understanding of key traditional concepts and for new perspectives on animal ecology. The take-home message is that only the integration of analytical and technical advances within solid theoretical frameworks will allow us to tackle the intimate complexities of ecosystems and their sensitivity to a changing planet.
Focus on part_4 Interactions in living systems
Author
Francesca
67
Cagnacci
Report 09 / 10
Animal ecology meets GPS-based radiotelemetry: a perfect storm of opportunities and challenges.
PHYTOTOXINS AGAINST PHYTOPATHOGENS

Plants produce secondary metabolites which play a key role in biological constitutive defence mechanisms against insects and pathogens. Medicinal plants are an important source of metabolites with antimicrobial activity. We discovered a high antifungal activity of Salvia officinalis extract against Plasmopara viticola, which was linked to two molecules: sclareol and manool, belonging to the terpenes group. The production of these active compounds in cell cultures in bioreactors allows us to obtain cheap, natural, biodegradable and environmentally friendly products for effective crop protection.
THE TIGER MOSQUITO INVASION IN TRENTINO
[Silvia
Dagostin, Oscar Giovannini, Silvia Carlin, Ilaria Pertot]
We monitored the spread of the Asian tiger mosquito (Aedes albopictus) in Trentino through a field data survey carried out over several years. The results confirm the positive trend in expansion in the Valle dei Laghi and in the Valle dellʼAdige, and we also found new colonisation in the city of Trento. The spread of this species is influenced by several climatic factors, such as temperature and rainfall. GIS analysis of satellite data has also enabled us to identify the most suitable areas for future Ae. albopictus expansion in north-eastern Italy. This will provide guidance to decision makers in local administrations in initiating prevention and pest-control campaigns.
[David Roiz, Markus Neteler]
THE SOIL AS A SINGLE ORGANISM

The relationships established among different soil microorganisms represent a complex network of multitrophic interactions which reflect on the entire terrestrial ecosystem. The outcome of these complex interactions is an important factor in soil quality, yet, so far, microbial activities in soil have been studied independently. The new techniques of molecular biology and sequencing now allow the microbial soil community to be considered globally as a single organism, whose functions are the sum of the functions of each organism within it. This new approach paves the way for the development of more reliable and cheap methodologies to assess soil quality in agriculture.
[Paola
Corneo, Alberto Pellegrini, Claudia Longa, Ilaria Pertot]
Gene regulation plays a pivotal role in the ability of living organisms to adapt to their environment. Besides transcriptional regulation, post-transcriptional gene silencing (PTGS) is emerging as a fundamental mechanism of stress response both in plants and animals. Through comparative analyses in Brassiaceae, the family of the model plant Arabidopsis, we found evidence that multistep processing of MIR168 microRNA represents an evolutionarily conserved mechanism which may be involved in fine tuning of PTGS of other stressrelated microRNAs in plants.
[Claudio Varotto]
Focus : on part_4 Interactions in living systems 68
POST TRANSCRIPTIONAL GENE SILENCING
Report 09 / 10 → → → → Highlights
Interactions in living systems
VECTOR BIONOMICS AND CONTROL
INTRIGUING VIRUS FOUND FOR THE FIRST TIME IN ITALY
The Ljungan virus (LV) was discovered 10 years ago in wild voles in Sweden and has recently been associated with several human diseases, including diabetes. LV was reported for the first time in Italy in bank voles (Myodes glareolus) and yellow-necked mice (Apodemus flavicollis) by Hauffe and colleagues in the Journal of Wildlife Diseases in 2010, significantly increasing the geographical and species range of this pathogen. The distribution of LV among wild and domestic mammal species is now being investigated at local and European levels using PCR technology in order to assess the potential significance of the virus as a human pathogen, identify possible zoonotic sources and lay the groundwork for possible vaccine development.
[Heidi C. Hauffe]
AUTOMATED REMOVAL OF NOISY DATA IN PHYLOGENOMIC ANALYSES
A new test procedure for improving the accuracy in phylogeny reconstruction was developed in order to evaluate and solve problems related to substitutional saturation in the data. This method uses patterns of substitution in DNA sequences as a basis to establish relationships between species. The proposed test helped to resolve issues of diversification among placental mammals and demonstrated that the correct picture of evolution, accepted, shows rodents and rabbits (Glires) as a sister group to Primates. This work has recently been published in the Journal of Molecular Evolution.

[Vadim
Goremykin, Svetlana Nikiforova]
Continuous outbreaks of several vectorborne diseases around the globe has raised the awareness of the European Community which has invested in research on this topic under the “Health” section of the VII FP. Eurowestnile is a small-scale collaborative project involving 14 partners in 7 countries and has the strategic aim of developing an integrated European research on West Nile virus. It is specifically focussed on generating new knowledge and innovative products of particular interest to European citizens for the control and prevention of the disease.
EDENext (Biology and control of vectorborne infections in Europe) is a large-scale collaborative project involving 46 partners in 22 counties; its main goal is to understand and explain the biological, ecological and epidemiological processes driving vector-borne disease emergence in order to develop methods and tools to improve prevention, surveillance and control of vector populations and vector-borne human and animal diseases.
[Annapaola
Rizzoli]
Focus on part_4 Interactions in living systems 69
Report 09 / 10
→ → primates primates W hich p ath is ri gh t? New test helps to decide Highlights
our research : facts and figures
part_1 Our International Network
part_2 Research Projects
part_3 CRI Events
part_4 Theses completed by FEM
part_5 Awards 09/10
part_6 Editorial board memberships
part_7 CRI Publications
part_8 Organization chart
Report 09 / 10 71
Our research: facts and figures
Focus Annual Report
on
our research: facts and figures
Focus : on part_1 Our International Network 72 Report 09 / 10
EUROPE
Our International Network
Focus on part_1
43 / Italy
Our International Network
ITALY
+ Accademia dei Lincei, Roma
+ Centre for Computational and Systems Biology (COSBI), Trento
+ Centre for Mind/Brain Sciences (CiMeC), University of Trento
+ Agricultural Research Council (CRA), Roma - Follonica - Trento
+ CIHEAM, Mediterranean Agronomic Institute, Bari
+ Environment Protection Agency (APPA), Autonomous Province of Trento
+ European Academy Bozen (EURAC), Bolzano
+ Fondazione Bruno Kessler, Trento
+ Forestry Service, Autonomous Province of Trento
+ Health Services Agency (APSS), Autonomous Province of Trento
+ ICQ-RF-Italian Ministry of Agricultural, Food and Forestry Policy, Roma
+ Institute for Ecosytem Studies, Verbania - Pallanza
+ Istituto Superiore di Sanità (ISS), Roma
+ - Istituto Superiore di Sanità (ISS), Roma
+ Istituto Zooprofilattico Sperimentale della Lombardia e dellʼEmilia Romagna “Bruno Ubertini” (IZSLER), Brescia
+ Istituto Zooprofilattico Sperimentale delle Tre Venezie (IZSP), Legnaro
+ Joint Research Centre, Ispra
+ MTSN Natural History Museum of Trento
+ National Council of Research (CNR), Roma - Firenze
+ Research, Ecology and Environment Dimension (D.R.E.Am. Italia), Pratovecchio
+ Stelvio National Park, Bornio - Glorenza - Peio
+ TerraData environmetrics, Siena
+ Università Cattolica del Sacro Cuore, Piacenza
+ University of Bari “Aldo Moro”
+ University of Bologna
+ University of Calabria
+ University of Ferrara
+ University of Firenze
+ University of Milano Bicocca
+ Università Politecnica delle Marche
+ University of Napoli (Federico II)
+ University of Roma “La Sapienza”
+ University of Padova
+ University of Parma
+ University of Pavia
+ University of Piacenza
+ University of Pisa
+ University of Salento
+ University of Siena
+ University of Trento
+ University of Torino
+ University of Trieste
+ University of Udine
+ University of Urbino “Carlo Bo”
73 Report 09 / 10
1 / Ireland
17 / United Kingdom
12 / France
+ University of Bolton
+ Department of Geography, University College, London
+ Department of Zoology, University of Oxford
+ Faculty of Veterinary Science, Department of Veterinary Pathology, University of Liverpool
+ University of Lancaster
+ University of Leeds
+ University of Manchester
+ NERC Centre for Population Biology, Imperial College London
+ School of Biosciences, University of Cardiff
+ School of Geography, University of Nottingham
+ Scottish Crop Research Institute, Invergrowie
+ UK Commission for Rural Communities, Cheltenham
+ University of East Anglia, Norwich
+ University of Glasgow
+ University of St. Andrews
+ University of York
+ East Malling Research (EMR), East Malling
+ Agence nationale de sécurité sanitaire de lʼalimentation, de lʼenvironnement et du travail (ANSES), Maisons - Alfort Cedex + CEMAGREF, Grenoble
+ Centre de Biologie et de Gestion des Populations, Montpellier
+ CIFASIS, French Argentina International Center for Information and Systems Sciences (UPCAM), Marseille
+ Département dʼElevage et de Médecine Vétérinaire, Centre de Coopération Internationale en Recherche Agronomique pour le Développement, Montpellier
+ Direction des Etudes et de la Recherche (ONCFS), Le Perray - en - Yvelines
+ Eurofins Scientific, Nantes
+ Institute National de la Recherche Agronomique (INRA), Angers - Paris - Avignon - Montpellier - Toulose
+ Institut des Sciences de la Vigne et du Vin Bordeaux Aquitaine (ISVV), Villenave dʼOrnon
+ Institut Pasteur, Paris
+ Civil and Environmental Engineering Departement, University College Cork
Focus : on part_1 Our International Network 74
Report 09 / 10
UNITED KINGDOM IRELAND FRANCE
EUROPE
Our International Network
9 / Germany
+ LʼEcole Nationale dʼIngénieurs des Techniques des Industries Agricoles et Alimentaires, ENITIAA, Nantes
+ Laboratory of Biometry and Evolutionary Biology (LBBE), University of C. Bernard, Lyon 1
GERMANY
+ Bavarian Forest National Park, Nürnberg
+ Wilhem Dierking Beerenobst, Gilten
+ Institut für Vergleichende Tropenmedizin und Parasitologie Ludwig-Maximilians-Universitaet, Münich
+ Julius Kühn-Institut (JKI), Dresden
+ Julius Kühn-Institut (JKI), Darmstadt
+ Leibniz-Institute for Zoo and Wildlife Research, Berlin
+ Max Planck Institute for Ornithology, Radolfzell
+ Technischen Universität München, Münich
+ AlPlanta - Institute for Plant Research RLP AgroScience, Neustadt
3 / Portugal
6 / Spain
+ Instituto de Salud Carlos III, Madrid
+ Neiker Instituto Vasco de Investigation y Desarrolo Agrario, Arkaute
+ Museo Nacional de Ciencias Naturales, Departamento Biodiversidad y Biología Evolutiva, Madrid
+ University of Santiago de Compostela
PORTUGAL
+ University of Trás-os-Montes and Alto Douro
+ Laboratory of Plant Cell Biotechnology, University of Lisbon
+ Department of Biology/CESAM, University of Aveiro SPAIN
+ Agencia Estatal Consejo Superior de Investigaciones Científicas, Madrid
+ Instituto de Ciencias de la Vid y del Vino (CSIC, University of La Rioja), Logroño
Report 09 / 10
Focus on part_1 Our International Network
3 / Norway
5 / Sweden
2 / Finland
1 / Latvia
1 / Lithuania
1 / Poland
3 / Austria
4 / Hungary
5 / Switzerland
+ Swedish University of Agricultural Science (SLU), Umeå Alnarp
+ Swedish Institute for Communicable Disease Control, Solna
+ Univerisity of Lund
+ University of Uppsala
+ Wildlife Research Station, Swedish University of Agricultural Science (SLU), Grimsö
+ Istituto Scienze della Terra, Scuola Universitaria Professionale della Svizzera Italiana (SUPSI), Canobbio
+ KORA, Bern
+ WSL Swiss Federal Inst. for Forest, Snow and Landscape Research, Birmensdorf
+ Integrative Biology Institute (ETH), Zürich
+ Research Institute of Organic Agriculture (FIBL), Frick
+ Department of Biology, University of Oslo
+ Nofima Mat - Research on food, taste and food for health, Ås
+ Norsk Institutt for Naturforskning (NINA), Trondheim
+ University of Debrecen
+ Department of Viral Diagnostics, “Johan Béla” National Centre for Epidemiology, Budapest
+ Hungarian Academia of Science, Budapest
+ University of Pécs
+ Department of Epidemiological Surveillance of Infectious Diseases, Public Health Agency, Riga
+ Finnish Forest Research Institute, Research Centre, Vantaa
+ Haartman Institute, Department of Virology, University of Helsinki
+ Medical University of Bialystok
Focus : on part_1 Our International Network 76
POLAND FINLAND Report 09 / 10
SWEDEN SWITZERLAND NORWAY HUNGARY LATVIA
EUROPE
Our International Network
1 / Estonia
2 / The Netherlands
6 / Belgium
SLOVAK REPUBLIC
+ Department of Medical Zoology, Slovak Academy of Sciences, Bratislava
LITHUANIA
+ Centre for Communicable Diseases Prevention and Control, Vilnius
+ Laboratory of Medical Entomology, National Institute of Research and Development for Microbiology and Immunology “Cantacuzino”, Bucharest
+ National Health Development Institute, Department of Virology, Tallinn
CZECH REPUBLIC
+ Academy of Sciences of the Czech Republic, Praha
+ Department of Science and Research, Šumava National Park Admin, Vimperk
+ Institute of Vertebrate Biology (IVB), Brno
+ Institut für Ionenphysik und Angewandte Physik, University Leopold Franzens of Innsbruck
+ University of Natural Resources (BOKU), Wien
+ University of Innsbruck
2 / Czech Republic
1 / Slovak Republic
1 / Romania
5 / Slovenia
2 / Croatia
BELGIUM
+ Agriculture and Veterinary Information and Analysis, Zoersel
+ Faculty of Biology, Research Group of Evolutionary Biology, University of Antwerp
+ Research Institute for Nature and Forest (INBO), Brussel
+ University of Gembloux
+ University of Ghent
+ University of Liege
THE NETHERLANDS
+ Plant Reserach International, Wageningen
+ RIKILT - Institute of Food Safety, Wageningen
CROATIA
+ Department of Game Biology, University of Zagreb
+ Institute for Adriatic Crops and Karst Reclamation, Split
SLOVENIA
+ Agricultural institute of Slovenia, Ljubljana
+ Ecological Research and Industrial Cooperation (ERICo), Velenje
+ Institute of Microbiology, Laboratory for zoonoses, Medical Faculty of Ljubljana
+ National Institute of Biology, Ljubljana
+ University of Nova Gorica
Focus on part_1 Our International Network
77
AUSTRIA
ROMANIA ESTONIA
Report 09 / 10
5
/ North America
NORTHAMERICA
1 / Chile
USA
+ Annis Water Research Institute (AWRI), Michigan
+ Center for Infectious Disease Dynamics, Penn State University, Pennsylvania
+ Cornell University, Ithaca (New York)
+ Department of Biological Sciences, Murray State University, Kentucky
+ Department of Geography, University of California, Los Angeles (California)
+ Department of Natural Resources, University of Minnesota, St. Paul (Minnesota)
+ Georgia Tech., Atlanta (Georgia)
+ Gulf Coast Geospatial Center, The University of Southern Mississippi
+ Harvard University, Cambridge (Massachusetts)
+ Idaho State University, Pocatello (Idaho)
+ Natural History Museum and Biodiversity Research Center, University of Kansas, Lawrence (Kansas)
+ North Carolina State University, Raleigh (North Carolina)
+ Open Source Geospatial Foundation, Portland (Oregon)
+ Ripon College, Ripon (Wisconsin)
+ Rutgers University, Newark (New Jersey)
+ State University of New York, College of Environmental Science and Forestry, New York
+ Telonics Inc., Mesa (Arizona)
+ TUFTs University, Boston (Massachusetts)
+ U.S. Geological Survey, Science Center, Fort Collins (Colorado)
+ University of California, Berkeley (California)
+ University of Montana, Missoula (Montana)
+ USGS, Anchorage (Alaska)
+ Virginia Bioinformatics Institute, Blacksburg ( Virginia)
+ Washington State University, Pullman (Washington)
CANADA
+ Canadian Museum of Nature, Ottawa
+ Laval University, Sillery (Quebec)
+ Natural Resources Institute, University of Manitoba, Winnipeg (Manitoba)
+ University of Alberta, Calgary (Alberta)
+ University of Guelph (Ontario)
Focus : on part_1 Our International Network 78 Report 09 / 10
24
2 / Brazil
2 / Argentina
/ Canada
Our International Network
1 / Japan
2 / India
2 / South Africa
5 / Israel
1 / Australia
3 / New Zeland
CHILE
+ INEA, Santiago del Chile
ARGENTINA
+ Laboratorio ECOTONO, Universidad Nacional del Comahue, Bariloche
+ UNL-CONICET, University of Litoral, Santa Fé
BRAZIL
SOUTHAMERICA SOUTHAFRICA
+ Universidade Federal de Santa Catarina, Florianópolis
+ Brazilian Agricultural Research Corporation , Jaguariùna
INDIA
+ Ashoka Trust for Research in Ecology and the Environment, Bangalore
+ SHODH: The Institute for Research and Development, Maharashtra
ISRAEL
+ Department of Evolution, Systematics and Ecology, The Institute of Life Sciences, The Hebrew University of Jerusalem
+ University of Stellenbosch
+ University of Witwatersrand, Johannesburg
+ Department of Geography, Faculty of Social Sciences, The Hebrew University of Jerusalem
+ Volcani Center, Bet-Dagan
+ Weizmann Institute of Science, Tel Aviv
+ University of Haifa
+ CSIRO Plant Industry & Food Futures Flagship, Adelaide
+ Department of Food Science, University of Otago
+ Plant & Food Research Institute, Palmerston North, Oakland
+ City University, Osaka
79
Report 09 / 10
NEW ZEALAND AUSTRALIA OCEANIA
ASIA
Focus on part_1
JAPAN
Our International Network
Research Projects
1 PROJECT funded by / FERRERO TRADING LUX SA




1 PROJECT funded by / NATIONAL ASSOCIATION FOR ENVIRONMENT MONITORING AND CONTROL, ITALY


1 PROJECT funded by / LALLEMAND




1 PROJECT funded by / R&D SYSTEM

1 PROJECT funded by / CAVIT, ITALY
1 PROJECT funded by / INNOVITIS








1 PROJECT funded by / TUTZER VIVAI, ITALY
1 PROJECT funded by / RAGAZZINI SRL, ITALY
1 PROJECT funded by / ZENATO SRL, ITALY

1 PROJECT funded by / VITIS RAUSCEDO SCA

1 PROJECT funded by / FONDAZIONI AGER
5 PROJECTS funded by / CARITRO FOUNDATION ITALY
2 PROJECTS funded by / BELCHIM CROP PROTECTION S.A
2 PROJECTS funded by / CONSORTIUM OF BRUNELLO DI MONTALCINO WINE, ITALY


1 PROJECT funded by / CRODA / BIOPHIL




























BUSINESS

1 PROJECT funded by / CBC EUROPE







1 PROJECT funded by / CONSORTIUM FOR THE PROTECTION OF GRANA PADANO CHEESE, ITALY
1 PROJECT funded by / UNIONE ITALIANA VINI, ITALY





1 PROJECT funded by / SOCIETY FOR THE MANAGEMENT OF WATER IN WESTERN PROVINCE OF BRESCIA AND GARDA ONE LTD., ITALY
1 PROJECT funded by / CENTRO RICERCHE PRODUZIONE ANIMALI C.R.P. A. S.P.A, ITALY
Focus : on part_2 Research Projects / Business 80
Report 09 / 10
1 PROJECT funded by / NATIONAL SCIENCE FOUNDATION, USA
INTERNATIONAL

3 PROJECTS funded by / EUROPEAN UNION



23 PROJECTS funded by / EUROPEAN COMMISSION


1 PROJECT funded by / WATER CATCHMENT AUTHORITY OF RIVER CHIESE
1 PROJECT funded by / MUNICIPALITY OF TRENTO
1 PROJECT funded by / PIEDMONT REGION


















1 PROJECT funded by / LAZIO REGION

2 PROJECTS funded by / ADIGE RIVER BASIN AUTHORITY
1 PROJECT funded by / ITALIAN MINISTRY OF ECONOMIC DEVELOPMENT CONSORTIUM TUSCANIA

1 PROJECT funded by / ITALIAN MINISTRY OF HEALTH
44 PROJECTS funded by / AUTONOMOUS PROVINCE OF TRENTO
2 PROJECTS funded by / SICILY REGION
3 PROJECTS funded by / ITALIAN MINISTRY FOR EDUCATION, UNIVERSITY AND RESEARCH
7 PROJECTS funded by / ITALIAN MINISTRY OF AGRICULTURAL, FOOD AND FORESTRY POLICY


Focus on part_2 Research Projects / National / International 81 Report 09 / 10
NATIONAL
FEBRUARY
WORKSHOP / Applications of Genomic in








08/05/09
MEETING / “Population Genetics for Animal Conservation”. Press release of the book published by Cambridge University Press.
25-26/05/09
WORKSHOP / Eco-physiology of vegetals workshop “The clorophilla fluorescence: from theory to best practices.



MAY
27-29/05/09
WORKSHOP / Techniques and Methods in Eco-physiological Studies in Alpine Ecosystems.
29/05/09


WORKSHOP / Workshop for the promotion of a trans-alpine alliance for research and innovation on the environment and forests.
JULY 10/07/09
WORKSHOP / Studies of Alpine communities in a time of change - Methods to identify resilient outcomes with high social, economic and ecological value.
82 2009
begin
part_3 CRI Events 09 / 10
21-23/09/09
MEETING / Third Annual Workshop for the project GrapeGen06.
09/10/09



HAPPENING / BIOWEEK round table: “The new biology for human and enviromental health”.


OCTOBER
NOVEMBER
27/11/09
WORKSHOP / Insect communication: from brain mechanisms to field application.



Focus on part_3 CRI Events 83
SEPTEMBER
2009end CRI
Report 09 / 10
Events
MARCH 18/03/10

GMPF / Doctorate Programme becomes operational.
APRIL
21-25/04/10
ACTIVITIES / COST ES0903 “EUROSPEC” Action starts its activities.
JUNE
07-11/06/10
WORKSHOP / International Workshop on Lichens.
JULY
05-09/07/10

MEETING / III°National Viticultural Meeting.

Focus : on part_3 CRI Events 84 2010
begin
Report 09 / 10
CRI Events
AUGUST
29/08/10
PRESS RELEASES / APPLE genome sequence is presented.
01/10/10
PRESS RELEASES / Boards of Directors approval of the re-organisation of CRI.
OCTOBER
18/10/10
PRESS RELEASES / FIRST CALL for IPP FEM Fellowships closes.



NOVEMBER 23/11/10
WORKSHOP / Decoding mechanism in insect olfaction - Molecular biology and chemical ecology.
20/12/10
PRESENTATION / The book on the history of grapes in Trentino is released.
DECEMBER
26/12/10
PRESS RELEASES / STRAWBERRY genome sequence is presented.
Focus on part_3 CRI Events 85
2010end Report 09 / 10
Theses completed by
Doctoral Theses
PHD STUDENT/ FEM COORDINATORUNIVERSITY DEPARTMENT


Battilana Juri
FEM COORDINATOR / Maria Stella Grando
Carpi Giovanna
FEM COORDINATOR / Annapaola Rizzoli
Dalponte Michele
FEM COORDINATOR / Damiano Gianelle
Emanuelli Francesco
FEM COORDINATOR / Maria Stella Grando
Ferreira Eduardo Antonio
FEM COORDINATOR / Fulvio Mattivi
Fortes Gris Eliana
FEM COORDINATOR / Fulvio Mattivi
Franciosi Elena
FEM COORDINATOR / Agostino Cavazza
Guzzon Raffaele
FEM COORDINATOR / Agostino Cavazza
Neteler Markus


Paternoster Thomas
FEM COORDINATOR / Ilaria Pertot
Pedron Luca
FEM COORDINATOR / Nicola La Porta
Silveri Luana
FEM COORDINATOR / Bruno Maiolini
Zignin Andrea
FEM COORDINATOR / Bruno Maiolini
University of Padova, Italy
University of Torino, Italy
University of Trento, Italy
University of Milano, Italy
University of Santa Caterina, Brazil
University of Santa Caterina, Brazil
University of Bologna, Italy
University of Trento, Italy
Leibniz University of Hannover, Germany
Swiss Federal Institute of Technology (ETH), Switzerland
University of Firenze, Italy
University of Parma, Italy
University of Parma, Italy
Agro-biotechnology



Animal Production, Epidemiology and Ecology
Information Engineering
Crop Production
Nutrition
Nutrition
Food Science
Engineering of Materials and Industrial Technologies
Institute of Physical Geography and Landscape Ecology
Institute of Integrative Biology
Agrarian and Forestry Biotechnologies
Environmental Sciences and Evolutionary Biology
Environmental Sciences and Evolutionary Biology
86 Report 09 / 10
Focus : on part_4 Theses completed by FEM
STUDENT/ FEM COORDINATOR UNIVERSIT

Master Theses
DEPARTMENT
Scuola Galileiana di Studi Superiori
FEM COORDINATOR / Ilaria Pertot, Michele Perazzolli
Mraihi Mohamed
FEM COORDINATOR / Ilaria Pertot, Marco Tasin
University of Bari, Italy
University of Bari, Italy
Centre International de Hautes Etudes Agronomiques Méditerranéennes
Centre International de Hautes Etudes Agronomiques Méditerranéennes


5-Years Bachelor Theses













STUDENT/ FEM COORDINATORUNIVERSITY DEPARTMENT
Brazzale Daniele
FEM COORDINATOR / Claudio Moser, Stefania Pilati
Lazzeri Elisa
FEM COORDINATOR / Cristiano Vernesi
Leonardelli Loredana
FEM COORDINATOR / Claudio Moser, Silvia Vezzulli
University of Padova, Italy
University of Ferrara, Italy
University of Bologna, Italy
Agrarian Studies
Evolutionary Physics


Medicine and Surgery

Focus on part_4 Theses completed by FEM 87 Report 09 / 10
Biasioli Univers U
o
Theses completed by FEM
Master of Science
STUDENT/ FEM COORDINATORUNIVERSITY
Anesin Giulia
FEM COORDINATOR / Federica Camin
Bozza Elisa
FEM COORDINATOR / Luigi Palmieri
Broseghini Alessandro
FEM COORDINATOR / Marco Stefanini
Cestari Giacomo
FEM COORDINATOR / Ilaria Pertot
Michele Perazzolli
Collini Margherita
FEM COORDINATOR / Cristiano Vernesi
Cont Massimiliano
FEM COORDINATOR / Riccardo Velasco, Elena Zini
Corazzola Alessandro
FEM COORDINATOR / Ilaria Pertot
Silvia Dagostin
Filosi Roberto
FEM COORDINATOR / Ilaria Pertot
Alberto Pellegrini
Fortarel Alberto
FEM COORDINATOR / Ilaria Pertot, Dario Angeli
Giovannini Oscar
FEM COORDINATOR / Ilaria Pertot, Silvia Dagostin
Kusstatscher Natashia
FEM COORDINATOR / Riccardo Velasco, Diego Micheletti
Maccari Jenny
FEM COORDINATOR / Ilaria Pertot, Alberto Pellegrini
Molteni Davide
FEM COORDINATOR / Francesca Cagnacci
Pardatscher Franz
FEM COORDINATOR / Ilaria Pertot
Peripoli Giorgio
FEM COORDINATOR / Nico Salmaso
Semenzato Paola
FEM COORDINATOR / Francesca Cagnacci
University of Modena, Italy
University of Padova, Italy
University of Udine-Trento, Italy
University of Udine, Italy
University of Padova, Italy
University of Verona, Italy
University of Udine, Italy
University of Udine, Italy
University of Udine, Italy
University of Udine, Italy
University of Verona, Italy
University of Udine, Italy
University of Trento, Italy
University of Udine, Italy
University of Padova, Italy
University of Roma La Sapienza, Italy
DEPARTMENT
Pharmacy
Agrarian Studies
Agrarian and Engineering Studies
Biology and Plant Protection
Agrarian Studies/ Mathematics, Physics and Natural Sciences
Medicine and Surgery
Biology and Plant Protection
Biology and Plant Protection
Biology and Plant Protection
Biology and Plant Protection
Medicine and Surgery
Biology and Plant Protection
Telecommunications Engineering
Biology and Plant Protection
Biology
Mathematics, Physics and Natural Sciences
88 Report 09 / 10 Focus : on part_4 Theses completed by FEM
Bachelor Theses
STUDENT/ FEM COORDINATOR UNIVERSITY DEPARTMENT
Berteotti Silvia FEM COORDINATOR / Cristiano Vernesi
Broseghini Alessandro FEM COORDINATOR / Marco Stefanini
Dal Lago Chiara FEM COORDINATOR / Maria Stella Grando
Graiff Matteo FEM COORDINATOR / Gianfranco Anfora
Hofer Gregor FEM COORDINATOR / Marco Stefanini, Duilio Porro
Höyng Fabian FEM COORDINATOR / Marco Stefanini
Larger Simone FEM COORDINATOR / Massimo Pindo
Locci Stefano FEM COORDINATOR / Flavia Gasperi
Maistri Simone FEM COORDINATOR / Juri Battilana
Melchiorri Matteo FEM COORDINATOR / Marco Stefanini
Michelini Samanta FEM COORDINATOR / Nicola La Porta
Nicolini Daniela FEM COORDINATOR / Riccardo Velasco
Pacher Andrea FEM COORDINATOR / Juri Battilana, Maria Stella Grando
Pojer Nicola FEM COORDINATOR / Flavia Gasperi
Poli Michele FEM COORDINATOR / Bruno Maiolini
Recchia Domenico FEM COORDINATOR / Flavia Gasperi
Roccaforte Vincenzo FEM COORDINATOR / Silvia Vezzulli, Riccardo Velasco
Rossi Stefano FEM COORDINATOR / Ilaria Pertot, Dario Angeli
Simeoni Federico FEM COORDINATOR / Fulvio Mattivi
Tovazzi Marco FEM COORDINATOR / Ilaria Pertot, Alberto Pellegrini
Wolf Joachim FEM COORDINATOR / Fulvio Mattivi
Zanotti Tania
FEM COORDINATOR / Ilaria Pertot, Dario Angeli
Zublasing Georg FEM COORDINATOR / Ilaria Pertot
Zublasing Philipp FEM COORDINATOR / Flavia Gasperi
University of Verona, Italy
University of Udine-Trento, Italy
University of Padova, Italy
University of Padova, Italy
University of Udine-Trento, Italy
University of Geisenheim, Germany
University of Verona, Italy
University of Trento, Italy
University of Udine Trento, Italy
University of Udine Trento, Italy
University of Bologna, Italy
University of Verona, Italy
University of Ferrara, Italy
University of Trento, Italy
University of Padova, Italy
University of Trento, Italy
University of Verona, Italy
University of Udine, Italy
University of Udine-Trento, Italy
University of Udine, Italy
University of Geisenheim, , Germany
University of Udine-Trento, Italy
University of Udine, Italy
University of Udine, Italy
Mathematics, Physics and Natural Sciences
Agrarian and Engineering Studies
Agrarian Studies
Agronomy and Vegetal Productions
Agrarian and Engineering Studies
Agrarian and Engineering Studies
Medicine and Surgery
Cognitive Science
Agrarian and Engineering Studies
Agrarian and Engineering Studies
Department of Arboreal Cultures
Medicine and Surgery
Mathematics, Physics and Natural Sciences
Cognitive Science
Agrarian Studies/ Mathematics, Physics and Natural Sciences
Cognitive Science
Medicine and Surgery
Biology and Plant Protection
Agrarian Studies
Biology and Plant Protection
Agrarian and Engineering Studies
Biology and Plant Protection
Biology and Plant Protection
University of Udine-Trento, Italy
Agrarian and Engineering Studies
Report 09 / 10 Focus on part_4 Theses
89
completed by FEM
Awards 09/10
AWARD INSTITUTION
SOIO 2010 award best scientific pubblication



Best Scientific Presentation in 2009
Best Scientific Poster
“Marchetti” award 2009 best scientific presentation
Best Scientific Research
SIVE Awards “Italian Research for development”
Karl Bayer 2010 best disseration on enology and viticulture
“Mars ‒ Glaxo” best scientific poster in Euroberry Section
Italian Horto-Fructicultural Society
RECIPIENT
Juri Battilana
Italian Association of Oceanology and Limnology Barbara Centis
Italian Sensorial Sciences Society






Maria Laura Corollaro
Italian Ecology Society
Domenico DʼAlelio
Italian Association of Milk Technicians (AITeL)
Alessandra Fabris
Italian Society of Viticulture and Enology

Karl Bayer Consortium
Raffaele Guzzon, Agostino Cavazza, Giovanni Carturan
Simone Maistri
International Conference on Polifenols and Health 2009 Urska Vrhovsek
90
Report 09 / 10
Focus : on part_5
09/10
Awards
Editorial board memberships
SCIENTIFIC JOURNALWEBSITE MEMBERS
American Journal of Enology and Viticulture
ISHS Acta Horticulturae
Journal of Food, Agriculture & Environment
IOBC-WPRS Bulletin
http://www. ajevonline.org
http://www.actahort.org
http://www.isfae.org/scientific journal.php
http://www.iobc-wprs.org/pub/index.html
Journal of Limnology http://www.iii.to.cnr.it
Advances in Oceanography and Limnology
Mycology
Mitteilungen Klosterneuburg
Molecular Breeding
Plant Molecular Biology Reporter
Recent Patents on Food, Nutrition & Agriculture
South African Journal of Oenology and Viticulture
Tree Genetics and Genomes
VITIS ‒ Journal of Grapevine research
VQ - In vite qualitas, in vino excellentia
http://www.tandf.co.uk
http://www.tandf.co.uk/journals
http://bundesamt.weinobstklosterneuburg.at
http://www.springer.org
http://www.springer.org
:http://www.bentham.org/pfna/EBM.htm
http://www.sasev.org/journal
http://www.springer.org
http://www.bafz.de
http://www.tecnichenuove.com
Riccardo Velasco
Lara Giongo
Lucia Martinelli
Ilaria Pertot
Nico Salmaso
Nico Salmaso
Nicola La Porta
Fulvio Mattivi, Urska Vrhovsek
Silvio Salvi
Riccardo Velasco
Fulvio Mattivi, Eugenio Aprea
Lucia Martinelli, Fulvio Mattivi
Riccardo Velasco
Fulvio Mattivi, Lucia Martinelli
Maria Stella Grando, Fulvio Mattivi, Marco Stefanini, Riccardo Velasco
Focus on part_6 Editorial board memberships 91
Report 09 / 10
Articles published in scientific journals with impact factor



92 Focus : on part_7 CRI Publications Report 09 / 10
Amici V., Geri F., Csontos P., Neteler M., Rocchini D. (2010). Fuzzy and boolean forest membership: on the actual separability of land cover classes.
Applied Ecology and Environmental Research, 8, (1): 39-50. http://www.ecology.kee.hu/indvol08_1.htm
Anfora G., Tasin M., De Cristofaro A., Ioriatti C., Lucchi A. (2009).
Synthetic grape volatiles attract mated Lobesia botrana females in laboratory and field bioassays.
Journal of Chemical Ecology, 35, (9): 1054-1062.
DOI: 10.1007/s10886-009-9686-5
Anfora G., Frasnelli E., Maccagnani B., Rogers L.J., Vallortigara G. (2010). Behavioural and electrophysiological lateralization in a social (Apis mellifera) but not in a non-social (Osmia cornuta) species of bee.
Behavioural Brain Research, 206, (2): 236-239.
DOI: 10.1016/j.bbr.2009.09.023
Angeli D., Pellegrini E., Pertot I. (2009).
Occurrence of Erysiphe necator Chasmothecia and their natural parasitism by Ampelomyces quisqualis.
Phytopathology, 99, (6): 704-710.

DOI: 10.1094/PHYTO-99-6-0704
Aprea E., Biasioli F., Carlin S., Endrizzi I., Gasperi F. (2009).
Investigation of volatile compounds in two raspberry cultivars by two headspace techniques: solid phase microextraction/gas chromatography-mass spectrometry (SPME/GC-MS) and proton-transfer reaction-mass spectrometry (PTR-MS).
Journal of Agricultural and Food Chemistry, 57, (10): 4011-4018.
DOI: 10.1021/jf803998c
Aprea E., Carlin S., Giongo L., Grisenti M., Gasperi F. (2010).
Characterization of 14 raspberry cultivars by solid-phase microextraction and relationship with gray mold susceptibility.
Journal of Agricultural and Food Chemistry, 58, (2): 1100-1105.

DOI: 10.1021/jf902603f
BBagnoli F., Vendramin G.G., Buonamici A., Doulis A.G., Gonzalez-Martinez S.C., La Porta N., Magri D., Raddi P., Sebastiani F., Fineschi S. (2009). Is Cupressus sempervirens native in Italy? An answer from genetic and palaeobotanical data. Molecular Ecology, 18, (10): 2276-2286.
DOI: 10.1111/j.1365-294X.2009.04182.x
Baldo A., Norelli J.L., Farrell R.E., Bassett C.L., Aldwinckle H.S., Malnoy M. (2010). Identification of genes differentially expressed during interaction of resistant and susceptible apple cultivars (Malus X domestica) with Erwinia amylovora
BMC Plant Biology, 10, (1).
DOI: 10.1186/1471-2229-10-1
Balestrazzi A., Bonadei M., Calvio C., Mattivi F., Carbonera D. (2009).
Leaf-associated bacteria from transgenic white poplar producing resveratrol-like compounds: isolation, molecular characterization and evaluation of oxidative stress tolerance.
Canadian Journal of Microbiology, 55, (7): 829-840.

DOI: 10.1139/W09-038
Balestrazzi A., Bonadei M., Zelasco S., Giorcelli A., Gennaro M., Calligari P., Mattivi F., Quattrini E., Carbonera D. (2010).
Seasonal and tissue-specific transgene expression and resveratrol-3-glucoside (piceid) accumulation in genetically modified white poplars carrying the grapevine StSy gene.
Plant Cell, Tissue and Organ Culture
DOI: 10.1007/s11240-010-9830-5
Battilana J., Costantini L., Emanuelli F., Sevini F., Segala C., Moser S., Velasco R., Versini G., Grando M.S. (2009). The 1-deoxy-d -xylulose 5-phosphate synthase gene co-localizes with a major QTL affecting monoterpene content in grapevine.
Theoretical and Applied Genetics, 118, (4): 653-669.


DOI: 10.1007/s00122-008-0927-8

Authors From Ami to Bat
Focus on part_7 CRI Publications Report 09 / 10
93
Beer C., Ciais P., Reichstein M., Baldocchi D., Law B.E. , Papale D., Soussana J.F., Ammann C., Buchmann N., Frank D., Gianelle D., Janssens I.A., Knohl A., Kostner B., Moors E., Roupsard O., Verbeeck H., Vesala T., Williams C.A., Wohlfahrt G. (2009).
Temporal and among-site variability of inherent water use efficiency at the ecosystem level.
Global Biogeochemical Cycles, 23: GB2018.
DOI: 10.1029/2008GB003233
Bennion H., Simpson G.L., Anderson N.J., Clarke G., Dong X., Hobaek A., Guilizzoni P., Marchetto A., Sayer C.D., Thies H., Tolotti M. (2010).
Defining ecological and chemical reference conditions and restoration targets for nine European lakes.
Journal of Paleolimnology
DOI: 10.1007/s10933-010-9418-4
Bertoldi D., Bontempo L., Larcher R., Nicolini G., Voerkelius S., Lorenz G.D., Ueckermann H., Froeschl H., Baxter M.J., Hoogewerff J., Brereton P. (2010).
Survey of the chemical composition of 571 European bottled mineral waters.
Journal of Food Composition and Analysis

DOI: 10.1016/j.jfca.2010.07.005
Biasioli F., Aprea E., Gasperi F., Märk T.D. (2009).
Measuring odour emission and biofilter efficiency in composting plants by Proton Transfer Reaction-Mass Spectrometry.
Water Science & Technology, 59, (7): 1263-1269.
DOI: 10.2166/wst.2009.107
Bisognin C., Seemüller E., Citterio S., Velasco R., Grando M.S., Jarausch W. (2009). Use of SSR markers to assess sexual vs. apomictic origin and ploidy level of breeding progeny derived from crosses of apple proliferation-resistant Malus sieboldii and its hybrids with x domestica cultivars.
Plant Breeding, 128, (5): 507-513.


DOI: 10.1111/j.1439-0523.2008.01614.x
Boido E., Medina F., Medina K., Farina L., Carrau F., Versini G., Dellacassa E. (2009).
The effect of bacterial strain and aging on the secondary volatile metabolites produced during malolactic fermentation of Tannat red wine.
Journal of Agricultural and Food Chemistry, 57, (14): 6271-6278.

DOI: 10.1021/jf900941y
Bontempo L., Camin F., Larcher R., Nicolini G., Perini M., Rossmann A. (2009). Coast and year effect on H, O and C stable isotope ratios of Tyrrhenian and Adriatic Italian olive oils. Rapid Communications in Mass Spectrometry, 23, (7): 1043-1048.
DOI: 10.1002/rcm.3968
Bovolenta S., Corazzin M., Sacca E., Gasperi F., Biasioli F., Ventura W. (2009).
Performance and cheese quality of Brown cows grazing on mountain pasture fed two different levels of supplementation.
Livestock Science, 124, (1/3): 58-65.
DOI: 10.1016/j.livsci.2008.12.009
Bruno M.C., Maiolini B., Carolli M., Silveri L. (2009). Impact of hydropeaking on hyporheic invertebrates in an Alpine stream (Trentino, Italy).
Annales de Limnologie - International Journal of Limnology, 45, (3): 157-170.
DOI: 10.1051/limn/2009018
Bruno M.C., Maiolini B., Carolli M., Silveri L. (2010).
Short time-scale impacts of hydropeaking on benthic invertebrates in an Alpine stream (Trentino, Italy).
Limnologica, 40, (4): 281-290.
DOI: 10.1016/j.limno.2009.11.012
Budic-Leto I., Vrhovsek U., Gajdoš Kljusuric J., Lovric T. (2009).
J.F., Ammann C., s cosystem level. ni P., Marchetto A., mann H., y Proton Transfer breeding ybrids with ic Italian olive oils. fed two different ntino, am
Anthocyanin pattern of skin extracts from the Babic and Plavac mali grapes and anthocyanin pattern of the produced wine.
Acta Alimentaria, 38, (1): 67-75.
DOI: 10.1556/AAlim.2008.0029
Authors From Bee to Bud Focus : on part_7 CRI Publications Report 09 / 10 94
Burt G., Hauffe H.C., Searle J.B. (2009).
New metacentric population of the house mouse (Mus musculus domesticus) found in Valchiavenna, northern Italy.
Cytogenetic and Genome Research, 125, (4): 260-265.
DOI: 10.1159/000235931
Bussotti F., Pollastrini M., Cascio C., Desotgiu R., Gerosa G. , Marzuoli R., Nali C., Lorenzini G., Pellegrini
E., Carucci M.G., Salvatori E., Fusaro L., Piccotto M., Malaspina P., Manfredi A., Roccotello E., Toscano
S., Gottardini E., Cristofori A., Fini A., Weber D., Baldassarre V., Barbanti L., Monti A., Strasser R.J. (2010). Conclusive remarks. Reliability and comparability of chlorophyll fluorescence data from several field teams.
Environmental and Experimental Botany
DOI: 10.1016/j.envexpbot.2010.10.023
Cagnacci F., Boitani L., Powell R.A., Boyce M.S. (2010). Animal ecology meets GPS-based radiotelemetry: a perfect storm of opportunities and challenges.
CPhilosophical Transactions of the Royal Society B-Biological Sciences, 365, (1550): 2157-2162.

DOI: 10.1098/rstb.2010.0107
Camin F., Bontempo L., Ziller L., Piangiolino C., Morchio G. ( 2010). Stable isotope ratios of carbon and hydrogen to distinguish olive oil from shark squalene-squalane.
Rapid Communications in Mass Spectrometry, 24, (12): 1810-1816.
DOI: 10.1002/rcm.4581
Camin F., Larcher R., Nicolini G., Bontempo L., Bertoldi D., Perini M., Schlicht C., Schellenberg A., Thomas F., Heinrich K., Voerkelius S., Horacek M., Ueckermann H., Froeschl H., Wimmer B., Heiss G., Baxter M., Rossmann A., Hoogewerff J. (2010).
Isotopic and elemental data for tracing the origin of European olive oils.
Journal of Agricultural and Food Chemistry, 58, (1): 570‒577.
DOI: 10.1021/jf902814s
Camin F., Larcher R., Perini M., Bontempo L., Bertoldi D., Gagliano G., Nicolini G., Versini G. (2010). Characterisation of authentic Italian extra-virgin olive oils by stable isotope ratios of C, O and H and mineral composition.
Food Chemistry, 118, (4): 901-909.


DOI: 10.1016/j.foodchem.2008.04.059
Cappellin L., Biasioli F., Fabris A., Schuhfried E., Soukoulis C., Märk T.D., Gasperi F. (2010). Improved mass accuracy in PTR-TOF-MS: another step towards better compound identification in PTR-MS.
International Journal of Mass Spectrometry, 290, (1): 60-63.
DOI: 10.1016/j.ijms.2009.11.007
Cappellin L., Probst M., Limtrakul J., Biasioli F., Schuhfried E., Soukoulis C., Mark T.D., Gasperi F. (2010). Proton transfer reaction rate coefficients between H3O+ and some sulphur compounds.
International Journal of Mass Spectrometry, 295, (1-2): 43-48.
DOI: 10.1016/j.ijms.2010.06.023
Carletti P., Vendramin E., Pizzeghello D., Concheri G., Zanella A., Nardi S., Squartini A. (2009). Soil humic compounds and microbial communities in six spruce forests as function of parent material, slope aspect and stand age.
Plant and Soil, 315, (1-2): 47-65.
DOI: 10.1007/s11104-008-9732-z
Carpi G., Bertolotti L., Pecchioli E., Cagnacci F., Rizzoli A. (2009). Anaplasmaphagocytophilum groEL gene heterogeneity in Ixodes ricinus larvae feeding on roe deer in Northeastern Italy.
Vector-Borne and Zoonotic Diseases, 9, (2): 179-184.
DOI: 10.1089/vbz.2008.0068
B N V C D B E S C fi E D C A P D C S s R D C T B I J D C C a F D C I i I D C P I D C S m P D C A d V D
Focus
CRI Publications Report 09 / 10 95
Authors From Bur to Car
on part_7
Carpi G., Bertolotti L., Rosati S., Rizzoli A. (2009).
Prevalence and genetic variability of tick-borne Encephalitis virus in host-seeking Ixodes ricinus in Northern Italy.
Journal of General Virology, 90, (12): 2877-2883.

DOI: 10.1099/vir.0.013367-0
Carpi G., Holmes E.C., Kitchen A. (2010). The evolutionary dynamics of bluetongue virus.
Journal of Molecular Evolution, 70, (6): 583-592.
DOI: 10.1007/s00239-010-9354-y
Carra A., Mica E., Gambino G., Pindo M., Moser C., Pè M.E., Schubert A. (2009). Cloning and characterization of small non-coding RNAs from grape. The Plant Journal, 59, (5): 750-763.
DOI: 10.1111/j.1365-313X.2009.03906.x
Cavazza A., Poznanski E., Guzzon R. (2010). Must treatments and wild yeast growth before and during alcoholic fermentation.
Annals of Microbiology
DOI: 10.1007/s13213-010-0132-2
Centis B., Tolotti M., Salmaso N. (2010).


Structure of the diatom community of the river Adige (North-eastern Italy) along a hydrological gradient.
Hydrobiologia, 639, (1): 37-42.
DOI: 10.1007/s10750-009-0019-z
Chiarucci A., Bacaro G., Rocchini D., Ricotta C., Palmer M.W., Scheiner S.M. (2009). Spatially constrained rarefaction: incorporating the autocorrelated structure of biological communities into sample-based rarefaction.
Community Ecology, 10, (2): 209-214.
DOI: 10.1556/ComEc.10.2009.2.11
Chiti T., Papale D., Smith P., Dalmonech D., Matteucci G., Yeluripati J., Rodeghiero M., Valentini R. (2010). Predicting changes in soil organic carbon in mediterranean and alpine forests during the Kyoto Protocol committment periods using the CENTURY model.
Soil Use and Management, 26, (4): 475-484.
DOI: 10.1111/j.1475-2743.2010.00300.x
Costa F., Alba R., Schouten H., Soglio V., Gianfranceschi L., Serra S., Musacchi S., Sansavini S., Costa G., Fei Z.J., Giovannoni J. (2010).
Use of homologous and heterologous gene expression profiling tools to characterize transcription dynamics during apple fruit maturation and ripening.
BMC Plant Biology, 10, (229).
DOI: 10.1186/1471-2229-10-229
Costa F., Peace C.P., Stella S., Serra S., Musacchi S., Bazzani M., Sansavini S., Van De Weg W.E. (2010). QTL dynamics for fruit firmness and softening around an ethylene-dependent polygalacturonase gene in apple (Malus x domestica Borkh.).
Journal of Experimental Botany, 61, (11): 3029-3039.
DOI: 10.1093/jxb/erq130
Cottarelli V., Bruno M.C., Berera R. (2010).
First record of Parastenocarididae from Thailand and description of a new genus (Copepoda: Harpacticoida).
Journal of Crustacean Biology, 30, (3): 478-494.
DOI: 10.1651/09-3201.1
Cova V., Paris R., Passerotti S., Zini E., Gessler C., Pertot I., Loi N., Musetti R., Komjanc M. (2010). Mapping and functional analysis of four apple receptor-like protein kinases related to LRPKm1 in HcrVf2-transgenic and wild-type apple plants.
Tree Genetics & Genomes, 6, (3): 389-403.
DOI: 10.1007/s11295-009-0257-2

Authors From Car to Cov 96 Focus : on part_7 CRI Publications Report 09 / 10
Crestanello B., Pecchioli E., Vernesi C., Mona S., Martinkova N., Janiga M., Hauffe H.C., Bertorelle G. ( 2009).
The genetic impact of translocations and habitat fragmentation in chamois (Rupicapra) spp. Journal of Heredity, 100, (6): 691-708.
DOI: 10.1093/jhered/esp053
Cristofori A., Cristofolini F., Gottardini E. (2010). Twenty years of aerobiological monitoring in Trentino (Italy): assessment and evaluation of airborne pollen variability.
Aerobiologia, 26, (3): 253-261.
DOI: 10.1007/s10453-010-9161-3
Cross J., Hall D.R., Shaw P., Anfora G. (2009). Exploitation of sex pheromone of apple leaf midge Dasineura mali Kieffer (Diptera: cecidomyiidae): part 2. Use of sex pheromone traps for pest monitoring. Crop Protection, 28, (2): 128-133.
DOI: 10.1016/j.cropro.2008.09.004
Dagostin S., Formolo T., Giovannini O., Pertot I., Schmitt A. (2010). Salvia officinalis extract can protect grapevine against Plasmopara viticola. Plant Disease, 94, (5): 575-580.
DDOI: 10.1094/PDIS-94-5-0575

Dal Cin V., Barbaro E., Danesin M., Murayama H., Velasco R., Ramina A. (2009). Fruitlet abscission: a cDNA-AFLP approach to study genes differentially expressed during shedding of immature fruits reveals the involvement of a putative auxin hydrogen symporter in apple (Malus domestica L. Borkh).
Gene, 442, (1/2): 26-36.
DOI: 10.1016/j.gene.2009.04.009
Dal Cin V., Velasco R., Ramina A. (2009).
Dominance induction of fruitlet shedding in Malus x domestica (L. Borkh): molecular changes associated with polar auxin transport.
BMC Plant Biology, 9, (139)
DOI: 10.1186/1471-2229-9-139
Dalla Costa L., Vaccari I., Mandolini M., Martinelli L. (2009). Elaboration of a reliable strategy based on real-time PCR to characterize genetically modified plantlets and to evaluate the efficiency of a marker gene removal in grape (Vitis spp.).
Journal of Agricultural and Food Chemistry, 57, (7): 2668‒2677.

DOI: 10.1021/jf802740m
Dalla Costa L., Mandolini M., Poletti V., Martinelli L. (2010). Comparing 17-B-estradiol supply strategies for applying the XVE-Cre/loxP ssystem in grape gene transfer (Vitis vinifera L.).
Vitis, 49, (4): 201-208.
http://www.jki.bund.de/de/startseite/veroeffentlichungen/vitis.html


Dalponte M., Bruzzone L., Vescovo L., Gianelle D. (2009). The role of spectral resolution and classifier complexity in the analysis of hyperspectral images of forest areas.
Remote Sensing of Environment, 113, (11): 2345-2355.
DOI: 10.1016/j.rse.2009.06.013
Degirmenci D., Kunter B., Coppola G., Velasco R. (2010). Analysis of polymorphism based on SSCP markers in gamma-irradiated (Co60) grape (Vitis vinifera ) varieties.
GMR Genetics and Molecular Research, 9, (4): 2357-2363.
DOI: 10.4238/vol9-4gmr864
Authors From Cre to Deg 97 Focus on part_7 CRI Publications Report 09 / 10
De Michele R., Formentin E., Todesco M., Toppo S., Carimi F., Zottini M., Barizza E., Ferrarini A., Delledonne M., Fontana P., Lo Schiavo F. (2009).
Transcriptome analysis of Medicago truncatula leaf senescence: similarities and differences in metabolic and transcriptional regulations as compared with Arabidopsis, nodule senescence and nitric oxide signalling.
New Phytologist, 181, (3): 563-575.


DOI: 10.1111/j.1469-8137.2008.02684.x
DellʼAnna R., Lazzeri P., Frisanco M., Monti F., Malvezzi Campeggi F., Gottardini E., Bersani M. (2009). Pollen discrimination and classification by Fourier transform infrared (FT-IR) microspectroscopy and machine learning.
Analytical & Bioanalytical Chemistry, 394, (5): 1443-1452.
DOI: 10.1007/s00216-009-2794-9
Di Marino E., Montecchio L., Scattolin L., Abs C., Agerer R. (2009). The ectomycorrhizal community structure in European beech forests differing in coppice shoot age and stand features.
Journal of Forestry, 107, (5): 250-259.
Eccel E., Rea R., Caffarra A., Crisci A. (2009).
Risk of spring frost to apple production under future climate scenarios: the role of phenological acclimation.
International Journal of Biometeorology, 53, (3): 273-286.
DOI: 10.1007/s00484-009-0213-8
Emanuelli F., Battilana J., Costantini L., Le Cunff L., Boursiquot J.M., This P., Grando M.S. (2010). A candidate gene association study on muscat flavor in grapevine (Vitis vinifera L.).
BMC Plant Biology, 10, (241).

DOI: 10.1186/1471-2229-10-241
Endrizzi I., Pirretti G., Caló D.G., Gasperi F. (2009). A consumer study of fresh juices containing berry fruits.
Journal of the Science of Food and Agriculture, 89, (7): 1227-1235.
DOI: 10.1002/jsfa.3580
Endrizzi I., Gasperi F., Calo D.G., Vigneau E. (2010). Two-step procedure for classifying consumers in a L-structured data context. Food Quality and Preference, 21, (3): 270-277.
DOI: 10.1016/j.foodqual.2009.06.004
Fabris A., Biasioli F., Granitto P.M., Aprea E., Cappellin L., Schuhfried E., Soukoulis C., Märk T.D., Gasperi F., Endrizzi I. (2010).
PTR-TOF-MS and data-mining methods for rapid characterisation of agro-industrial samples: influence of milk storage conditions on the volatile compounds profile of Trentingrana cheese.
Journal of Mass Spectrometry, 45, (9): 1065-1074.
DOI: 10.1002/jms.1797
Fairchild I.J., Loader N.J., Wynn P.M., Frisia S., Thomas P.A. , Lageard J.G.A., De Momi A., Hartland A., Borsato A., La Porta N., Susini J. (2009).
Sulfur fixation in wood mapped by synchrotron X-ray studies: implications for environmental archives.
Environmental Science & Technology, 43, (5): 1310-1315.
DOI: 10.1021/es8029297
Fasolato L., Novelli E., Salmaso L., Corain L., Camin F., Perini M., Antonetti P., Balzan S. (2010). Application of nonparametric multivariate analyses to the authentication of wild and farmed European sea bass ( Dicentrarchus labrax). Results of a survey on fish sampled in the retail trade.
Journal of Agricultural and Food Chemistry, 58, (20): 10979-10988.
DOI: 10.1021/jf1015126
Fedrizzi B., Magno F., Finato F., Versini G. (2010). Variation of some fermentative sulfur compounds in Italian “Millesime” classic sparkling wines during aging and storage on lees.
Journal of Agricultural and Food Chemistry, 58, (17): 9716-9722.
DOI: 10.1021/jf101478w
Authors From De to Fed
Focus : on part_7 CRI Publications
Report 09 / 10 98
Ferrari N., Cattadori I., Rizzoli A., Hudson P.J. (2009). Heligmosomoides polygyrus reduces infestation of Ixodes ricinus in free-living yellow-necked mice, Apodemus flavicollis Parasitology, 136, (3): 305-316.
DOI: 10.1017/S0031182008005404
Ferrari N., Rosà R., Lanfranchi P., Ruckstuhl K.E. (2010).
Effect of sexual segregation on host-parasite interaction: model simulation for abomasal parasite dynamics in alpine ibex (Capra ibex).
International Journal for Parasitology, 40, (11): 1285-1293.
DOI: 10.1016/j.ijpara.2010.03.015
Ferrarini R., Casarotti E.M., Zanella G., Mattivi F. (2009). White grape extended skin contact winemaking technique.
American Journal of Enology and Viticulture, 60, (3): 399A.
http://www.ajevonline.org/cgi/reprint/60/3/386A
Ferrarini R., Nicolis E., Furlan E., Zanella G., Mattivi F. (2009). First crushing experiences in an inert environment.
American Journal of Enology and Viticulture, 60, (3): 399A.

http://www.ajevonline.org/cgi/reprint/60/3/386A
Flaim G., Rott E., Frassanito R., Guella G., Obertegger U. (2010). Eco-fingerprinting of the dinoflagellate Borghiella dodgei: experimental evidence of a specific environmental niche.
Hydrobiologia, 639, (1): 85-98.
DOI: 10.1007/s10750-009-0013-5
Focardi S., Montanaro P., Pecchioli E. (2009). Adaptive levy walks in foraging fallow deer.
PLoS ONE, 4, (8)
DOI: 10.1371/journal.pone.0006587
Fontana P., Cestaro A., Velasco R., Formentin E., Toppo S. (2009). Rapid annotation of anonymous sequences from genome projects using semantic similarities and a weighting scheme in gene ontology.
PLoS ONE, 4, (2): e4619.

DOI: 10.1371/journal.pone.0004619
Fontanesi L., Forestier L., Allain D., Scotti E., Beretti F., Deretz-Picoulet S., Pecchioli E., Vernesi C., Robinson T.J., Malaney J.L., Russo V., Oulmouden A. (2010). Characterization of the rabbit agouti signaling protein (ASIP) gene: transcripts and phylogenetic analyses and identification of the causative mutation of the nonagouti black coat colour.
Genomics, 95, (3): 166-175.
DOI: 10.1016/j.ygeno.2009.11.003
Frair J.L., Fieberg J., Hebblewhite M., Cagnacci F., Decesare N.J., Pedrotti L. (2010). Resolving issues of imprecise and habitat-biased locations in ecological analyses using GPS telemetry data.
Philosophical Transactions of the Royal Society B-Biological Sciences, 365, (1550): 2187-2200.
DOI: 10.1098/rstb.2010.0084
Franciosi E., Pecile A., Cavazza A., Poznanski E. (2009).
Microbiological monitoring of raw milk from selected farm in the Trentingrana region. Italian Journal of Animal Science, 8, (suppl. 2): 408-410. http://ijas.pagepress.org/index.php/ijas/article/view/ijas.2009.s2.408/457
Authors From Fer to Fra Focus on part_7 CRI Publications Report 09 / 10 99
Franciosi E., Settanni L., Cavazza A., Poznanski E. (2009). Biodiversity and technological potential of wild lactic acid bacteria from raw cowsʼ milk.
International Dairy Journal, 19, (1): 3-11.

DOI: 10.1016/j.idairyj.2008.07.008
Franciosi E., Settanni L., Cavazza A., Poznanski E. (2009). Presence of enterococci in raw cowʼs milk and “Puzzone di Moena” cheese. Journal of Food Processing and Preservation, 33, (2): 204-217.
DOI: 10.1111/j.1745-4549.2008.00262.x
Franciosi E., Settanni L., Cologna N., Cavazza A., Poznanski E. (2010). Microbial analysis of raw cowsʼ milk used for cheese-making: influence of storage treatments on microbial composition and other technological traits.
World Journal of Microbiology and Biotechnology
DOI: 10.1007/s11274-010-0443-2
Frasnelli E., Anfora G., Trona F., Tessarolo F., Antolini R., Vallortigara G. (2009). Morfo-functional asymmetry of the olfactory receptors of the honeybee Apis mellifera L. European Biophysics Journal, 38, (1 (suppl.)): P-155.
DOI: 10.1016/j.bbr.2010.01.046
Frasnelli E., Anfora G., Trona F., Tessarolo F., Vallortigara G. (2010). Morpho-functional asymmetry of the olfactory receptors of the honeybee (Apis mellifera). Behavioural Brain Research, 209, (2): 221-225 .
DOI: 10.1016/j.bbr.2010.01.046
Fronzoni G., Stener M., Decleva P., De Simone M., Coreno M., Franceschi P., Furlani C., Prince K.C. (2009). X-ray absorption spectroscopy of VOCl3, CrO2Cl2, and MnO3Cl: an experimental and theoretical study.
Journal of Physical Chemistry A, 113, (12): 2914-2925.

DOI: 10.1021/jp808720z
Gago P., Santiago J.L., Boso S., Alonso-Villaverde V., Grando M.S., Martinez M.C. (2009). Biodiversity and characterization of twenty-two Vitis vinifera L. cultivars in the Northwestern Iberian peninsula.
American Journal of Enology and Viticulture, 60, (3): 293-301.
http://www.ajevonline.org/cgi/reprint/60/3/293
Gamon J.A., Coburn C., Flanagan L.B., Huemmrich K.F., Kiddle C., Sanchez-Azofeifa G.A., Thayer D.R., Vescovo L., Gianelle D., Sims D.A., Rahman A.F., Pastorello G.Z. (2010).
SpacNet revisited: bridging flux and remote sensing communities. Canadian Journal of Remote Sensing, 36, (S2): 376-390.
Gasperi F., Aprea E., Biasioli F., Carlin S., Endrizzi I. , Pirretti G., Spilimbergo S. (2009).
Effects of supercritical CO2 and N2O pasteurisation on the quality of fresh apple juice. Food Chemistry, 115, (1): 129-136.
DOI: 10.1016/j.foodchem.2008.11.078
Gasperotti M., Masuero D., Vrhovsek U., Guella G., Mattivi F. (2010). Profiling and accurate quantification of Rubus ellagitannins and ellagic acid conjugates using direct UPLC-Q-TOF HDMS and HPLC-DAD analysis.
Journal of Agricultural and Food Chemistry, 58, (8): 4602-4616.
DOI: 10.1021/jf904543w
Gazzani S., Li M., Maistri S., Scarponi E., Graziola M., Barbaro E., Wunder J., Furini A., Saedler H., Varotto C. (2009).
Evolution of MIR168 paralogs in Brassicaceae.
BMC Evolutionary Biology, 9, (62)
DOI: 10.1186/1471-2148-9-62
Gentile G., Vernesi C., Vicario S., Pecchioli E., Caccone A., Bertorelle G., Sbordoni V. (2009). Mitochondrial DNA variation in roe deer (Capreoluscapreolus) from Italy: evidence of admixture in one of the last C. c. italicus pure populations from central-southern Italy.
Italian Journal of Zoology, 76, (1): 16-27.
DOI: 10.1080/11250000802018725
Authors From Fra to Gen
Focus : on part_7 CRI Publications Report 09 / 10
100
Gentili R., Abeli T., Rossi G., Li M., Varotto C., Sgorbati S. (2010). Population structure and genetic diversity of the threatened quillwort Isoëtes malinverniana and implication for conservation.
Aquatic Botany, 93, (3): 147-152.

DOI: 10.1016/j.aquabot.2010.05.003

Geri F., Amici V., Rocchini D. (2010). Human activity impact on the heterogeneity of a Mediterranean landscape. Applied Geography, 30, (3): 370-379.
DOI: 10.1016/j.apgeog.2009.10.006
Geri F., Rocchini D., Chiarucci A. (2010).
Landscape metrics and topographical determinants of large-scale forest dynamics in a Mediterranean landscape.
Landscape and Urban Planning, 95, (1-2): 46-53.
DOI: 10.1016/j.landurbplan.2009.12.001
Gianelle D., Vescovo L., Marcolla B., Manca G., Cescatti A. (2009).
Ecosystem carbon fluxes and canopy spectral reflectance of a mountain meadow.
International Journal of Remote Sensing, 30, (2): 435-449.
DOI: 10.1080/01431160802314855
Gianelle D., Vescovo L., Mason F. (2009). Estimation of grassland biophysical parameters using hyperspectral reflectance for fire risk map prediction.
International Journal of Wildland fire, 18, (7): 815-824.
DOI: 10.1071/WF08005
Gianelle D., Oechel W.C., Miglietta F., Rodeghiero M., Sottocornola M. (2010). Cataloguing soil carbon stocks. Science, 330, (6010): 1476-1477.
DOI: 10.1126/science.330.6010.1476-c
Gill C.I.G., McDougall G., Glidewell S., Stewart D., Shen Q., Tuohy K., Dobbin A., Boyd A., Brown E., Haldar S., Rowland I.R. (2010).
Profiling of phenols in human fecal water after raspberry supplementation. Journal of Agricultural and Food Chemistry, 58, (19): 10389‒10395.
DOI: 10.1021/jf1017143
Gilmanov T.G., Aires L., Barcza Z., Baron V.S., Belelli L. , Beringer J., Billesbach D., Bonal D., Bradford J., Ceschia E., Cook D., Corradi C., Frank A., Gianelle D., Gimeno C., Gruenwald T., Guo H., Hanan N., Haszpra L., Heilman J., Jacobs A., Jones M.B., Johnson D.A., Kiely G., Li S., Magliulo V., Moors E., Nagy Z., Nasyrov M., Owensby C., Pinter K., Pio C., Reichstein M., Sanz M.J., Scott R., Soussana J.F., Stoy P.C., Svejcar T., Tuba Z., Zhou G. (2010).
Productivity, respiration and light-response parameters of world grassland and agroecosystems derived from flux-tower measurements.
Rangeland Ecology & Management , 63, (1): 16-39.
DOI: 10.2111/REM-D-09-00072.1
Goremykin V., Moser C. (2009).
Classification of the Arabidopsis ERF gene family based on bayesian inference. Molecular Biology, 43, (5): 729-734.
DOI: 10.1134/S0026893309050045
Goremykin V., Salamini F., Velasco R., Viola R. (2009). Mitochondrial DNA of Vitis vinifera and the issue of rampant horizontal gene transfer. Molecular Biology and Evolution, 26, (1): 99-110.

DOI: 10.1093/molbev/msn226
Goremykin V., Viola R., Hellwig F.H. (2009). Removal of noisy characters from chloroplast genome-scale data suggests revision of phylogenetic placements of Amborella and Ceratophyllum
Journal of Molecular Evolution, 68, (3): 197-204.
DOI: 10.1007/s00239-009-9206-9
Authors From Gen to Gor Focus on part_7 CRI Publications Report 09 / 10
101
Goremykin V., Nikiforova S.V., Bininda-Emonds O.R.P. (2010). Automated removal of noisy data in phylogenomic analyses.
Journal of Molecular Evolution , 71, (5-6): 319-331.
DOI: 10.1007/s00239-010-9398-z
Gottardini E., Cristofolini F., Cristofori A., Vannini A., Ferretti M. (2009). Sampling bias and sampling errors in pollen counting in aerobiological monitoring in Italy.
Journal of Environmental Monitoring, 11, (4): 751-755.
DOI: 10.1039/b818162b
Gottardini E., Cristofori A., Cristofolini F., Bussotti F., Ferretti M. (2010). Responsiveness of ViburnumlantanaL.to tropospheric ozone: field evidence under contrasting site conditions in Trentino, northern Italy.
Journal of Environmental Monitoring, 12, (12): 2237-2243.
DOI: 10.1039/c0em00299b
Gottardini E., Cristofori A., Cristofolini F., Ferretti M. (2010). Variability of ozone concentration in a montane environment, northern Italy. Atmospheric Environment, 44, (2): 147-152.
DOI: 10.1016/j.atmosenv.2009.10.017
Guimaraes S., Ghirotto S., Benazzo A., Milani L., Lari M., Pilli E., Pecchioli E., Mallegni F., Lippi B., Bertoldi F., Gelichi S., Casoli A., Belle E.M.S., Caramelli D., Barbujani G. (2009). Genealogical discontinuities among Etruscan, Medieval, and contemporary Tuscans. Molecular Biology and Evolution, 26, (9): 2157-2166.
DOI: 10.1093/molbev/msp126
Guzzon R., Poznanski E., Conterno L., Vagnoli P., Krieger-Weber S., Cavazza A. (2009). Selection of a new highly resistant strain for malolactic fermentation under difficult conditions.
South African Journal of Enology and Viticolture, 30, (2): 133-141.



Hauffe H.C., Gimenez M.D., Garagna S., Searle J.B. (2010).
First wild XXY house mice.
Chromosome Research, 18, (5): 599-604.

DOI: 10.1007/s10577-010-9135-x
HHauffe H.C., Niklasson B., Olsson T., Bianchi A.1., Rizzoli A., Klitz W. (2010). Ljungan virus detected in bank voles (Myodes glareolus) and yellow-necked mice (Apodemus flavicollis) from Northern Italy.
Journal of Wildlife Diseases, 46, (1): 262-266.
Ioriatti C., Anfora G., Angeli G., Mazzoni V., Trona F. ( 2009). Effects of chlorantraniliprole on eggs and larvae of Lobesia botrana (Denis & Schiffermüller) (Lepidoptera: Tortricidae).
Pest Management Science, 65, (6): 717-722.
DOI: 10.1002/ps.1744
Ioriatti C., Anfora G., Civolani S., Schmidt S., Pasqualini E. (2009).
Toxicity of emamectin benzoate to Cydiapomonella(L.) and Cydiamolesta(Busck) (Lepidoptera: Tortricidae): laboratory and field tests.
Pest Management Science, 65, (3): 306-312.
DOI: 10.1002/ps.1689
Jung M., Reichstein M., Ciais P., Seneviratne S.I., Sheffield J., Goulden M.L., Bonan G., Cescatti A., Chen J., De Jeu R., Dolman A.J., Eugster W., Gerten D., Gianelle D., Gobron N., Heinke J., Kimball J., Law B.E., Montagnani L., Mu Q., Mueller B., Oleson K., Papale D., Richardson A.D., Roupsard O., Running S., Tomelleri E., Viovy N., Weber U., Williams C., Wood E., Zaehle S., Zhang K. (2010). Recent decline in the global land evapotranspiration trend due to limited moisture supply.
Nature, 467, (7319): 951-954.
DOI: 10.1038/nature09396
Koehler A.K., Murphy K., Kiely G., Sottocornola M. (2009).
KSeasonal variation of DOC concentration and annual loss of DOC from an Atlantic blanket bog in south western Ireland.
Biogeochemistry, 95, (1): 231-242.
DOI: 10.1007/s10533-009-9333-9
Authors
From Gor to Koe
Focus : on part_7 CRI Publications
Report 09 / 10 102
Kie J.G., Matthiopoulos J., Fieberg J., Powell R.A., Cagnacci F., Mitchell M.S., Gaillard J.M., Moorcroft P.R. (2010).
The home-range concept: are traditional estimators still relevant with modern telemetry technology?
Philosophical Transactions of the Royal Society B-Biological Sciences, 365, (1550): 2221-2231.

DOI: 10.1098/rstb.2010.0093
Kuflik T., Prodorutti D., Frizzi A., Gafni Y., Simon S., Pertot I. (2009). Optimization of copper treatments in organic viticulture by using a web-based decision support system.
Computers and Electronics in Agriculture, 68, (1): 36-43.
DOI: 10.1016/j.compag.2009.04.008
Lavagnini I., Fedrizzi B., Versini G., Magno F. (2009).
LEffectiveness of isotopically labelled and non-isotopically labelled internal standards in the gas chromatography/mass spectrometry analysis of sulfur compounds in wines: use of a statistically based matrix comprehensive approach.
Rapid Communications in Mass Spectrometry, 23, (8): 1167-1172.
DOI: 10.1002/rcm.3964
Lazzari B., Caprera A., Cestaro A., Merelli I., Del Corvo M., Fontana P., Milanesi L., Velasco R., Stella A. (2009).
Ontology-oriented retrieval of putative microRNAs in Vitis vinifera via GapeMiRNA: a web database of de novo predicted grape microRNAs.
BMC Plant Biology, 9, (82)
DOI: 10.1186/1471-2229-9-82
Longa Oliveira C.M., Pertot I. (2009). An intact soil-core microcosm method to evaluate the survival and vertical dispersal of Trichoderma atroviride Sc1.
Letters in Applied Microbiology, 49, (5): 609-614.

DOI: 10.1111/j.1472-765X.2009.02715.x
Longa Oliveira C.M., Savazzini F., Tosi S., Elad Y., Pertot I. (2009). Evaluating the survival and environmental fate of the biocontrol agent Trichoderma atroviride SC1 in vineyards in Northern Italy.
Journal of Applied Microbiology, 106, (5): 1549-1557.
DOI: 10.1111/j.1365-2672.2008.04117.x
Longhi S., Cristofori A., Gatto P., Cristofolini F., Grando M.S., Gottardini E. (2009). Biomolecular identification of allergenic pollen: a new perspective for aerobiological monitoring?
Annals of Allergy, Asthma and Immunology, 103, (6): 508-514.
DOI: 10.1016/S1081-1206(10)60268-2
Luong L.T., Perkins S.E., Grear D.A., Rizzoli A., Hudson P.J. (2010). The relative importance of host characteristics and co-infection in generating variation in Heligmosomoides polygyrus fecundity.
Parasitology, 137, (6): 1003-1012.
DOI: 10.1017/S0031182009991892
Lücker J., Martens S., Lund S.T. (2010).
Characterization of a Vitis vinifera cv. Cabernet Sauvignon 3ʼ, 5ʼ-O-methyltransferase showing strong preference for anthocyanins and glycosylated flavonols.
Phytochemistry, 71, (13): 1474-1484.

DOI: 10.1016/j.phytochem.2010.05.027
Malagnini V., Pedrazzoli F., Gualandri V., Forno F., Zasso R., Pozzebon A., Ioriatti C. (2010).
A study of the effects of Candidatus Phytoplasma mali on the psyllid Cacopsylla melanoneura (Hemiptera: Psyllidae).
Journal of Invertebrate Pathology, 103, (1): 65-67.
DOI: 10.1016/j.jip.2009.11.005
From
to Mal M Focus on part_7 CRI Publications
Authors
Kie
Report 09 / 10 103
Malagnini V., Pedrazzoli F., Gualandri V., Zasso R., Bozza E., Fiamingo F., Pozzebon A., Mori N., Ioriatti C. (2010). Detection of Candidatus phytoplasma mali in different populations of Cacopsyllamelanoneura in Italy.
Bulletin of Insectology, 63, (1): 59-63.
http://www.bulletinofinsectology.org/pdfarticles/vol63-2010-059-063malagnini.pdf
Malnoy M., Borejsza-Wysocka E.E., Norelli J.L., Flaishman M., Gidoni D., Aldwinckle H. (2010). Genetic transformation of apple (Malus x domestica) without use of a selectable marker gene.
Tree Genetics & Genomes, 6, (3): 423-433.





DOI: 10.1007/s11295-009-0260-7
Marchi G., Burruano S., Di Marco S., Osti F., Pertot I., Surico G. (2009). Spatial pattern analysis of esca in different geographical areas of Italy.
Phytopathologia Mediterranea, 48, (1, special issue): 175.



http://ejour-fup.unifi.it/index.php/pm/article/viewFile/2887/2573
Mariz C., Gianelle D., Bruzzone L., Vescovo L. (2009). Fusion of multi-spectral SPOT-5 images and very high resolution texture information extracted from digital orthophotos for automatic classification of complex Alpine areas.
International Journal of Remote Sensing, 30, (11): 2859-2873.
DOI: 10.1080/01431160802558600
Martens S., Preuss A., Matern U. (2010). Multifunctional flavonoid dioxygenases: flavonol and anthocyanin biosynthesis in Arabidopsis thaliana.
Phytochemistry, 71, (10): 1040-1049.
DOI: 10.1016/j.phytochem.2010.04.016
Mattivi F., Vrhovsek U., Masuero D., Trainotti D. (2009).
Differences in the amount and structure of extractable skin and seed tannins amongst red grape varieties.
Australian Journal of Grape and Wine Research, 15, (1): 27-35.
DOI: 10.1111/j.1755-0238.2008.00027.x
Mazzoni V., Ioriatti C., Trona F., Lucchi A., De Cristofaro A., Anfora G. (2009). Study on the role of olfaction in host plant detection of Scaphoideus titanus (Hemiptera: Cicadellidae) nymphs.
Journal of Economic Entomology, 102, (3): 974-980.
DOI: 10.1603/029.102.0316
Mazzoni V., Lucchi A., Cokl A., Presern J., Virant-Doberlet M. (2009). Disruption of the reproductive behaviour of Scaphoideustitanus by playback of vibrational signals. Entomologia Experimentalis et Applicata, 133, (2): 174-185.
DOI: 10.1111/j.1570-7458.2009.00911.x
Mazzoni V., Presern J., Lucchi A., Virant-Doberlet M. (2009).
Reproductive strategy of the Nearctic leafhopper ScaphoideustitanusBall (Hemiptera: Cicadellidae).

Bulletin of Entomological Research, 99, (4): 401-413.
DOI: 10.1017/S0007485308006408
Mazzoni V., Lucchi A., Ioriatti C., Virant-Doberlet M., Anfora G. (2010). Mating behavior of Hyalesthes obsoletus (Hemiptera: Cixiidae).
Annals of the Entomological Society of America, 103, (5): 813-822.
DOI: 10.1603/AN09145
Molinari F., Anfora G., Schmidt S., Villa M., Ioriatti C., Pasqualini E., De Cristofaro A. (2010). Olfactory activity of ethyl (E,Z)-2,4-decadienoate on adult oriental fruit moths. The Canadian Entomologist, 142, (5): 481-488.
DOI: 10.4039/n10-016
Mona S., Catalano G., Lari M., Larson G., Boscato P., Casoli A., Sineo L., Di Patti C., Pecchioli E., Caramelli D., Bertorelle G. (2010).
Population dynamic of the extinct european aurochs: genetic evidence of a north-south differentiation pattern and no evidence of post-glacial expansion.
BMC Evolutionary Biology, 10, (83)
http://www.biomedcentral.com/1471-2148/10/83
Authors From Mal to Mon Focus : on part_7 CRI Publications Report 09 / 10 104
Nagendra H., Rocchini D., Ghate R. (2010).
Beyond parks as monoliths: Spatially differentiating park-people relationships in the Tadoba Andhari Tiger Reserve in India.
Biological Conservation, 143: 2900-2908.
DOI: 10.1016/j.biocon.2010.04.050
NNagendra H., Rocchini D., Ghate R., Sharma B., Pareeth S. (2010) Assessing biodiversity in a dry tropical forest: comparing the utility of Landsat and Ikonos satellite images.
Remote Sensing, 2, (2): 478-496.
DOI: 10.3390/rs2020478
Nardini M., Forte M., Vrhovsek U., Mattivi F., Viola R., Scaccini C. (2009). White wine phenolic are absorbed and extensively metabolized in humans.
Journal of Agricultural and Food Chemistry, 57, (7): 2711‒2718.
DOI: 10.1021/jf8034463
Neteler, M. (2010).
Estimating daily Land Surface Temperatures in mountainous environments by reconstructed MODIS LST data.
Remote Sensing, 2,(1): 333-351.
DOI: 10.3390/rs1020333
Obertegger U., Borsato A., Flaim G. (2010).
Rotifer-crustacean interactions in a pseudokarstic lake: influence of hydrology.
OAquatic Ecology, 44, (1): 121-130.

DOI: 10.1007/s10452-009-9285-0
Obertegger U., Thaler B., Flaim G. (2010). Rotifer species richness along an altitudinal gradient in the Alps.
Global Ecology and Biogeography, 19, (6): 895-904.
DOI: 10.1111/j.1466-8238.2010.00556.x
Paris R., Cova V., Pagliarani G., Tartarini S., Komjanc M., Sansavini S. (2009 ). Expression profiling in HcrVf2-transformed apple plants in response to Venturia inaequalis.
PTree Genetics & Genomes, 5, (1): 81-91.





DOI: 10.1007/s11295-008-0177-6
Paternoster T., Vrhovsek U., Pertot I., Duffy B., Gessler C., Mattivi F. (2009). Determination and confirmation of nicotinic acid and its analogues and derivates in pear and apple blossoms using high-performance liquid chromatography-diode array-electrospray ionization mass spectrometry.

Journal of Agricultural and Food Chemistry, 57, (21): 10038-10043.


DOI: 10.1021/jf902342b
Patocchi A., Fernandez-Fernandez F., Evans K., Gobbin D., Rezzonico F., Boudichevskaja A., Dunemann F., Stankiewicz-Kosyl M., Mathis-Jeanneteau F., Durel C.E., Gianfranceschi L., Costa F., Toller C., Cova V., Mott D., Komjanc M., Barbaro E., Kodde L., Rikkerink E., Gessler C., Van De Weg W.E. (2009).
Development and test of 21 multiplex PCRs composed of SSRs spanning most of the apple genome.

Tree Genetics & Genomes, 5, (1): 211-223.
DOI: 10.1007/s11295-008-0176-7
Pedron L., Baldi P., Hietala A.M., La Porta N. (2009).
Genotype-specific regulation of cold-responsive genes in cypress (Cupressus sempervirens L.).
Gene , 437, (1-2): 45-53.
DOI: 10.1016/j.gene.2008.12.012
Pellegrini A.1., Prodorutti D., Frizzi A., Gessler C., Pertot I. (2010).
Development and evaluation of a warning model for the optimal use of copper in organic viticulture.
Journal of Plant Pathology, 92, (1): 43-55.
Authors From Nag to Pel
Focus on part_7 CRI Publications
Report 09 / 10 105
Penna A., Fraga S., Battocchi C., Casabianca S., Giacobbe M.G., Riobo P., Vernesi C. (2010). A phylogeographical study of the toxic benthic dinoflagellate genus ostreopsis Schmidt.
Journal of Biogeography, 37, (5): 830-841.
DOI: 10.1111/j.1365-2699.02265.x
Perazzolli M., Bampi F., Faccin S., Moser M., De Luca F., Ciccotti A.M., Velasco R., Gessler C., Pertot I., Moser C. (2010).
Armillaria mellea induces a set of defense genes in grapevine roots and one of them codifies a protein with antifungal activity.
Molecular Plant-Microbe Interactions, 23, (4): 485-496.
DOI: 10.1094/MPMI-23-4-0485
Perini M., Camin F., Bontempo L., Rossmann A., Piasentier E. (2009). Multielement (H, C, N, O, S) stable isotope characteristics of lamb meat from different Italian regions.
Rapid Communications in Mass Spectrometry, 23, (16): 2573-2585.




DOI: 10.1002/rcm.4140
Perini M., Camin F., Corradini F., Obertegger U., Flaim G. (2009). Use of δ18O in the interpretation of hydrological dynamics in lakes.
Journal of Limnology, 68, (2): 174-182.
DOI: 10.3274/JL09-68-2-02
Pertot ifies a egions.
Perkins S.E., Cagnacci F., Stradiotto A., Arnoldi D., Hudson P.J. (2009). Comparison of social networks derived from ecological data: implications for inferring infectious disease dynamics.
Journal of Animal Ecology, 78, (5): 1015-1022.
DOI: 10.1111/j.1365-2656.2009.01557.x
Poni S., Bernizzoni F., Civardi S., Gatti M., Porro D., Camin F. (2009). Performance and water-use efficiency (single-leaf vs. whole-canopy) of well-watered and halfstressed split-root Lambrusco grapevines grown in Po valley (Italy).
Agriculture Ecosystems & Environment, 129, (1-3): 97-106.
DOI: 10.1016/j.agee.2008.07.009
Prodorutti D., De Luca F., Michelon L., Pertot I. (2009).
and halfafted onto
Susceptibility to Armillaria mellea root rot in grapevine rootstocks commonly grafted onto Teroldego Rotaliano.
Phytopathologia Mediterranea, 48, (2): 285-290.
http://ejour-fup.unifi.it/index.php/pm/article/viewFile/2738/2843
Prodorutti D., Vanblaere T., Gobbin D., Pellegrini A.1., Gessler C., Pertot I. (2009). Genetic diversity of Armillaria spp. infecting highbush blueberry in Northern Italy (Trentino region).
Phytopathology, 99, (6): 651-658.
DOI: 10.1094/PHYTO-99-6-0651
Rapisarda P., Camin F., Fabroni S., Perini M., Torrisi B., Intrigliolo F. (2010).
Influence of different organic fertilizers on quality parameters and the delta N-15, delta C-13, delta H-62, delta S-34, and delta O-18 values of orange fruit (Citrus sinensis L. Osbeck).
Journal of Agricultural and Food Chemistry, 58, (6): 3502-3506.
DOI: 10.1021/jf903952v
Ricotta C., Godefroid S., Rocchini D. (2010).
Invasiveness of alien plants in Brussels is related to their phylogenetic similarity to native species. Diversity and Distribution, 16, (4): 655-662.
DOI: 10.1111/j.1472-4642.2010.00676.x
Rizzoli A., Hauffe H.C., Tagliapietra V., Neteler M., Rosà R. (2009).
Forest structure and roe deer abundance predict tick-borne encephalitis risk in Italy. PLoS ONE, 4, (2): e4336.
DOI: 10.1371/journal.pone.0004336
Rocchini, D. (2010).
Ecological status and change by remote sensing - Editorial. Remote Sensing, 2: 2424-2425.
DOI: 10.3390/rs2102424
Authors From Pen to Roc
Focus : on part_7 CRI Publications Report 09 / 10
106
Rocchini D., Vannini A. (2010).
What is up? Testing spectral heterogeneity versus NDVI relationship using quantile regression.
International Journal of Remote Sensing, 31, (10): 2745-2756.
DOI: 10.1080/01431160903085651
Rocchini D., He K.S., Oldeland J., Wesuls D., Neteler M. (2010) Spectral variation versus species ß-diversity at different spatial scales: a test in African highland savannas.
Journal of Environmental Monitoring, 12, (4): 825-831.

DOI: 10.1039/b921835a
Rocchini D., Balkenhol N., Carter G., Foody G.M., Gillespie T.W., He K.S., Kark S., Levin N., Lucas K., Luoto M., Nagendra H., Oldeland J., Ricotta C., Southworth J., Neteler M. (2010). Remotely sensed spectral heterogeneity as a proxy of species diversity: recent advances and open challenges.
Ecological Informatics, 5, (5): 318-329.
DOI: 10.1016/j.ecoinf.2010.06.001
Rodeghiero M., Tonolli S., Vescovo L., Gianelle D., Cescatti A., Sottocornola M. (2010).
INFOCARB: a regional scale forest carbon inventory (Provincia Autonoma di Trento, southern italian Alps).
Forest Ecology and Management, 259, (6): 1093-1101.
DOI: 10.1016/j.foreco.2009.12.019
Roiz D., Vazquez A., Seco M.P.S., Tenorio A., Rizzoli A. (2009).
Detection of novel insect flavivirus sequences integrated in Aedes albopictus (Diptera: Culicidae) in Northern Italy.
Virology Journal, 6, (93)
DOI: 10.1186/1743-422X-6-93
Roiz D., Rosà R., Arnoldi D., Rizzoli A. (2010).
Effects of temperature and rainfall on the activity and dynamics of host-seeking Aedes albopictus females in Northern Italy.
Vector-Borne and Zoonotic Diseases, 10, (8): 811-816.
DOI: 10.1089/vbz.2009.0098
Rotter A., Camps C., Lohse M., Kappel C., Pilati S., Hren M., Stitt M., Coutos-Thévenot, Moser C., Usadel B., Delrot S., Gruden K. (2009).
Gene expression profiling in susceptibile interaction of grapevine with its fungal pathogen Eutypa lata: extending MapMan ontology for grapevine.
BMC Plant Biology, 9, (104)
DOI: 10.1186/1471-2229-9-104
SSalmaso N. (2010).
Long-term phytoplankton community changes in a deep subalpine lake: responses to nutrient availability and climatic fluctuation.
Freshwater Biology, 55, (4): 825-846.


DOI: 10.1111/j.1365-2427.2009.02325.x
Salmaso N., Zignin A. (2010).
At the extreme of physical gradients: phytoplankton in highly flushed, large rivers. Hydrobiologia, 639, (1): 21-36.
DOI: 10.1007/s10750-009-0018-0
Salvi S.1., Castelletti S., Tuberosa R. (2009).
An updated consensus map for flowering time QTLS in maize. Maydica, 54, (4): 501-512.
http://www.maiscoltura.it/maydica/articles/54_501.pdf
Savazzini F., Longa Oliveira C.M., Pertot I. (2009). Impact of the biocontrol agent Trichoderma atroviride Sc1 on soil microbial communities of a vineyard in Northern Italy.
Soil Biology and Biochemistry, 41, (7): 1457-1465.
DOI: 10.1016/j.soilbio.2009.03.027
Authors From Roc to Sav
Focus on part_7 CRI Publications Report 09 / 10
Scalabrin S., Troggio M., Moroldo M., Pindo M., Felice N., Coppola G., Prete G., Malacarne G., Marconi R., Faes G., Jurman I., Grando M.S., Jesse T., Segala C., Valle G., Policriti A., Fontana P., Morgante M., Velasco R. (2010).
Physical mapping in highly heterozygous genomes: a physical contig map of the Pinot Noir grapevine cultivar.

BMC Genomics, 11, (204).
http://www.biomedcentral.com/1471-2164/11/204
Scattolin L., Montecchio L. (2009).
Lophodermium piceae and Rhizosphaera kalkhoffii Norway spruce: correlations with host age and climatic features.
Phytopathologia Mediterranea, 48, (2): 226-239.
http://ejour-fup.unifi.it/index.php/pm/article/viewFile/2789/2838
Scheirlinck I., Van der Meulen R., Vrancken G., De Vuyst L., Settanni L., Vandamme P., Huys G. (2009).
Polyphasic taxonomic characterization of Lactobacillus rossiae isolates from Belgian and Italian sourdoughs reveals intraspecific heterogeneity.
Systematic and Applied Microbiology, 32, (2): 151-156.
DOI: 10.1016/j.syapm.2008.12.006
Schellenberg A., Chmielus S., Schlicht C., Camin F., Perini M., Bontempo L., Heinrich K., Kelly S.D., Rossmann A., Thomas F., Jamin E., Horacek M. (2010).
Multielement stable isotope ratios (H, C, N, S) of honey from different European regions.
Food Chemistry, 121, (3): 770-777.

DOI: 10.1016/j.foodchem.2009.12.082
Schuck M.R., Moreira Maia F., Guerra M.P., Voltolini J.A., Grando M.S., Lima da Silva A. (2009).
Molecular characterization of grapevine from Santa Catarina, Brazil, using microsatellite markers.
Pesquisa Agropecuària Brasileira, 44, (5): 487-495.
DOI: 10.1590/S0100-204X2009000500008
Schuck M.R., Moreira Maia F., Voltolini J.A., Guerra M.P., Grando M.S., Lima da Silva A. (2010).
Molecular identification of the grapevine “Goethe” from Urussanga (Sc) with microsatellite markers. Revista Brasileira de Fruticultura, 32, (3): 825-831.
DOI: 10.1590/S0100-29452010005000093
Settanni L., Franciosi E., Cavazza A., Cocconcelli P.S., Poznanski E. (2010). Extension of Tosela cheese shelf-life using non-starter lactic acid bacteria.
Food Microbiology
DOI: 10.1016/j.fm.2010.12.003
Shen Q., Chn Y.A., Tuohy K. (2010).
A comparative in vitro investigation into the effects of cooked meats on the human faecal microbiota.
Anaerobe, 16, (6): 572-577.

DOI: 10.1016/j.anaerobe.2010.09.007
Shulaev V., Sargent D.J., Crowhurst R.N., Mockler T.C., Folkerts O., Delcher A.L., Jaiswal P., Mockaitis K., Liston A., Mane S.P., Burns P., Davis T.M., Slovin J.P., Bassil N., Hellens R.P., Evans C., Harkins T., Kodira C., Desany B., Crasta O.R., Jensen R.V., Allan A.C., Michael T.P., Setubal J.C., Celton J.-M., Rees D.J.G., Williams K.P., Holt S.H., Ruiz Rojas J.J., Chatterjee M., Liu B., Silva H., Meisel L., Adato A., Filichkin S.A., Troggio M., Viola R., Ashman T.L., Wang H., Dharmawardhana P., Elser J., Raja R., Priest H.D., Bryant Jr D.W., Fox S.E., Givan S.A., Wilhelm L.J., Naithani S., Christoffels A., Salama D.Y., Carter J., Lopez Girona E., Zdepski A., Wang W., Kerstetter R.A., Schwab W., Korban S.S., Davik J., Monfort A., Denoyes-Rothan B. , Arus P., Mittler R., Flinn B., Aharoni A., Bennetzen J.L., Salzberg S.L., Dickerman A.W., Velasco R., Borodovsky M., Veilleux R.E., Folta K.M. (2010).
The genome of woodland strawberry (Fragaria vesca).
Nature Genetics

DOI: 10.1038/ng.740
Simone I., Cagnacci F., Provensal C., Polop J. (2010).
Environmental determinants of the small mammal assemblage in an agroecosystem of central Argentina: the role of Calomys musculinus
Mammalian Biology, 75, (6): 496-509.
DOI: 10.1016/j.mambio.2009.12.002
Authors From Sca to Sim Focus : on part_7 CRI Publications Report 09 / 10
108
Sottocornola M., Kiely G. (2010).
Energy fluxes and evaporation mechanism in an Atlantic blanket bog in southwestern Ireland. Water Resources Research, 46, (W11524).
DOI: 10.1029/2010WR009078
Sottocornola M., Kiely G. (2010). Hydro-meteorological controls on the CO2 exchange variation in an Irish blanket bog. Agricultural and Forest Meteorology, 150, (2): 287-297.
DOI: 10.1016/j.agrformet.2009.11.013
Soukoulis C., Aprea E., Biasioli F., Cappellin L., Schuhfried E., Märk T.D., Gasperi F. (2010). Proton transfer reaction time-of-flight mass spectrometry monitoring of the evolution of volatile compounds during lactic acid fermentation of milk. Rapid Communications in Mass Spectrometry, 24, (14): 2127-2134.
DOI: 10.1002/rcm.4617
Stradiotto A., Cagnacci F., Delahay R., Tioli S., Nieder L., Rizzoli A. (2009). Spatial organization of the yellow-necked mouse: effects of density and resource availability. Journal of Mammalogy, 90, (3): 704-714.
DOI: 10.1644/08-MAMM-A-120R1.1
TTagliapietra V., Rosà R., Hauffe H.C., Laakkonen J., Voutilainen L., Vapalahti O., Vaheri A., Henttonen H., Rizzoli A. (2009).
Spatial and temporal dynamics of lymphocytic choriomeningitis virus in wild rodents, Northern Italy. Emerging Infectious Diseases, 15, (7): 1019-1025. http://www.cdc.gov/eid/content/15/7/1019.htm
Tasin M., Bäckman A.C., Anfora G., Carlin S., Ioriatti C. , Witzgall P. (2010).
Attraction of female grapevine moth to common and specific olfactory cues from 2 host plants.

Chemical Senses, 35, (1): 57-64.
DOI: 10.1093/chemse/bjp082
Teuling A.J., Seneviratne S.I., Stöckli R., Reichstein M., Moors E., Ciais P., Luyssaert S., Van del Hurk B., Ammann C., Bernhofer C., Dellwik E., Gianelle D., Gielen B., Grünwald T., Klumpp K., Montagnani L., Moureaux C., Sottocornola M., Wohlfahrt G. (2010).
Contrasting response of European forest and grassland energy exchange to heatwaves.
Nature Geoscience, 3, (10): 722-727.
DOI: 10.1038/NGEO950
Tioli S., Cagnacci F., Stradiotto A., Rizzoli A. (2009).
Edge effect on density estimates of a radiotracked population of yellow-necked mice.
Journal of Wildlife Management, 73, (2): 184-190.
DOI: 10.2193/2007-324
Tolotti M., Boscaini A., Salmaso N. (2010). Comparative analysis of phytoplankton patterns in two modified lakes with contrasting hydrological features.
Aquatic Sciences, 72, (2): 213-226.
DOI: 10.1007/s00027-009-0124-0
Trona F., Anfora G., Baldessari M., Mazzoni V., Casagrande E., Ioriatti C., Angeli G. (2009). Mating disruption of codling moth with a continuous adhesive tape carrying high densities of pheromone dispensers.
Bulletin of Insectology, 62, (1): 7-13.
http://www.bulletinofinsectology.org/pdfarticles/vol62-2009-007-013trona.pdf
Trona F., Anfora G., Bengtsson M., Witzgall P., Ignell R. (2010). Coding and interaction of sex pheromone and plant volatile signals in the antennal lobe of the codling moth Cydia pomonella.
The Journal of Experimental Biology, 213: 4291-4303.

DOI: 10.1242/jeb.047365
Trona F., Casado D., Coracini M., Bengtsson M., Ioriatti C., Witzgall P. (2010). Flight tunnel response of codling moth Cydia pomonella to blends of codlemone, codlemone antagonists and pear ester.
Physiological Entomology, 35, (3): 249-254.
DOI: 10.1111/j.1365-3032.2010.00737.x
Focus on part_7 CRI Publications Report 09 / 10 Authors From Sot to Tro
109
Tränkner C., Lehmann S., Hoenicka H., Hanke M.V., Fladung M., Lenhardt D., Dunemann F., Gau A., Schlangen K., Malnoy M., Flachowsky H. (2010).
Over-expression of an FT-homologous gene of apple induces early flowering in annual and perennial plants.
Planta, 232, (6): 1309-1324.
DOI: 10.1007/s00425-010-1254-2
Urbano F., Cagnacci F., Calenge C., Dettki H., Cameron A., Neteler M. (2010).
Wildlife tracking data management: a new vision.
Philosophical Transactions of the Royal Society B-Biological Sciences, 365, (1550): 2177-2185.
DOI: 10.1098/rstb.2010.0081
Vaccari I., Martinelli L. (2009).
Evaluation of the phosphomannose isomerase-based selection system for gene transfer in grape.
Vitis, 48, (3): 137-144.
http://www.vitis-vea.de/admin/volltext/w1 09 1299.pdf

Velasco R., Zharkikh A., Affourtit J., Dhingra A., Cestaro A. , Kalyanaraman A., Fontana P., Bhatnagar
S.K., Troggio M., Pruss D., Salvi S.1., Pindo M., Baldi P., Castelletti S., Cavaiuolo M., Coppola G., Costa
F., Cova V., Dal Ri A., Goremykin V., Komjanc M., Longhi S., Magnago P., Malacarne G., Malnoy M., Micheletti D., Moretto M., Perazzolli M., Si-Ammour A., Vezzulli S., Zini E., Eldredge G., Fitzgerald
L.M., Gutin N., Lanchbury J., Macalma T., Mitchell J.T., Reid J., Wardell B., Kodira C., Chen Z., Desany
B., Niazi F., Palmer M., Koepke T., Jiwan D., Schaeffer S., Krishnan V., Wu C., Chu V.T., King S.T., Vick
J., Tao Q., Mraz A., Stormo A., Stormo K., Bogden R., Ederle D., Stella A., Vecchietti A., Kater M.M., Masiero S., Lasserre P., Lespinasse Y., Allan A.C., Bus V., Chagne D., Crowhurst R.N., Gleave A.P., Lavezzo E., Fawcett J.A., Proost S., Rouze P., Sterck L., Toppo S., Lazzari B., Hellens R.P., Durel C.E., Gutin A., Bumgarner R.E., Gardiner S.E., Skolnick M., Egholm M., Van de Peer Y., Salamini F., Viola R. (2010).
The genome of the domesticated apple (Malus x domestica Borkh.).
Nature Genetics, 42, (10): 833-839.
DOI: 10.1038/ng.654
Yi C., Ricciuto D., Li R., Wilbeck J., Xu X., Nilsson M., Aires L., Albertson J.D., Ammann C., Altaf Arain M., De Araujo A.C., Aubinet M., Aurela M., Barcza Z., Barr A., Berbigier P., Beringer J., Bernhofer C., Black A.T., Bolstad P.V., Bosveld F.C., Broadmeadow M.S.J., Buchmann N., Burns S.P., Cellier P., Chen J., Chen J., Ciais P., Clement R., Cook B.D., Curtis P.S., Dail D.B., Dellwik E., Delpierre N., Desai A.R., Dore S., Dragoni D., Drake B.G., Dufrene E., Dunn A., Elbers J., Eugster W., Falk M., Feigenwinter C., Flanagan L.B., Foken T., Frank J., Fuhrer J., Gianelle D., Goldstein A.H., Goulden M., Granier A., Grünwald T., Gu L., Guo H., Hammerle A., Han S., Hanan N.P., Haszpra L., Heinesch B., Helfter C., Hendriks D., Hutley L.B., Ibrom A., Jacobs C., Johansson T., Jongen M., Katul G., Kiely G., Klumpp K., Knohl A., Kolb T., Kutsch W.L., Lafleur P., laurila T., Leuning R., Lindroth A., Liu H., Loubet B., Manca G., Marek M., Margolis H.A., Martin T.A., Massman W.J., Matamala R., Matteucci G., McCaughey H., Merbold L., Meyers T., Migliavacca M., Miglietta F., Misson L., Mölder M., Moncrieff J., Monson R.K., Montagnani L., Montes Helu M., Moors E., Moureaux C., Mukelabai M.M., Munger J.W., Myklebust M., Nagy Z., Noormets A., Oechel W., Oren R., Pallardy S.G., U K.T.P., Pereira J.S., Pilegaard K., Pintér K., Pio C., Pita G., Powell T.L., Rambal S., Randerson J.T., Von Randow C., Rebmann C., Rinne J., Rossi F., Roulet N., Ryel R.J., Sagefors J., Saigusa N., Sanz M.J., Scarascia Mugnozza G.T., Schmid H.P., Seufert G., Siqueira M., Soussana J.F., Starr G., Soutton M.A., Tenhunen J., Tuba Z., Tuovinen J.P., Valentini R., Vogel C.S., Wang J., Wang S., Wang W., Welp L.R., Wen X., Wharton S., Wilkinson M., Williams C.A., Wohlfahrt G., Yamamoto S., Yu G., Zampedri R., Zhao B., Zhao X. (2010).
Climate control of terrestrial carbon exchange across biomes and continents.
Environmental Research Letters, 5, (3): art. n. 034007.


DOI: 10.1088/1748-9326/5/3/034007
Yuan W., Liu S., Yu G., Bonnefond J.M., Chen J., Davis K., Desai A.R., Goldstein A.H., Gianelle D., Rossi
F., Suyker A.E., Verma S.B. (2010).
Global estimates of evapotranspiration and gross primary production based on MODIS and global meteorology data.
Remote Sensing of Environment, 114, (7): 1416-1431.

DOI: 10.1016/j.rse.2010.01.022
Zamboni A., Gatto P., Cestaro A., Pilati S., Viola R., Mattivi F., Moser C., Velasco R. (2009).
Grapevine cell early activation of specific responses to DIMEB, a resveratrol elicitor.
BMC Genomics, 10, (363)






DOI: 10.1186/1471-2164-10-363

Focus : on part_7 CRI Publications U
Z Report 09 / 10 Authors From Trä to Zam
V Y
110
Zini E., Clamer M., Passerotti S., Vender C., Vendramin G.G., Komjanc M. (2009). Eight novel microsatellite DNA markers in Rhodiola rosea L. Conservation Genetics, 10, (5): 1397-1399.
DOI: 10.1007/s10592-008-9704-0
Zolezzi G., Bellin A., Bruno M.C., Maiolini B., Siviglia A. (2009). Assessing hydrological alterations at multiple temporal scales: Adige River, Italy. Water Resources Research, 45, (W12421)
DOI: 10.1029/2008WR007266
Zulini L., Fischer C., Bertamini M. (2010). Chlorophyll fluorescence as a tool for evaluation of viability in freeze-stressed grapevine buds. Photosynthetica, 48, (2): 317-319.
http://www.springerlink.com/content/15vjj775406j182u/fulltext.pdf


Monographs and Book Chapters








Bavaresco L., Fregoni C., van Zeller de Macedo Basto Goncalves M.I., Vezzulli S. (2009).
Physiology & molecular biology of grapevine stilbenes: an update.
BIn: Grapevine Molecular Physiology & Biotechnology (editor K.A. Roubelakis - Angelakis). Dordrecht: Springer: 341-364.

http://dx.doi.org/10.1007/978-90-481-2305-6_12
Bertorelle G., Bruford M.W., Hauffe H.C., Rizzoli A., Vernesi C. (editors) (2009).
Population genetics for animal conservation.
Cambridge: Cambridge University Press (Conservation Biology 17): xi, (2): 395 p.

ISBN 978-0-521-68537-5.
Bertorelle G., Papetti C., Hauffe H.C., Boitani L. (2009). Monitoring and detecting translocations using genetic data.
In: Population Genetics for Animal Conservation (editors G. Bertorelle et al.).
Cambridge: Cambridge University Press. (Conservation Biology 17): 148-166.

Authors From Zin to Zul / From Bav to Ber Focus on part_7 CRI Publications Report 09 / 10
111 1
Conterno L., Henick-Kling T. (2010).
Brettanomyces/Dekkera off-flavours and other wine faults associated with microbial spoilage.





In: Managing wine quality (editor A.G. Reynolds).
Woodhead publishing limited: Cambridge. (Woodhead Publishing Series in Food Science, Technology and Nutrition 192): 346-387.
ISBN 978-1-84569-798-3
Costantini L., Moreira Maia F., Zyprian E., Martinez-Zapater J.M., Grando M.S. (2009). Molecular maps, QTL mapping & association mapping in grapevine.
In: Grapevine molecular physiology & biotechnology (editor K.A. Roubelakis - Angelakis).
Dordrecht: Springer: 535-563. http://dx.doi.org/10.1007/978-90-481-2305-6_20
Cristofolini F., Brunialti G., Giordani P., Ferretti M. (editors) (2010). Towards an international standard for lichen monitoring: theory and practice: presentations given at the harmonization field course: 7-11 June 2010.
San Michele allʼAdige (TN): Fondazione Edmund Mach: 95 p.
ISBN 978-88-7843-0320.
Delrot S., Medrano H., Or E., Bavaresco L., Grando M.S. (editors) (2010). Methodologies and results in grapevine research.
Dordrecht: Springer: xvii: 448 p.
ISBN 978-90-481-9282-3.
DOI: 10.1007/978-90-481-9283-0
Frisullo S., Carlucci A., Lops F., Michelon L., Pellegrini C., Pertot I., Quaglia M., Zazzerini A., Serra S., Mannoni M.A., Ligios V., Demontis A. (2010).
Forme di svernamento dei funghi dellʼesca, fonti dellʼinoculo, recettivitá delle ferite.

In: Il mal dellʼesca della vite: interventi di ricerca e sperimentazione per il contenimento della malattia: progetto MesVit. Firenze: Arsia: 104-121.
ISBN 978-88-8295-115-3
Gandolfi A., Ciutti F., Gandolfi G., Nonnis Marzano F. (editors) (2010). Atti del XII congresso nazionale dellʼAssociazione italiana ittiologi acque dolci: 6-7 giugno 2008, San Michele allʼAdige (TN).
Trento: Museo tridentino di scienze naturali (Studi trentini di scienze naturali 87): 276 p.
Giongo L., Grisenti M., Saviane A., Mattivi F., Vrhovsek U., Camin F., Bontempo L., Perini M., Eccher M., Kroll K., Zuin N., Mazzalai M., Mladin P., Danek J. (2010). A berries varieties handbook: phenotyping for the fresh market use.
San Michele allʼAdige (TN): Fondazione Edmund Mach: 351 p.
ISBN 978-88-7843-030-3.
Grando M.S. (2010). Miglioramento genetico.
In: Lʼuva da tavola. Milano: Bayer Cropscience (Coltura & Cultura): 375-385.
ISBN 9788896301098
Grando M.S., Lorenzi S., Moreira Maia F., Vouillamoz J. (2010). Marzemino: quale origine? Una lettura genetica.
In: Tornata Marzemino un nobile trentino: Accademia Italiana della Vite e del Vino. Rovereto (TN): Museo di arte moderna e contemporanea di Trento e Rovereto: 17-22.
Gretter A., Goio I., Gios G. (2010).
Beyond commons: new perspectives and role for common properties.
In: Localeconomiesandglobalcompetitiveness(editors B. Dallago, C. Guglielminetti). Basingstoke: Palgrave Macmillan: 175-189.
ISBN 9780230252721
Gretter A., Marelli B., Orsatti C., Scolozzi R. (2010).

Studiare le interdipendenze tra uomo e ambiente: prospettive multidisciplinari per il caso di studio della valle di Ledro (Trento).
In: Alpi e ricerca: proposte e progetti per i territori alpini (editors F. Corrado, V. Porcellana).
Milano: Angeli (Uomo, Ambiente, Sviluppo): 216-225.
ISBN 9788856835151
Focus : on part_7 CRI Publications C
Report 09 / 10 Authors From Con to Gre
112
H L M
Hauffe H. C., Sbordoni V. (2009). Introduction.
In: Population Genetics for Animal Conservation (editors Bertorelle G., Bruford M. W., Rizzoli A., Hauffe H. C., Vernesi C.). Cambridge University Press: 1-21.
Hofierka J., Mitàsovà H., Neteler M. (2009). Geomorphometry in GRASS GIS.
In: Geomorphometry: concepts, software, applications (editors T. Hengl, I.H. Reuter). Amsterdam: Elsevier. (Developments in soil science 33): 387-410.
http://dx.doi.org/10.1016/S0166-2481(08)00017-2
Longa Oliveira C. M., Savazzini F., Pertot I. (2009). Monitoramento de Trichoderma atroviride SC1 em um vinhedo no nordeste da Italia: consideraçoes sobre impacto ambiental e controle biologico de Armillaria mellea, p. 173-186.
In: Biocontrole de Doenças de Plantas: Uso e Perspectivas (editors Bettiol W., Morandi, M.A.B.). Embrapa Meio Ambiente, Sao Paulo, Brasil: 341p.
Malnoy M., Aldwinckle H.S. (2009). Apple transformation and translational genomics.

In: Genetics and genomics of Rosaceae (editors K.M. Folta, S.E. Gardiner). New York, NY: Springer: 143-162.
http://dx.doi.org/10.1007/978-0-387-77491-6_7
Marchetto A., Rogora M., Boggero A., Musazzi S., Lami A., Lotter A., Tolotti M., Thies H., Psenner R., Massaferro J., Barbieri A. (2009).
Response of Alpine lakes to major environmental gradients, as detected through planktonic, benthic and sedimentary assemblages.
In: Patterns and factors of biota distribution in remote european mountain lakes (editors J. Catalan, C.J. Curtis, M. Kernan). Stuttgart: Schweizerbartʼsche Verlagsbuchhandlung. (Advances in Limnology 62): 419-440.
Marchi G., Burruano S., Di Marco S., Osti F., Pertot I., Surico G. (2010).
Analisi statistica della distribuzione spaziale del mal dellʻesca della vite in alcuni vigneti spaziali.
In: Il mal dellʻesca della vite : interventi di ricerca e sperimentazione per il contenimento della malattia: progetto MesVit. Firenze: Arsia: 191-203.
ISBN 978-88-8295-115-3
Martinelli L. (2010).
Recombinant DNA.



In: Encyclopedia of science and technology communication (editors S. Hornig Priest). Los Angeles: SAGE. 2: 623-626.
ISBN 978-1-4129-5920-9.
Martinelli L., Gribaudo I. (2009).
Strategies for effective somatic embryogenesis in grapevine: an appraisal.


In: Grapevine molecular physiology & biotechnology (editor K.A. Roubelakis - Angelakis). Dordrecht: Springer: 461-493.
http://dx.doi.org/10.1007/978-90-481-2305-6_17
Michelon L., Pellegrini C., Pertot I. (2010). Il mal dellʼesca della vite in Trentino.
In: Il mal dellʼesca della vite : interventi di ricerca e sperimentazione per il contenimento della malattia: progetto MesVit. Firenze: Arsia: 182-183.
NISBN 978-88-8295-115-3
Neteler M. (2010).
Open source Geospatial Foundation.
In: The Encyclopedia of geography (editor B. Warf). London: SAGE Publications. 4: 2088-2089.
ISBN 9781412956970
Neteler M. (2010).
Open source GIS.
In: The Encyclopedia of geography (editor B. Warf). London: SAGE Publications. 4: 2090-2091.
ISBN 9781412956970
Authors From Hau to Net Focus on part_7 CRI Publications Report 09 / 10
113
Markus Neteler and Helena Mitasova (Translated by Tetsuji Uemura), (2009)
Open Source GIS: A GRASS GIS Approach.






Third Edition ‒ Japanese Version: 467.
ISBN-10: 4759101276, ISBN-13: 978-4759101270





Pertot I. (2009).
Principi attivi antiperonosporici.
In: Peronospora della vite (editor P. Balsari). Calosso (AT): Edizioni Vit.En.: 76-79.
Rodeghiero M., Heinemeyer A., Schrumpf M., Bellamy P. (2009).
Determination of soil carbon stocks and changes.
In: Soilcarbondynamics:anintegratedmethodology (editors W. Kutsch, M. Bahn, A. Heinemeyer). Oxford: Cambridge University Press: 49-75.
Salmaso N., Tolotti M. (2009).
Other phytoflagellates and groups of lesser importance.
In: Encyclopedia of inland waters (editor G.E. Likens). Oxford: Elsevier 1: 174-183.

SScienza A., Mariani L., Failla O., Brancadoro L., Toninato L., Cricco J., Bacchiega D., Zappata A., Monterisi L., Marangon A., Dalla Rosa A., Garlato A., Sartori G. , Porro D., Penner F., Larcher R., Nicolini G.G.F., Mattivi F. (2010).
La zonazione della DOC Terradeiforti: manuale dʼuso del territorio.
Legnaro (PD): Veneto Agricoltura: 151 p.
ISBN 978-88-6337-046-1.
Sosinski B., Shulaev V., Dhingra A., Kalyanaraman A., Bumgarner R., Rokhsar D., Verde I., Velasco R., Abbott A.G. (2009).
Rosaceous genome sequencing: perspectives and progress.
In: Genetics and genomics of Rosaceae (editors K.M. Folta, S.E. Gardiner). New York, NY: Springer: 601-615.
Stefanini M., Tomasi T. (2010).
Antichi vitigni del Trentino.
San Michele allʼAdige (TN): Fondazione Edmund Mach: 271 p.
ISBN 978-88-7843-032-7.
Straškràbovà V., Bertoni R., Blažo M., Callieri C., Forsström L., Fott J., Kernan M., Macek M., Stuchlik E., Tolotti M. (2009).
Structure of pelagic microbial assemblages in european mountain lakes during ice-free season.
In: Patterns and factors of biota distribution in remote european mountain lakes (editors J. Catalan, C.J. Curtis, M. Kernan). Stuttgart: Schweizerbartʼsche Verlagsbuchhandlung (Advances in Limnology 62): 19-53.
Tolotti M., Forsström L., Morabito G., Thaler B., Stoyneva M., Cantonati M., Šiško M., Lotter A. (2009). Biogeographical characterisation of phytoplankton assemblages in high altitude and high latitude European lakes.
In: Patterns and factors of biota distribution in remote european mountain lakes (editors J. Catalan, C.J. Curtis, M. Kernan). Stuttgart: Schweizerbartʼsche Verlagsbuchhandlung. (Advances in Limnology 62): 55-75.
Vernesi C., Bruford M.W. (2009).
Recent developments in molecular tools for conservation.
In: Population genetics for animal conservation (editors G. Bertorelle et al.). Cambridge: Cambridge University Press. (Conservation Biology 17): 321-344.
Focus : on part_7 CRI Publications
Report 09 / 10 Authors From Mar to Ver
114















Focus on part_7 CRI Publications Report 09 / 10 115
Organization chart
RESEARCH AND INNOVATION CENTRE
Viola Roberto
director of the RESEARCH AND INNOVATION CENTRE secretary
administrative director
Esposito Elisabetta
Maffei Roberto
Administration and Research support
ADMINISTRATION / Agostini Romina | Barbacovi Daniele | Chini Sabrina | Conter Luigii| Lona Silvana | Losa Annalisa | Marin Floriana | Paternoster Genny | Tait Laura | Tonazzolli Giorgio | Trapin Eleonora
SUPPORT / Boccardi Francesco | Cappelletti Emiliano | Coser Paola | Facchinelli Michela Greco Giulio | Maffei Stefano | Pedrotti Sonia | Turrina Loredana
ADMINISTRATION / Bacca Manuela | Caset Marisa | Chincarini
Roberto | Gramazio Tiziana | Pedrotti Alice | Pezzè Luca | Saracino
Fiorella | Sebastiani Daniele
GMPF Phd Programme
SUPPORT / Cossa Alberto Elisabeth Agostinho
Salamini Francesco / Director of GMPF Internationa Programmme (untill september 30th 2009)
Viola Roberto / Director of GMPF Internationa Programmme (from 1st october 2009)
GMPF SECRETARY / Piaia Elisa | Perini Elisabetta | Wehrens-Kunne Odilia | Zecca Daniela
Enviroment and Natural Resources Area
Rizzoli Annapaola / Head of Environment and Natural Resources Area and Climate Change Impact and Adaptation Program
→ Salmaso Nico / Head of Biocomplexity and Ecosystem Dynamics Program
→ Varotto Claudio / Head of Biodiversity and Molecular Ecology Program
→ Neteler Markus / Head of Gis and Remote Sensing Technology Platform
→ Eccel Emanuele / Head of Climate Modelling Technology Platform
RESEARCHERS / Cagnacci Francesca | Cerasino Leonardo | Cristofolini Fabiana | Flaim Giovanna | Gandolfi Andrea | Gianelle Damiano | Gottardini Elena | Hauffe Heidi | La Porta Nicola | Marcolla Barbara | Obertegger Ulrike | Pecchioli Elena | Rodeghiero Mirco | Rosà Roberto | Tolotti Monica | Zorer Roberto
TECHNOLOGISTS / Boscaini Adriano | Frizzera Lorenzo | Rosso Fausta | Tagliapietra Valentina | Tonolli Sergio
TECHNICIANS / Cavagna Mauro | Girardi Matteo | Leonardi Gino | Pinamonti Vigilio | Ress Lorena | Sansoni Claudio | Tarter Milva | Tomasi Mirco | Viola Maria Cristina | Zampedri Roberto | Zampedri Andrea
RESEARCHERS / Bruno Maria Cristina | Maiolini Bruno | Vernesi Cristiano | Vescovo Loris
CONTRACT RESEARCHERS / Bolzoni Luca | Carolli Mauro | Carpi Giovanna | Cau Piero | Cordano Emanuele | Crestanello Barbara | DʼAlelio Domenico | Dalponte Michele | Detassis Carlo | Delucchi Luca | Fior Simone | Gazzani Silvia | Gratton Paolo | Konecny Adam | Li Mingai | Marelli Beatrice | Martinez Cristina | Meraner Andreas | Ometto Lino | Orsatti Cristina | Rocchini Duccio | Roiz David | Scalfi Marta | Scolozzi Rocco | Silveri Luana |
Sottocornola Matteo
TECHNOLOGISTS / Barbaro Enrico | Cristofori Antonella | Gretter Alessandro
TECHNICIANS / Arnoldi Daniele | Bertoldi Alessio | Castellani Cristina | Cornetti Luca | Merlo Nicola | Predelli Mattia | Ronchetti Jessica | Varolo Elisa | Zeni Simone
FELLOW / Gori Yuri PHD
Focus : on part_8 Organization chart
STUDENTS / Centis Barbara | Di Pierro Erica Adele | Ghisla Anne | Lega Margherita | Milan Manuela | Ossi Federico | Pedron Luca | Ranjan
/ Collini Margherita | De Sabbata Giorgia | Manica Mattia | Marchesini Alexis | Mezzini Elena | Michelini Samanta | Mosca Elena
Jayant | Zignin Andrea INTERNSHIPS
permanent staff contract staff
permanent staff contract staff
Report 09 / 10 116
Transversal computationalplatformbiology
technology platform
permanent staff
RESEARCHERS / Cestaro Alessandro | Fontana Paolo
RESEARCHERS / Bianco Luca | Goremykin Vadim | Scholz Matthias Uwe | Wehrens Herman Ronald Maria Johan
TECHNOLOGISTS / Cattani Andrea | Frizzi Andrea
TECHNICIANS / Moretto Marco
PHD STUDENTS / Dong Yonghui | Potenza Emilio | Shahaf Nir | Shivani Shivani
Genomics and Crop Biology Area
Velasco Riccardo / Head of Genomics and Crop Biology Area and Structural and Functional Genomics Program
→ Grando Maria Stella / Head of Applied Molecular Genetics Program
→ Pertot Ilaria / Head of Interactions between Plant and Environment Program
→ Martinelli Lucia / Head of Functional Genomic Platform
→ Stefanini Marco / Head of Germplasm Preservation and Pre-breeding Collection Technology Platform
→ Pindo Massimo / Head of Sequencing and Genotyping Technology Platform
RESEARCHERS / Baldi Paolo | Ciccotti Anna Maria | Komjanc Matteo | Malnoy Mickael | Moser Claudio | Perazzolli Michele | Si Ammour Azeddine | Troggio Michela | Vezzulli Silvia | Zulini Luca
TECHNOLOGISTS / Giongo Lara | Magnago Pierluigi
TECHNICIANS / Dallaserra Monica | Dorigatti Cinzia | Fontanari Marco | Poletti Valentino | Prada Germano | Tomasi Tiziano | Zatelli Alessandra
SUPPORT / Battocletti Ivana | Bertolini Emanuele | Deromedi Marco | Lona Emma | Rossi Carlo
RESEARCHERS / Anfora Gianfranco | Battilana Juri | Campisano Andrea | Costantini Laura | Dagostin Silvia | Longa Claudia Maria | Mazzoni Valerio | Palmieri Luisa | Pilati Stefania | Zini Elena
CONTRACT RESEARCHERS / Asquini Elisa | Bengtsong Martin Jonas | Caffarra Amelia | Costa Fabrizio | Cova Valentina | De Paoli Emanuele Giacomelli Lisa | Maene Marion | Malacarne Giulia | Maurhofer Monika | Palmieri Maria Cristina | Salvi Silvio |
Tasin Marco | Todesco Sara | Tosi Lorenzo | Trona Federica | Vincenot Lucie
TECHNOLOGISTS / Bisognin Claudia | Coppola Giuseppina | Dalla Costa Lorenza | Decarli Elisa | Maia Moreira Flavia | Martinatti Paolo
TECHNICIANS / Bozza Elisa | Chini Isaac | Filippi Raffaele | Grisenti Marcella | Larger Simone | Leonardelli Elisabetta | Mandolini
Marco | Micheli Susanna | Nicolini Daniela | Pancher Michael | Pellegrini Alberto | Pellegrini Chiara | Piazza Stefano | Sicher
Carmela | Sordo Maddalena | Stefani Erica | Zambanini Jessica
SUPPORT / Clementi Silvano | Dagostin Silvia | Giovannini Oscar | Leoni Veronica | Ress Denise | Valentini Franca
PHD STUDENTS / Angeli Dario | Castelletti Sara | Cavaiuolo Marina | Coller Emanuela | Corneo Paola Elisa | Dal Ri Antonio |
Granato Laura | Emanuelli Francesco | Eriksson Anna | Lashbrooke Justin | Leonardelli Lorena | Longhi Sara | Micheletti Diego
| Miolli Giulia Valentina | Nikiforova Svetlana | Paternoster Thomas | Righetti Laura | Rigosi Elisa | Rinaldi Monica Fernanda | Roatti Benedetta | Wolters Pieter Jacobus
INTERNSHIPS / Bailoni Massimo | Baldo Giordana | Beozzo Marco | Biasi Antonio | Brazzale Daniele | Casagranda Nicola | Cavalli Diego | Cestari Giacomo | Cont Massimiliano | Dapraʼ Federica | De Mattia Fabrizio | Domingues Garcia M. Del Carmen
| Ezzahi Bahcine | Gatto Pamela | Geir K. Knudsen | Giovannini Oscar | Guidon Renato | Hoyny Fabian | Kusstatscher Natashia
| Ibarra Lucia | Lasserre Pauline | Maccari Jenny | Maiellaro Isabella | Maistri Simone | Mraihi Mohamed | Pardatscher Franz
| Pedron Renato | Pedrotti Moreno | Perenzoni Andrea | Pinelli Luca | Roccaforte Vincenzo | Storari Michelangelo | Telch
Samuel | Vesentini Damiano | Zanotti Tania.
Focus on part_8 Organization chart
permanent staff contract staff
contract
Report 09 / 10 117
staff
Food Quality and Nutrition Area
Mattivi Fulvio / Head of Food Quality and Nutrition Area
→ Cavazza Agostino / Head of Innovative Food Technology Program
→ Gasperi Flavia / Head of Sensory Quality and Customer Choise
→ Vrhovsek Urska / Head of Metabolic Profiling Technology Platform
→ Camin Federica / Head of Isotopic Analysis Technology Platform
RESEARCHERS / Aprea Eugenio | Biasioli Franco | Bontempo Luana | Poznanski Elisa
TECHNICIANS / Carlin Silvia | Masuero Domenico | Sanchez Cova Carla | Simoni Marco
Tonon Agostino | Ziller Luca
SUPPORT / Calovi Stefano
RESEARCHERS / Martens Stefan | Palmieri Luisa | Theodoridis Georgios | Tuohy Kieran
CONTRACT RESEARCHERS / Barros do Carvalho Elisabete | Caputi Lorenzo | Conterno Lorenza | Demattè Maria Luisa | Franceschi Pietro | Gkika Eleni | Panagiotis Arapitsas | Soukoulis Christos
TECHNOLOGISTS / Endrizzi Isabella | Mattevi Monica | Van Leeuwen Katryna
TECHNICIANS / Angeli Andrea | Betta Emanuela | Fabris Alessandra | Monfredini Luca | Pellegrini Daniele | Perzolli Stefano | Perenzoni Daniele | Petri Nora
PHD STUDENTS / Cappellin Luca | Corollaro Maria Laura | Fortes Gris Eliana | Ferreira Eduardo Antonio | Franciosi Elena | Gasperotti Mattia | Hernandez-Jimenez Alberto
INTERNSHIPS / Andreatta Elena | Anesin Giulia | Bottarel Andrea | Budic-Leto Irena | Cariolato Diego | Casiello Grazia | Corda Antonella | DʼUrso Maria Giuseppina | Ferrigno Antonella | Filippi
Alessandro | Locci Stefano | Longobardi Francesco | Oliosi Luca | Pavana Silvia | Scartezzini Verena | Schuhfried Erna | Simeoni Federico | Steiner Bettina | Vanzo Andreja
permanent staff contract staff Focus : on part_8 Organization chart Report 09 / 10
Male 52% [128] Female 48% [118]
Staff data
Permanent position 38% [93]
Temporary position 62% [153]
Italian 85% [208] Foreign 15% [38]
Holding a PhD 40% [97]
From 23 different countries
Less than 30 years old 25% [63] 30 - 40 years old 47% [116] 41 - 50 years old 21% [51] Over 50 years old 7% [18] Report 09 / 10
119 Focus on part_8 Organization chart
REPORT 2009 / 2010 Research and Innovation Centre
Fondazione Edmund Mach
© 2011 Fondazione Edmund Mach, Via E. Mach 1, 38010 San Michele allʼAdige (TN) - Italy
Reproduction of this material is forbidden without the written permission of the CRI board
Report Editors
Floriana Marin | Alessandro Gretter | Cristina Castellani
Editorial board
Roberto Viola | Riccardo Velasco | Fulvio Mattivi | Annapaola Rizzoli | Ilaria Pertot | Heidi C. Hauffe
Translation
Tessa Say | Heidi C. Hauffe
Graphic Design
Kinè s.c.s [M. Maroni | L. Stanga | support: E. Vinciguerra]
Photography
Massimo Brega - The Lighthouse (except for p. 66-67 © FLPA/The Lighthouse )
Cover
Cranach Lucas il Vecchio (1472-1553): Adamo ed Eva in Paradiso, 1533. Berlino, Gemaeldegalerie, Staatliche Museen zu Berlin.
Olio su tavola di faggio, 51.3 x 35.5 cm. Inv. 566.
Foto: Joerg P. Anders.© 2011. Foto Scala, Firenze/BPK, Bildagentur fuer Kunst, Kultur und Geschichte, Berlin
Printing
Litotipografia Alcione ISSN
Printed in April 2011
1972-6082
Fondazione Edmund Mach | Research and Innovation Centre Via E. Mach, 1 | 38010, S. Michele allʼAdige (TN) Italy | P. +39 0461615145 | F. +39 0461 650956 www.fmach.eu | cri.fmach.eu




 Centre
Centre

[Rocco Scolozzi]
[Rocco Scolozzi]

























































































































































































































